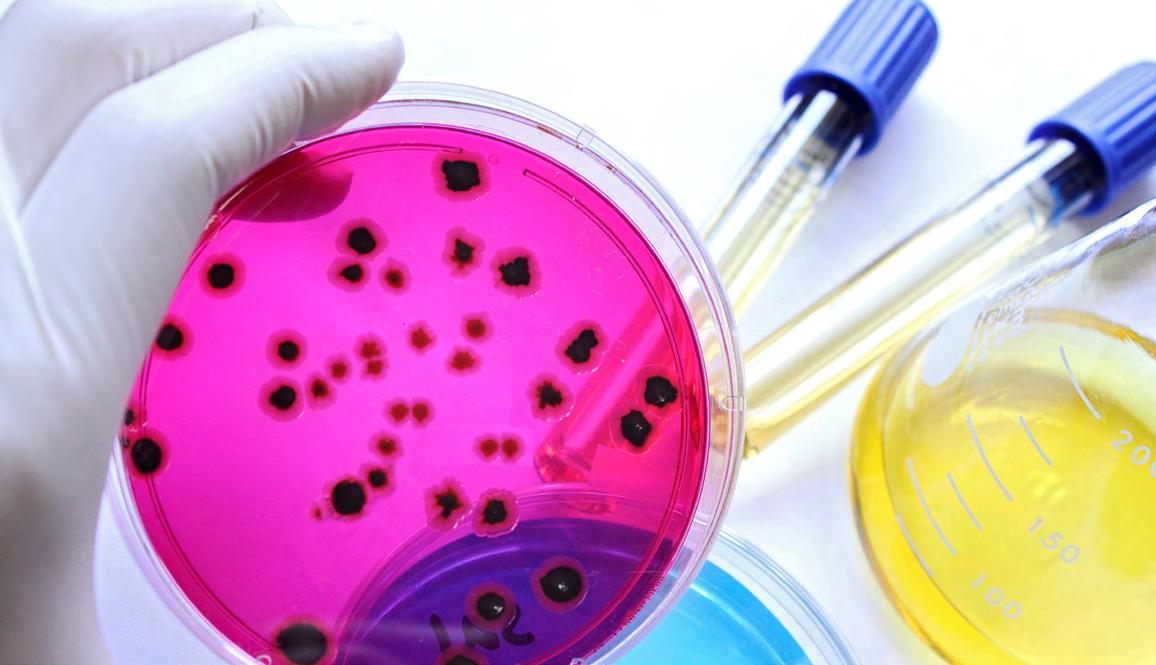
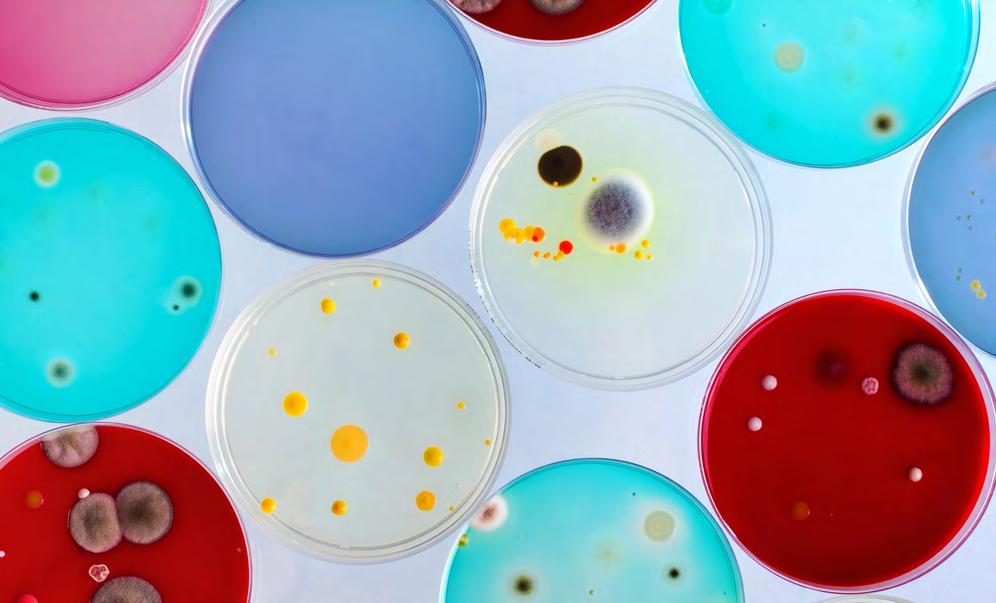
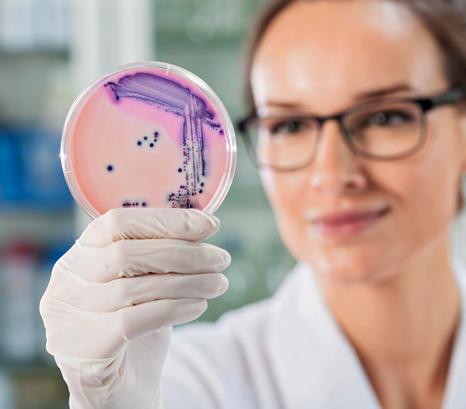

![]()



Permanent changes have emerged following the COVID-19 pandemic. The health industry has left behind traditional care models that were functional for years and is looking ahead to a new era of digitalization, patient centricity and a focus on health, rather than disease.
This transformation has called for the collaboration of Mexico’s public and private sectors. All industry stakeholders have united their strengths, boosting their capabilities, reach and quality to the benefit of the country’s large population. These operational shifts have demanded technology implementations at all levels of the production and distribution chain. As the digital transformation moves forward, readiness will define providers’ competitiveness in a new health market.
The sector also understands the value of innovation and investment in R&D, areas that Mexico is keen to explore and where it has great development potential. The pandemic also evidenced how poor health financing models can lead families into poverty. Mexico’s long-time health financing struggle were also in the spotlight as novel insurance models emerged. Efforts in this area are also complemented by the initiatives of large players in the medical devices and pharmaceutical industries that are moving toward value-based models to support health systems and patients.
Mexico Health Review 2021 will explore these and other emerging trends that the industry could explore to achieve sustainability and efficiency while moving toward a model based on prevention that aims for sustained health instead of focusing on curing diseases that could be prevented or better managed with the right care. This edition of Mexico Health Review outlines the opportunities, learning curves and excitement for the future of Mexico’s care providers, providing the latest insights directly from the people shaping the industry.

After almost two revolutionary years for the sector, providers continue to demonstrate their strength. The stage has been set, with the health system moving toward a patient-centric approach, supported by technology, a preventive healthcare culture and patient empowerment.
As healthcare becomes a national priority, universal access is key to offer comprehensive health services to all people and communities regardless of their financial capabilities. To achieve this, the sector has established close collaboration between different providers, which has boosted the impact of measures to face the ongoing COVID-19 pandemic, opening the door for collaboration to address the sector’s longstanding burdens, such as financial barriers and lack of infrastructure and personnel.
The government’s vaccination program and public health coverage through INSABI continue to move forward. While there are still gaps to be addressed, efforts from both the public and private sectors point to a solution.
Mexico’s health industry is and will continue to be an economic pillar for the country. To achieve the industry’s full potential, providers agree on the importance of digitalization throughout the entire supply chain, from manufacturing and development processes to direct contact with patients. Key stakeholders say this has and will reshape the way health is developed and delivered.

Mexico’s midterm elections held on June 6 revealed strong opposition against President López Obrador’s current mandate. Over 52 percent of voters elected a more balanced Lower House in Mexico’s Congress. Although MORENA maintained a majority of seats in the lower chamber, it lost its absolute majority. Businesses mostly welcomed the result as some decisions by the president have radically changed the operations of many companies.
Since the beginning of Lopez Obrador’s mandate, the pharmaceutical industry has dealt with a plethora of changes related to public medicine acquisition processes, leading to a modification of the Public Sector Acquisitions, Leasing and Services Law (LAASSP) that excluded medicines and health supplies from public bids. Medicine supply is now handled between INSABI and UNOPS for 2021. The consequences of this modification were critical for Mexico’s health system. “Ever since then, the system has suffered medicine and resource shortages,” says Karel Fucikovsky, Director of Medical Care Mexico for Pierre Fabre Farma. The retail market will continue to be driven by the increased penetration of generics and out-of-pocket expenditure by patients and consumers. Fucikovsky expects the election results will speed up processes for the authorities to comply with the rulings and results of the national tender supported by UNOPS.
Greater confidence is also expected after the results of the election, which could boost industry development, according to Fernando Becerril, Senior Partner at Becerril, Coca & Becerril. Diversity in Congress is expected to generate business development in the country while also attracting foreign investment. “The coming months promise to be more encouraging than what was perceived before the election,” says Becerril. Investment is a subject with which many companies in the sector have struggled. This has been mainly driven by the modifications to LASSP but also by the general uncertainty created by Mexico’s regulatory agency COFEPRIS that has already gone through to two changes in commissioner, was absorbed by the Ministry of Health and has reduced the number of authorized third-party collaborators.
In some cases, however, the elections had a limited impact on healthcare practices. In 2020, MORENA pushed through Congress the General Law for the Regulation of Cannabis, which seeks to legalize marijuana for recreational, scientific, medical and industrial uses, creating the world’s largest cannabis market in a country plagued by drug cartel violence. The Senate has yet to approve the legislation passed by Chamber of Deputies earlier this year. Meanwhile, the Supreme Court declared that it will erase all laws referring to cannabis, leaving the plant in a legal void. However, the recent appointment of Olga Sánchez Cordero, former Minister of the Interior, as President of the Senate, is seen as a positive sign for the industry, says Erick Ponce, President of the Mexican Cannabis Industry Promotion Group (GPIC). “We welcome the return of the senator to the new legislature. We know that she will continue to promote her initiative from her seat. We believe that Mexico will have good news before the end of October in this regard,” says Ponce.

Dr.
Manuel Cervantes Ocampo Coordinator of First Level Medical Units at IMSS
Mexico’s Constitution enshrines access to healthcare services for all citizens but providing these services has been a consistent challenge for all players in the sector. For its part, the Mexican Social Security Institute (IMSS) is prioritizing the provision of universal access, says Manuel Cervantes Ocampo, Coordinator of First Level Medical Units at IMSS.
According to Mexico’s National Development Plan (PND) 20192024, introduced by President López Obrador’s administration, “there are millions of people who do not have access to any institution or modality of the health system or who live in conditions without access to coverage.” The national priority, says Cervantes Ocampo, is to provide access to comprehensive medical services to all people and communities without distinction, regardless of their financial capabilities and with a particular focus on marginalized groups. To increase access, the sector requires appropriate and competent healthcare personnel, proximity services in communities “where people study, work or live,” equitable distribution of resources and financial support, says Cervantes Ocampo. The PND 2019-2024 tackles access through the Health for the Whole Population plan, which aims to reduce the number of people who do not have access to health services.
While previous administrations had introduced other initiatives to increase access, such as the now defunct Seguro Popular that was absorbed by INSABI, these plans failed to include conditions such as kidney failure or some types of cancer in its coverage, says Cervantes Ocampo. The main objective of the current PND is to provide access to effective, universal and free healthcare services. “The best example we have is the COVID-19 vaccine,” Cervantes Ocampo says. “We have guaranteed that people who are not affiliated to social security institutions have access to medical and hospital care, including medicines, healing materials and medical examinations.”
During the current administration, IMSS has prioritized its contribution to universal and free access to health services and medicines for the entire population, says Cervantes Ocampo. Likewise, the institute seeks to guarantee the quality and coverage of institutional services and benefits, “giving priority to disease prevention and health promotion.” Some services are now being provided as part of the IMSS Bienestar program, which is free for all Mexicans and prioritizes marginalized populations. The program operates in 19 states and provides health services to 11.6 million people in the country. One of the initiatives within this scheme involves providing health services to domestic workers, a sector that “not so long ago was left unprotected,” highlights Cervantes Ocampo. These workers and their dependents can now become beneficiaries of IMSS, which gives them access to medical attention and a retirement pension.

To guarantee access to health, IMSS is improving the quality of its services including the prevention of diseases and illnesses like overweight, diabetes, hypertension, breast, cervical and prostate cancer and HIV, as well as hepatitis C screening. The institute, said Cervantes Ocampo, plans to achieve these goals by expanding the institutional coverage of its services by targeting the most disadvantaged groups, promoting healthier lifestyles and encouraging the adoption of a holistic health model. “Access to health does not only refer to medical care in a doctor’s clinic or hospital but also includes disease prevention services.”

Martha Delgado
Q: Your department is leading the diplomatic fight against the pandemic. What were the initial steps to create a diplomatic and health strategy?
A: In mid-2020, the Ministry of Multilateral Affairs and Human Rights (MoFA) used its diplomatic channels to analyze the progress of therapeutics and medical devices around the world to introduce them early into the country and give priority access to the Mexican population. An air bridge was also established to facilitate the arrival of those urgent supplies and other donations.
Q: How do local authorities determine the final destination of donated material?
A: Mexico’s health authority developed the strategy that determined which supplies remained in the country and which could be donated to other countries. MoFA assisted them by facilitating their transfer to chosen nations. Local authorities also identified the specific needs of health institutions to expedite the acquisition or donation of medical supplies. We collaborated with Mexico’s health authority to accelerate regulatory processes.
Q: Your department has worked to improve COFEPRIS’s international standing. How does this benefit Mexicans?
A: To ensure the quality, safety and efficacy of health supplies it is essential to have a regulatory agency of the highest quality that is recognized worldwide. A health authority that is recognized for its strength and regulatory maturity ensures that the supplies used during the pandemic are efficacious, safe, highquality and meet the needs of the population.
Q: How will Mexico’s actions contribute to global vaccination and how will they influence other countries to follow the example?
A: Mexico has led the call for equity in vaccination not only in the region but in the world. The country has made this request at the highest-level forums, including at the UN meeting last year. These efforts have achieved the mobilization of supplies and vaccines to the nations that need them most and they have been replicated by multiple countries.
During the Community of Latin American and Caribbean States (CELAC), we introduced initiatives to strengthen the production and commercialization of health supplies using the capabilities of the region’s pharmaceutical industry and the regulatory strength achieved by some members.
Q: How has MoFA contributed to the development of Mexico’s COVID-19 vaccine Patria?
A: A multidisciplinary group has evaluated each of the vaccines being developed in Mexico and in accordance with their progress they have been supported through various mechanisms.
The Patria vaccine is one of the projects that can be financed by CEPI. Since the beginning of the pandemic, this project has been monitored in coordination with COFEPRIS to ensure it complies with each development stage until it is authorized for emergency use.
Cristóbal Thompson

Executive Director of AMIIF
Q: As a representative of the innovation industry, what are the non-COVID-19 epidemiological trends the sector is trying to address?
A: COVID-19 has been critical but we have neither forgotten nor left behind innovation in other fields. Mexico’s largest health challenge is non-transmissible diseases, which cause 80 percent of deaths in the country. This population was significantly more vulnerable to the pandemic. The innovative industry is developing gene therapies and personalized medicines to address numerous diseases. Many of our members are also endorsing regulations that would allow these two types of therapies to be introduced into the country.
Companies are also innovating on antimicrobial resistance (AMR). About 700,000 people die annually from AMR and it is estimated that if no innovations are made, over 10 million people could die from AMR by 2050. The industry is taking action internally but we are also approaching COFEPRIS and the General Health Council to build a joint response. Through the International Federation of Pharmaceutical Manufacturers and Associations (IFPMA), many pharmaceutical companies have provided millions of dollars to develop new treatments. Regardless of the company or country, anyone can join in the fight against AMR.
Q: How could Mexico enhance its investment in R&D and how would this impact its economic development?
A: Two years ago, global investment in innovation amounted to US$170 billion. This number has probably risen, considering the significant investment in R&D and infrastructure to fight COVID-19.
Mexico annually invests about US$250 million on innovation, which is significantly below global figures. We rank 29th in clinical research but we can improve by accelerating approval processes and making the market more competitive to increase investment in innovation. Early investment can greatly impact the development of therapies, making them more beneficial to patients.
Clinical research generates 4.4 direct jobs and every MX$1 (US$0.05) generates an economic impact of MX$1.64 (US$0.08). This dynamic sector is seeing the most investment globally. It would be strategic for Mexico to invest in the life sciences sector for its economic growth.
Q: How are AMIIF and its members developing pathways that accelerate access to innovation?
A: Through the ACCESS study, we analyzed the timeline and speed of introducing innovation to the Mexican market, which is about 4.3 years on average and has not improved in recent years. We approached COFEPRIS to speed up the process, which we expect will accelerate with new Commissioner Alejandro Svarch. The organization has taken significant steps to reactivate the New Molecules Committee, which has started operating efficiently, successfully reviewing 99 drugs. However, there is a long way to go. AMIIF’s members have 20 drug registries waiting for COFEPRIS’ approval even though they have been greenlighted by the Committee and by other international agencies, such as the FDA or EMA.

Rafael Gual
Director General of the National Chamber of the Pharmaceutical Industry (CANIFARMA)
The results of the changes to the scheme for the procurement of medicines and health supplies in June 2019 under the charge of the Administrative Office of the Ministry of Finance and Public Credit (SHCP), and replicated later in December for the supply of 2020, left much to be desired. A serious lack of planning and knowledge about the operation and requirements to manufacture pharmaceuticals and medical devices were the main causes of these poor results, reflected in 62 percent unquoted pharmaceutical items in the June 2019 bid and 30 percent in December.
The procurement of medicines and medical devices was marked by a large proportion of direct adjudication, as much as 82 percent of the acquisitions, a figure that exceeds by far the less than 7 percent average of recent years. In light of this situation and the failure of the last two bids, the legal framework underwent significant modifications, the most important being the amendment to Article 1 of the Law of Acquisitions, Leases and Services of the Public Sector (LAASSP), which exempts the procurement of medicines from the bidding process.
Besides, modifications were also made to allow purchases through intergovernmental international organizations. The regulatory framework was reformed to recognize the equivalence of sanitary registrations awarded by foreign agencies, as well as to grant a sanitary registration to any foreign therapeutic product as long as it has such registration in its country of origin. These modifications were aimed at promoting the participation of UNOPS in the acquisition processes. By mid-2020, a cooperation agreement was signed between UNOPS and the Ministry of Foreign Affairs (SRE) and shortly thereafter, a contract was signed between the Institute of Health for Wellbeing (INSABI) and UNOPS for the procurement of health supplies for 2021.
These agreements with UNOPS were heralded as the ideal mechanism to guarantee the supply of medicines for Mexico and transparency in the fight against corruption. The results today leave much to be desired indeed. There is a dire shortage of medicines and medical devices.
It is evident that the process lacks adequate planning and transparency, since even though it formally began in August 2020 with the signing of the agreement, it was not until December that the first bid for patented, single-source products and critical supply products for the first months of 2021 was carried out. The first adjudications for these 381 pharmaceutical items were awarded in February, and the first contracts were signed in March, with some still pending.
On May 25, after more than three months, UNOPS sent individual communications to the companies to inform them of their assignments. However, these notification letters stated that the information was not legally binding, so they should not start any manufacturing process until there was a contract between the parties. More than four months after the submission of bids, UNOPS had not yet issued a decision. In June, UNOPS sent a communication to INSABI informing that 653 items were not quoted and, therefore, it was unable to acquire them, which represents 55 percent of the total to be procured, a result that is similarly deficient to that obtained by the Administrative Office of SHCP.

Rafael Maciel
Medical Director of Apotex / President of AMEGI
Q: How did the pandemic impact the use of generics in Mexico?
A: In the public sector, generics uses decreased by 22 percent in units and by 8.5 percent in value as a result of new medicine contracting processes, which caused many implementation challenges and led to medicine shortages. The decrease was mostly seen at IMSS, which was missing 30 percent of the units it required. The shortages drove patients to seek medications in the private market. The majority of the missing drugs were for cancer or other high impact diseases.
During this period, the demand for ivermectin, azithromycin and paracetamol skyrocketed. Paracetamol has been among the most in-demand drugs during the pandemic. Demand for medicines to treat COVID-19 symptoms grew by 66.9 percent, while molecules for non-COVID-19 diseases grew by 2.9 percent.
The market for generics grew 8.6 percent year-over-year in 2020, which represents an extra 94.6 million units, despite Mexico’s 8.2 percent GDP contraction during that same period. In July 2021, generics sales grew by 9.3 percent year-over-year, so the market is still growing. Generics are seeing double-digit growth and OTC products are also growing between 2628 percent.
Q: How has the biosimilar market grown in Mexico and how interested are your members in participating in this segment?
A: The market for biosimilars has experienced moderate growth because few companies are producing them. The legal background for the patents of these products is complex so the industry is hesitant to dabble in this market. Some biosimilars have reached the market but they are few. In the EU, biosimilars had a positive impact on diseases like cancer and rheumatology and they could also benefit patients in Mexico.
Biosimilars are a great opportunity for the pharmaceutical market and joint actions by the government and the private sector could facilitate the conditions for local companies to produce biosimilars.
Q: What opportunities does AMEGI see in API manufacturing, especially after the disruptions caused by the COVID-19 outbreak?
A: The API market is dominated by India and China, which manufacture products consumed by every pharmaceutical manufacturer around the world. API shortages could cause global disruptions, which remain a concern as there are COVID-19 peaks still going on in every region of the world.
Years ago, the pharmaceutical industry had more API manufacturers. AMEGI sees an investment opportunity in this segment but, to grow this niche, the government needs to promote Mexico as a producer of APIs and help the industry export them to our commercial partners. Strengthening this market would make Mexico a complete provider of the pharmaceutical market and make the country less dependent of foreign suppliers. WHO, WIPO and WTO are also working to diversify API manufacturing and propel their production in different countries.

Q: What are the CCE’s priorities to support timely access to medicine and health services?
A: We have a very clear agenda, which we shared from the beginning with the current administration. This cross-cutting agenda that addresses the interests of 12 private sector organizations and is endorsed by FunSalud (the No. 1 health think tank in Latin America), the UNAM Faculty of Medicine and by Red de Acceso (a group that coordinates several patients’ associations), among other entities.
Our transversal agenda includes six main priorities. First, to implement a comprehensive prevention strategy to reduce chronic diseases. Second, to strengthen primary medical care by ensuring the quality of care. Third, to ensure that the public budget is allocated as efficiently and transparently as possible by integrating the private sector to cover investment gaps. Fourth, to measure the impact of public policy through key performance indicators to enable better decision-making. Fifth, given that the health system is highly fragmented, we want to promote the transition to a single system with significant private sector participation. We are facilitating and accelerating the adoption of technologies that allow an easier and more effective user experience through the system, such as the electronic health record. Sixth, we unanimously support universal health coverage, while being cautious with how it is implemented due to low public sector health spend and national finances that need to be kept in check, with a complementing participation of the private sector to fill this gap.
Q: How is the CCE collaborating with private hospitals to have their physicians vaccinated against COVID-19?
A: We see the importance of vaccinating healthcare workers who are exposed on a daily basis, regardless of whether they work in the public or private sector. Also, given the possibility of asymptomatic infections, it is critical not to differentiate between healthcare workers who are directly treating COVID-19 patients and those who are not. From our position, we support the vaccination plan and we want to help fulfill it to reestablish public health in our country and achieve a much-needed economic reactivation.
It is also important to recognize the role insurers have played throughout the pandemic by providing special coverage for healthcare personnel who have become ill and covering the costs for patients who were insured.
Q: How is the CCE prioritizing investments to support the public sector?
A: From the beginning of this administration, we identified issues that could be improved to help the country build infrastructure and health capacities to serve the population, especially those living in poverty or who are marginalized. However, this past year was marked by the pandemic and the priority has been on how to respond to that need. We already had a health system that faced lags and areas that needed strengthening and renovation. The pandemic emphasized these areas.
The country invests little in health as a percentage of its GDP compared to other countries. We believe that investment in health is good business because it yields results in the short, medium and long term, not only in terms of people’s well-being but also

in terms of productivity, innovation and employment. We also feel it is important to work as a team with the private sector because there are important capabilities in infrastructure, facilities, equipment, technology and trained health personnel. Just as an agreement was made so the government could use beds from private hospitals, there is other infrastructure that the government can use collaboratively. Examples of this are pharmacies and their clinics, the diagnostic capacity of labs and medicines provided by pharmaceutical companies. But collaboration is needed with clearer and more transparent processes and criteria for all participants. This becomes particularly important with the urgency arising from the pandemic.
In a post-COVID-19 era, there will be many opportunities: we can attract more vaccines, both for COVID-19 and other diseases; leverage technologies to provide greater access to healthcare without the need to build more hospitals and clinics; and encourage healthy lifestyles as part of a prevention strategy.
Q: What are the CCE’s views on the recent changes to the packaging of government-directed medicines and other measuresintroduced by COFEPRIS?
A: COFEPRIS has been able to position itself as a reference health agency, which allows medicine and device manufacturers to fast track into other markets once certified in Mexico. This opens the door to exports, opportunities for economic development, employment and investment. However, there has been a lag in procedures. Given that nearly 11 percent of national GDP goes through COFEPRIS, demand for its services is very high. Hence the need to move toward digitalized processes that can flow more quickly. This makes our economy more competitive, and also provides greater access to healthcare.
One relevant factor that has been repeatedly pointed out by this administration, is the importance of fighting corruption. Companies established in Mexico are serious companies that thrive in a transparent environment. Therefore, having an environment with more agile and transparent processes is a necessity for the health sector. We support the actions taken by the new commissioner, Alejandro Svarch, and we believe they coincide with recommendations we made previously.
We must ensure that the processes that have been implemented due to the pandemic are implemented on a level playing field between companies established in Mexico and those established abroad and, perhaps, even slightly favor those companies that have decided to trust, invest, generate jobs and pay their taxes in Mexico.
Collaborative responses to face the COVID-19 pandemic have been the only way to reduce the impact of the pandemic. But it is also necessary to strengthen the programs already in place to drive healthcare forward, experts say. “We need to move to a simpler, more efficient health system, where the private sector plays a relevant role in improving access for everyone,” says Patrick Devlyn, President of the Health Commission of CCE.
Public-Private Partnerships (PPPs) have been a common and effective mechanism to address service provision in Mexico. These joint programs between Mexico’s public and private health sectors have been key to address testing, spread containment, reduce hospitalization, maintain active supply chains and advance the approval and packing of vaccines to combat the virus. PPPs are a multisectoral tool that predates the pandemic and is used to tackle many of Mexico’s largest projects, such as the rebuilding of the collapsed Line 12 of Mexico City’s Metro. PPPs are known to be more transparent contracts, as their information is publicly shared and updated. To date, Mexico has eight operational PPP contracts in the health sector.
Prior to the pandemic, experts like Raúl Jacobo, Health Manager of CHG-Meridian Mexico, shared with MBN that “beyond just focusing on infrastructure, PPPs have great potential for the provision of certain procedures in the public sector, which would greatly help public hospitals and patients.” These types of collaborations gained relevance during the COVID-19 crisis. “Mexico’s Hospital Consortium (CMH) established a partnership with the government to support patient care during the pandemic,” says Javier Potes, Director General of CMH. After analyzing the capacity of the private sector to collaborate with the public sector, CMH and the Private Hospital Mexican Association (AMHP) realized that private hospitals had wider capacity as already programmed surgeries were being postponed due to fear of contagion. “This allowed us to negotiate with the government and to collaborate by offering our services to treat non-COVID-19 patients coming from public institutions.” Through the initiative formally called Todos Juntos Contra el COVID-19 (All Together Against COVID-19), beneficiaries of INSABI, IMSS, ISSSTE, SEDENA, SEMAR and PEMEX were referred by their health institutions to private hospitals and clinics participating in the agreement. This initiative is, according to Héctor Valle, Executive President of FunSalud, “the most relevant example of public-private partnerships for hospitals.”
Infrastructure, technologies and human resources from the public and private sectors are required to close the access gap to quality healthcare services, Devlyn says. For Potes, structure and human resources to provide healthcare are the most immediate gaps to address. “Before COVID-19, the private sector would have around 40 percent bed availability, which could perfectly be used to treat patients from the public sector at referenced prices.” Potes says that under the right collaboration framework, the private sector could start investing in infrastructure to treat government beneficiaries, focusing on service provision rather than the building itself, as in regular PPPs. “This is a much more effective way to secure patient access in both sectors,” says Potes.
On average, out-ofpocket healthcare expenditure in OECD countries stands at 2.6% of national GDP
Mexico spends around 2.7% of its annual GDP in healthcare The OECD recommends a GDP expenditure of at least 8.3% The federal government assigned 10.6% of its budget to healthcare in 2021
IMSS (Mexican Institute of Social Security) ISSSTE (Institute of Social Security and Services for State Workers)
SSA (Ministry of Health)
In contrast, Mexico spends 3.1% of its GDP on healthcare
Source: Chamber of Deputies
Navy)
SESA (State Health Services)
the population without social
IMSS-B (IMSS-Bienestar Program)
INSABI (Institute of Health for Well-Being)
Medical
Clinics and hospitals Providers of alternative
CONDITIONS AND LIMITATIONS OF THIS SEGMENTED MODEL
+ Does not offer universal protection
+ It is financed through taxes, worker and employee fees
+ Services are provided through public social security institutions, the public sector and the private sector
+ Medical personnel work at different entities, including those in the public sector
+ There is no coordination between the sectors. Activities are duplicated. Different institutions offer different health services, leading to inefficient resource management
+ Primary care is provided mainly by the public sector and social security institutions
+ Patients have the freedom to choose their specialists and doctors
+ Long waiting lists in the public sector
+ Patient satisfaction levels differ depending on the institution that provided the services

Héctor Valle
Executive President at FunSalud
Javier Potes Director General at CMH
Patrick Devlyn
President of the Health Commission at CCE
Raúl Anaya
Director General of Certificación at Consejo de Salubridad General
The COVID-19 pandemic proved how successful publicprivate partnerships (PPPs) in healthcare provision could be. While PPPs are common in other sectors, they are unusual in the strongly divided Mexican healthcare system but implementing them could bring many benefits. “Healthcare provision for the entire population was a great aspiration in the 1980s but it also comes with a great number of challenges. We have to think beyond sectors and institutions. Mexico needs a real, global healthcare system with the collaboration of various actors, including public and private entities. The pandemic proved that it is possible,” says Raúl Anaya, Director General of Certificación at Consejo de Salubridad General.
A sustainable and well-financed health system is crucial for every country to keep its population safe. WHO’s recommendation is to have an 80/20 composition between public and private spending. In 2018, public expenditure in healthcare represented 51 percent of the total health spending in Mexico, with the rest being financed by private parties. “Collaborations, such as that achieved during the pandemic, help to combine workers, infrastructure, medicines and devices in a timely manner to truly achieve healthcare access,” says Héctor Valle, Executive President at FunSalud.
While partnerships during the pandemic were successful and helped both parties have a better understanding of each other, collaborations must be planned long term, says Javier Potes, Director General of Mexico’s Hospital Consortium (CMH). “The private sector, including insurance companies, has to take some risks. We have to focus more on health than on diseases, working on prevention,” says Potes. In 2018, chronic-degenerative diseases, such as heart diseases and diabetes, caused 50 percent of the total deaths in Mexico, according to INEGI. These diseases, often called the “silent epidemic” by WHO, have to be targeted in Mexico through an integral prevention solution between public and private sectors, according to Patrick Devlyn, President of the Health Commission at Business Coordinating Council (CCE).

“We started to break down stereotypes that the private sector only seeks profit and is unethical or that the public sector is corruptible and riddled with advance-stopping bureaucracy. It has been proved that those stereotypes can be broken down,” says Anaya. To date, Mexico’s eight operational PPP contracts in the healthcare sector are hospitals in Guanajuato, Tamaulipas, State of Mexico, Nayarit, Chiapas, Yucatan and Mexico City. These contracts are considered more transparent thanks to monthly performance reports, which strengthen accountability for both public and private actors.

Criticism of the public health system over medicine shortages has become a recurring issue. In many cases, the shortage obliges people who suffer from chronic diseases to appeal to support networks, social organizations and private pharmacies.
It is estimated that the Mexican Social Security Institute (IMSS) increased the percentage of assorted recipes from 5 percent to 12 percent from 2019 to 2020, which means that more than 10 million recipes were not sorted. Adding in the decline of medical care for chronic patients who stopped visiting their IMSS clinic and the situation becomes even more complicated.
However, the shortage of drugs is not limited to public entities. The private sector, which groups a network with more than 40,000 pharmacies, is starting to look affected by the absence of medicines that the population needs.
We have detected a 15 percent shortage, which we believe has been tripled in recent weeks. Two out of 10 patients are prescribed alternative medicines to their usual treatment by their doctors. Some important brands missing from the private sector are Afrin (a nasal decongestant), Caltrate (calcium and vitamin D) and Riopan (an antacid). This considerably increases the out-of-pocket expense for patients and their relatives by more than a 70 percent.
Logistical difficulties are among the elements that delay supply. In the past, the transportation and the distribution of medicines were left to private businesses with more than 250,000 square meters of storage facilities and 1,000 transport units to manage the cold chain, a necessary condition for many substances. This is in contrast to the installed capacity of the federal government. The private initiative dispersed nearly 2.4 billion units each year, which demonstrates that we have the capacity to guarantee supply. On a monthly basis, this is about 200 million units that can be distributed to every state institution.
Another equally important element is that the pandemic has caused a shortage in raw materials globally. Mexico imports more than 80 percent of its raw material needs.
Finally, I believe the entities involved with the state and private initiative should think about their actual positioning. On the one hand, our industry has been subject to claims of corruption in distribution or manufacturing without any specific cases being named, no public complaints and no proof or investigation underway.
On the other hand, for many years and under different governments, the business sector has been delegated the responsibility for logistics and production, from manufacturers to brokers and businesses specialized in the supply of medicines. Today, that has changed. That is why the work of convincing the government of the importance of our sector should be constant. An example of a good dealmaker in the private sector is Carlos Slim, who with his experience and modesty has won over President Andrés Manuel López Obrador in the recent case of the collapse of a stretch of Line 12 of the subway in Mexico City.
In every crisis exists an opportunity. I am sure there is human talent in our industry that can succeed in the constructive dialogue that has been difficult to achieve during the 4th transformation.

Javier Picó
Partner at LifeSciences Consultants
If there is one common aspect in the health systems of the Latin American region, which has been further underlined by the ongoing COVID-19 pandemic, it is the uncertainty among its managers, providers, funders and patients regarding which future scenario will establish itself as the “new order” of health protection.
Uncertainty surrounds the pandemic in terms of when it will stop requiring most sanitary resources, allowing other “epidemics” like diabetes and cancer to be priorities once again. (This will supposedly happen once a minimum rate of vaccination is reached all over the world and not just in rich countries.)
There is also uncertainty about the impact that the lag in medical consultations in the last 18 months will have on the evolution of prevalent diseases and in the complications that will appear, resulting in a need to adjust health risk calculators.
There is uncertainty for managers around health spending planning in the midst of open fronts and budgetary constraints brought about by the economic crisis and its budding recovery process.
These uncertainties cloud the future. And that future uncertainty is blocking brave decision-making, which is vital for recovery.
It is, at the very least, doubtful that the next few years will provide clarity of information and criteria regarding sanitary planning decisions. As a result, the managers and players involved need to adapt to the new ways of working and making decisions in an uncertain environment, which, in turn, requires the facilitation of established working environments and processes.
Epidemiological health demand-estimation processes, average health services’ consumption estimation (clinical, drugs, medical devices) and evaluation criteria for new and current technologies are just some of the aspects that need to be managed with some flexibility to respond to the changing and uncertain scenarios that will present themselves in the next few years.
It has been widely said that the COVID-19 pandemic should make us reevaluate our health values, societies and even personal relationships. Beyond that, the health systems and social protection agencies should reevaluate their priorities, roles and processes.
This calls for brave leaders in health systems and social protection agencies who are capable of learning to navigate uncertain territories without being penalized by archaic rules and allowed to manage the risk of making mistakes and reacting accordingly.
More than ever before, only the most profound technical knowledge of effective health systems, together with organizational agility, can accelerate the recovery and redesign of the healthcare model that this new society is demanding.
Executive Director of AMID

Q: The medical devices manufacturing industry is expected to grow 6.1 percent, globally. How will this increase reflect in Mexico?
A: This growth has been driven by the manufacturing of personal protection equipment. These are high-tech supplies that Mexico is capable of manufacturing, such as specialized face masks. To complement our efforts and boost our manufacturing capacities, AMID has requested a meeting with the minister of economy to attract more final assembly processes to Mexico. To achieve this, Mexico would need to increase is medical devices consumption, as the final assembly is commonly done at the product’s point of sale to avoid damaging the device. One example is ventilators, which are 80 percent manufactured in Mexico. However, the final assembly takes place where the device is sold.
Mexico needs to improve its 43rd ranking in medical devices consumption versus it eighth place standing in production. The solution to this is simple: the government needs to understand the benefits of medical devices and allocate more budget to these solutions. The execution is difficult, however, and AMID has been working on this for several years. Purchasing processes through UNOPS make this goal more complicated because we have unclear schemes and uncertain orders.
Q: Mexico is a large manufacturer of syringes. With COVID-19 vaccination campaigns, how has demand for these disposable devices increased?
A: Traditionally, the acquisition of healing materials, including different types of syringes, was through public tenders that included around 4,500 SKUs the government required. Demand remained quite stable around that number. However, we were surprised to see that the SKUs posted for the latest UNOPS acquisition process totaled only 600. We communicated our concern regarding the drastic decrease from 4,500 to 600 SKUs. Also, we asked how the remaining codes would be covered but we have not received an answer. Prior to this situation, UNOPS hosted a meeting, which was very encouraging. However, there were many subjects left unsolved and unclear, such as the planning of the tenders, which they explained was done through INSABI, while UNOPS was only in charge of fulfilling the request.
Usually, there is a trend in the number of syringes requested by the government through the centralized purchase scheme, which we estimate should have increased at least by 35 percent this year, considering the current vaccination program for COVID-19. With this number, we wanted to be very conservative, but with the missing 3,900 SKUs and the lack of answers from the public sector, this forecast seems to have turned around. We are still waiting for the information of an alternative acquisition or an explanation for this missing supply of syringes that will certainly be needed this year. We need this information to begin redirecting our efforts in case the acquisition has been covered by the government. If that is the case, we would begin exporting the syringes we have because the national demand would be covered. Many AMID members are multinational companies, so export requests for this device are already on our doorstep.
We had the same problem with ventilators last year, when many health systems globally had to respond to the growing peak of contagion and severe COVID-19 cases. During this period, we

waited for the government to request ventilators but the industry could not wait forever. It was in our best interest to supply the local government first and we did approach officials. However, we received no answer until months after.
Q: How does the medical devices sector contribute to the value-based healthcare model?
A: This is a priority for AMID and we have experts on the subject working with us. Putting the patient at the center of our work guarantees quality, efficiency, innovation and cost-effectiveness in the development and manufacturing of medical devices. However, medical devices are sometimes not accessible to all segments of the population. Value-based healthcare models are a way to break this barrier and provide patients with access to innovative solutions.
Many times, what guarantees the purchase of a medical device is the price, when it should be the benefit it provides to the patient. At AMID, we are in favor of free competition. However, without putting the patient at the center of our operations, we will not be able to close this virtuous circle. Aside from the benefits it provides to patients and health systems, value-based healthcare foments innovation.
Prior to the pandemic, AMID began a research partnership with IMSS that was focused on compiling real-world evidence. We want to prove that through the use of medical devices at public hospitals, we could generate better outcomes for the patient while also fomenting innovation. I am hoping we can resume our research this year and be able to measure the outcomes and the benefits of medical devices in this model.
Q: How are you working to strengthening the MexicoUS relationship, given that US President Joe Biden has expressed his desire to strengthen US supply chains?
A: We are looking forward to strengthening the good relationship we have with the US regarding medical devices. We want to attract more investment to Mexico to continue manufacturing for foreign companies. Moreover, we want to pour that investment into local medical devices companies. Mexico’s manufacturing capacities and good practices are among our most valuable assets in this sector. Devices like heart valves are handmade with such quality and detail that it is hard to deny the level of our production.
Mexico is also working toward sustainable practices, gender equality and competitive salaries. Companies are taking care of their talent and of their environment to remain a top choice.

Partner
Q: Patent waiving for COVID-19 vaccines has been touted as a way to increase access to those jabs. How would such a measure impact global vaccination campaigns?
A: Patents are not responsible for the crisis or issues related to the mismanagement of health systems. It is easy to say that patents are barriers but this is incorrect. The technology developed to create COVID-19 vaccines is very complex and is recognized through legal protection. Patent protection should not be used as the argument to blame lack of access, neither for COVID-19 vaccines nor for any other medical development. If anything, patents help innovation reach the market and foment further medical developments.
For the COVID-19 vaccine, it is worth noting that the global demand is unprecedented, which alone is likely to cause delays in vaccine delivery. Production processes for these vaccines must be performed in specialized infrastructure with controlled environments for their manufacture, storage and distribution. Therefore, a strong and continuous supply chain and expert workforce are necessary across this entire operation.
Patent waiving will not solve any of the supply chain requirements or challenges in the manufacturing of the vaccine. Pharmaceutical innovation, protected by patents, is developing these unique solutions to a global crisis in record time. New drugs and new vaccines are not created spontaneously, it derives from the virtuous circle of innovation fueled by the patent system IP protection is a significant incentive for the pharmaceutical industry. Without this mechanism, COVID-19 vaccines could have taken up years to be developed. Vaccines are the result of many joint ventures and collaborations between two or more pharmaceuticals that combined technology and science to reach this goal faster. Without patent protection, investment on vaccines technology would have been out of the question.
To eliminate the limitations of manufacturing it is necessary for countries to invest in it. International mechanisms like COVAX could enhance vaccine production, without compromising innovation and efficacy.
Q: How will the new Federal Law for the Protection of Industrial Property impact the innovative medicine sector?
A: In general terms and with few exceptions, the new IP Law is positive for innovation. Regarding topics related with the pharma industry, the Bolar exemption has always existed. First it was an exemption to the law for the experimental use of a patent product and it was added to the Law for the Protection of Industrial Property, specifically for conducting tests for the approval process. This is a system of equity between the one who has the IP and the rest of the public. In the life sciences field, this exemption gains more relevance as it involves life-saving technology.
What happened in November, aside from the already-established protection rules for commercial purposes was a change in the time frame. In the past, experimental processes could begin three years prior to a chemical compound patent expiration, or eight years before in the case of a biological compound. These times have been eliminated. Therefore, processes can be carried out at any time. This is positive as long as manufacturers do not abuse the opportunity and begin the process for commercial purposes early.

Navigating Uncertain Scenarios
Javier Picó Partner of Lifesciences Consultants
Transversal Initiatives Propel Specialized Health Talent
Georgina García President of Cluster Médico Jalisco
Will Mexico Become a VC Hub for the Legal Cannabis Industry?
Erick Ponce President of the Promoting Association for the Mexican Cannabis Industry (GPIC)
Learning to Play with UNOPS and a New Framework
Lisandro Herrera Counsel of Galicia Abogados
Luis Marin
Senior Associate of Galicia Abogados
Mexico’s Healthcare System: Challenges and Solutions
Mario Muniz
General Manager North Latam of IQVIA
Mexico’s Right to Health
02/25/2021
Socializing Health
María Jesús Salido Rojo CEO of Social Diabetes
Decolonizing Global Health Practice
06/15/2021
Environmental Issues Impact Human Health
06/22/2021
COFEPRIS’s New Molecules Registry Updated
06/29/2021
Innovation and accessibility have been determinant for the pharmaceutical industry. The value of innovation was heavily evidenced after the COVID-19 vaccine was developed and delivered in an unprecedented eight-month period, securing health and also economic prosperity.
The health industry is quickly moving toward new ways of delivering effective treatments for global diseases. At the same time, both innovative and generics companies are looking for accelerated pathways to introduce their developments and impact the lives of thousands of patients. Companies are also finding new financing solutions that make their therapies a sustainable option for health systems and patients, integrating technology to empower patients on their journey to health by offering accompaniment apps and systems to ensure not only treatment attachment but a successful health outcome.
In this context, the Mexican pharmaceutical sector is part of the foundation of the national economy, as it creates specialized manufacturing jobs and continues to expand its generics offer. Generics companies continue to expand their role as allies of the health system and their efforts have led to significant growth compared to previous years.

Research and development in pharma is key to developing precise therapies and sustainable health systems. However, collaboration between the public and private sectors is necessary to mitigate the risks related to these ventures and to make the most of the available resources.
“Public-private partnerships should play an increasing role in advancing scientific progress and innovation,” according to “Investment in a Robust R&D Infrastructure,” an article by Pfizer published in 2021. Only a collaborative R&D ecosystem that reflects this will speed up the development of innovative breakthroughs to benefit all citizens. “We believe governments need to continue to provide routes for public and industry partnered consortia that reflect the environment required for innovation, rather than solely focusing on academia-led consortia.”
Governments can directly support private developments, like vaccines, in two primary ways, either by covering the costs of R&D or by committing in advance to purchasing a successful vaccine batch upon a firm achieving specified development goals . For instance, for the development of the Moderna vaccine in the US, the New England Journal of Medicine reported that several government entities contributed to the development. The total contribution was US$2.5 billion. Thanks to this investment, the US had rapid and exclusive access to this vaccine.
Private investment has also made a difference in treatment access. Mexico’s infrastructure and resources to produce a COVID-19 vaccine was proven wanting against countries like the US. However, the nation’s pharmaceutical sector is globally recognized and an important player for global pharmaceutical companies that have manufacturing plants in Mexico. While development might not be the country’s strongest suit, production and packaging are. These processes also require investment in state-of-the-art facilities able to support the science behind the vaccine. “The market is competitive but its potential is greater. Some companies are already taking advantage of the opportunities, like Liomont, a company that employs around 1,470 people and has a production capacity of more than 120 million units per year, which will be involved in production of the AstraZeneca-Oxford COVID-19 vaccine,” says Enrique Martínez, Founder and Director General of INEFAM.
Still, for Sonia Pérez, Executive Director of UDIBI-IPN, while manufacturing capabilities are to be taken advantage of, the lack of investment in R&D “is what stops the country from moving from manufacturing to technology development.” Moreover, Jorge Valdez, Dean of Tecnológico de Monterrey School of Medicine and Health Sciences ( TecSalud), says that to achieve what governments and private companies have with the COVID-19 vaccine, there is a need to let go of the “absurd” idea of government and private sector separation. “In Mexico, the public and private sector are heavily divided, regardless of the industry, which has been proven to be absurd.”
MEXICO’S PHARMACEUTICAL INDUSTRY AT A GLANCE
+ Mexico is the second-largest pharmaceutical market in Latin America
+ The country is a major producer of high - tech medicines, including antibiotics, anti - inflammatories and cancer treatments
+ The industry represents approximately 1.2% of national GDP and 7.2% of manufacturing GDP
+ The market in Mexico has an approximate value of US$14.5 million annually
+ It is the seventh-most important manufacturing activity out of a total of 291, based on production
+ It has a direct impact or economic spillover on 161 other activities , out of a total of 259 that make up the Mexican economy
+ The industry employs 80,000 people, with an average of 121 people per company. The manufacturing industry’s average stands at 10 people per company, while the rate for the national economy is 5 per company
+ The average monthly wage in the pharmaceutical industry is MX$22,385 (US$1,107) compared to the average in the manufacturing industry of MX$11,426 (US$565)
+ Between 2007 and 2014 , the industry has invested more than MX$327.7 billion (US$16.2 billion), which represents a sustained average annual growth of 7%
+ The value of exports in 2015 was US$2.5 billion , compared to a value of US$7 billion in imports . For every dollar exported, almost US$3 are imported
LEADING PHARMACEUTICAL COMPANIES IN MEXICO IN 2020 BY REVENUE (MX$ billion)

Cynthia Ramírez
Communications Director at AMIIF
Cristobal Thompson
Executive Director at AMIIF
Florencia Davel
VP, General Manager, Latin America at Bristol Myers Squibb & President of FIFARMA
Angeles Martínez
Senior Principal and Head of Consulting, North Latam at IQVIA
Antonio Loaeza
Country Medical Director at Sanofi Genzyme
Pharmaceutical innovation takes time, effort and investment. However, the main goal of innovation is only achieved when it reaches the patient, a path that is still fraught with challenges in Mexico. In the last few years, access to basic sanitation, clean water, immunization and access to pharmaceuticals have been critical drivers of health improvement, says Cristobal Thompson, Executive Director of the Mexican Association of Pharmaceutical Research Industries (AMIIF). The speed at which innovations arrive to the market and the industry pipeline play an active role in patients’ quality of life. “We are moving from mitigating the impact of diseases through symptom management to novel treatments that create real transformative change for patients, their families and their environment,” says Cynthia Ramírez, Communications Director of AMIIF.
The value of innovation, however, only becomes meaningful when it reaches the patients who need it. Achieving this is no easy task as everyone in the healthcare ecosystem needs to accelerate access pathways to pharmaceutical innovation so that patients have access to new treatments. Access must also be provided on time, which has not yet been achieved in Mexico as regulatory processes are slow. A solution to process delays, while vital for innovation, is just one of many barriers that are holding the industry back, says Angeles Martínez, Senior Principal and Head of Consulting for North Latin America at IQVIA. Mexico, unlike other countries like Brazil, the US or Japan, still has many areas of improvement to make innovation accessible. While in Mexico it takes over four years to make a treatment available, in other regions of the world it can take less than two.

Working in partnership rather than individually in the healthcare ecosystem is another step toward bringing innovation to patients. Florencia Davel, Vice President and General Manager for Latin America of Bristol Myers Squibb, says that scientific advances over the last century have addressed the diseases challenging the sector, such as HIV, which has seen a 60 percent decrease in deaths compared to 2004. More recently, she noted, the COVID-19 vaccine that has lowered the risk of hospitalization is a sign of “early accessible innovation.” The pandemic is an unprecedented event where collaboration between different stakeholders of the healthcare ecosystem has taken place at a global scale, adds Country Medical Director of Sanofi Genzyme Antonio Loaeza. “This has given us the opportunity to bring new technologies and biological platforms like those using messenger RNA (mRNA), which are gaining strength in areas such as oncology and immunology.”

Q: What actions is Novartis taking in Mexico to increase access to innovative medicines?
A: Novartis has a global guideline called “The Principles of Access” that establishes the actions we should follow to ensure that patients have accelerated access to healthcare. These actions and their impact vary depending on the country as there are some with a much more amiable regulatory framework for innovate therapy introduction and other markets with a more challenging process. In some countries, companies can take years to receive a regulatory approval, whereas in others, established medicine schemes can speed up the process. Mexico has this basic medicine scheme, which ensures that regardless of the public health institute, the government will ensure these medicines are supplied and available.
Novartis shares common goals with the Mexican government, such as free universal health coverage. Therefore, the company has many initiatives to contribute. Among them is Novartis Access, through which we make available a medicine portfolio of around 15-20 drugs that include patented and generic medicines from our Sandoz branch. These drugs are offered at a symbolic price of US$1 per patient each month. With this program, we are seeking to expand medicine and health service access.
Q: Novartis released an e-commerce program in Mexico for specialized pharmaceutical products. What is the main goal of this program?
A: E-commerce has become a regular source of services. We are taking advantage of it to provide an access option without the costs associated with intermediaries because products are sold directly to the public. Digitalization for internal and external performance has to be among the priorities of any company. The decision to launch our first e-commerce store in Mexico is a reflection of Novartis’ strong bet on technology. In the long term, this could also enhance drug affordability in the market. This program has been very successful and has outperformed our expectations. We see a prosperous future for it as we will increase our offering and integrate more products. We hope the Mexican authorities build a regulatory framework for these types of platforms so that we can reach more people and have a greater impact.
Q: Novartis is working with CureVac to produce a COVID-19 vaccine. What is Novartis’ role in this alliance?
A: This is part of our effort to be a part of the solution to the COVID-19 pandemic. Since last year, part of these efforts focused on a coalition of 15 companies supported by the Bill and Melinda Gates Foundation and a British investment fund through which we all contributed from our fronts with what we knew best. In our case, this meant research. Novartis has heavily invested in researching COVID-19 therapies or treatments as, by nature, the virus is here to stay, just as viruses like influenza have. Therefore, finding a treatment is an essential part of this fight. Novartis is holding clinical trials for a number of drugs to find a treatment. On the vaccine front, Novartis wanted to support vaccine production to accelerate global vaccination campaigns. We just entered an agreement with CureVac to assign our manufacturing plant in Austria to the production of up to 150 million vaccines and contribute to the collaborative global effort of achieving immunization against COVID-19.

Q: When is Sanofi’s COVID-19 vaccine expected and how will it contribute to global efforts to combat the disease?
A: Sanofi is the only company in the world that has two different COVID-19 vaccines in development. The first is a candidate vaccine made in collaboration with the US Office of Advanced Biomedical Research and Development (BARDA). It will use our cell-based recombinant protein baculovirus manufacturing platform, currently used to produce the seasonal influenza vaccine, along with an adjuvant. Sanofi Pasteur has joined forces with GSK to develop this vaccine. Sanofi brings to the collaboration the antigen, the protein that stimulates the body’s immune response against the virus, which is based on recombinant protein technology. In February, we announced a new Phase II study with 720 volunteers over 18 years of age to select the most appropriate antigen dose for Phase III evaluation of our possible adjuvanted recombinant protein COVID-19 vaccine. The other candidate vaccine was made in partnership with TranslateBio and will use new messenger RNA technology. The Phase I and II studies began in March and will allow the evaluation of safety, immune response and reactogenicity, after preclinical data showed high levels of neutralizing antibodies.
Q: Sanofi is collaborating with Pfizer/BioNTech to manufacture vaccines. How does this demonstrate Sanofi’s commitment to healthcare?
A: Faced with an unprecedented pandemic, Sanofi has sought to respond in the same way: we have generated strategic alliances that allow us to move swiftly toward a solution to block the virus. We decided to help address global needs and support BioNTech in manufacturing its COVID-19 vaccine, given that we have the technology and facilities to do so. Sanofi will provide BioNTech access to its infrastructure and expertise to produce 125 million doses of the COVID-19 vaccine in the EU in 2021, as we are aware that the sooner the vaccine doses are available, the more lives can be saved.
We have played a vital role in the fight against COVID-19 by mobilizing our industrial capacity around the world to also support Johnson & Johnson with the formulation and filling of 12 million doses of vaccines per month. We will also assist Moderna in the manufacture of up to 200 million doses of its COVID-19 vaccine starting in September 2021.
Q: How does Sanofi use AI and other technologies to improve drug design and delivery and how does this translate intofor better patient outcomes?
A: Globally, Sanofi works with specialists in AI to accelerate research on the benefits of certain therapies. There is also great potential in the industrial sector. Sanofi has put in place the factory of the future, which will include intelligent equipment connected with sensors to analyze and control production processes. These state-of-the-art techniques will make it possible to predict and ensure the quality of biological medicines. The use of AI will also further accelerate the development of vaccines and medicines at an unprecedented rate. Another angle in development is the application of AI in devices that people use all the time: wearables. In Mexico, we have just presented the new application, “Delivering Patient Health,” which collects information from patients with diabetes or hypertension to facilitate monitoring their treatments from their mobile devices.

Q: What have been the results of your work with public institutions to introduce your products for diabetes, thyroid, oncology and multiple sclerosis?
A: We are pleased with the inclusion of Mavenclad for the treatment of multiple sclerosis in the public healthcare system. We have already begun treating several patients at INNN and ISSSTE and we will soon have the opportunity to benefit patients at IMSS and other institutions. Oncological treatments have also been prioritized by local authorities. We are providing tests for colorectal cancer patients to help doctors make more precise clinical therapeutic decisions.
To reach more people, we are expanding the manufacturing site for Euthyrox (levothyroxine), which will allow us to increase substantially our capacities. We are also working on a technology transfer project for the extended release of a diabetes treatment, a challenging condition that threatens over 10 percent of Mexico’s population.
Q: Merck is performing clinical trials in Mexico. What are the benefits of these trials for the local population?
A: Merck is scheduled to participate in two multiple sclerosis studies at the end of 2021. By participating in these studies, we can obtain a better profile of the ideal drug for any patient and achieve a better view of the benefits for specific patient groups. Access is likely to become easier through clinical trials because they provide researchers a better and deeper understanding of diseases and therapies.
Q: Last year, Merck planned to launch a product to treat kidney disease or the urogenital system. What is the status of this product launch?
A: We are about to receive the urogenital system indication approval from COFEPRIS for Bavencio, which is the immunooncology drug indicated for Merkel cell carcinoma, a rare type of skin cancer. We expect to launch this new indication by the end of 2021. The medication will be available in the private market immediately and we will be submitting our dossier to the General Health Council for its evaluation and approval for the public sector.
Q: Merck’s lipids have played an active role in COVID-19 vaccine development. How did the company balance this demand with regular workflows?
A: Lipids are a key component of mRNA-based vaccines. Merck launched a new high-purity synthetic cholesterol product nine months ahead of schedule to meet the higher demand for lipids and in doing so, we helped manufacturers bring lifesaving therapies to patients faster. To meet the increase in demand, we expanded capacities at our manufacturing sites in the EU and the US. These expansions are part of a multiyear program to increase our industrial capacity, grow Merck’s capabilities to support a growing global demand and make significant contributions to public health. In Mexico, we do not have an operation to provide lipids for vaccines but we do participate in the filling process. Our local manufacturing capabilities focus on traditional pharma, biosimilars and influenza vaccines.

Q: What factors drove Chiesi Mexico’s 36 percent growth last year?
A: Chiesi’s product portfolio is focused on respiratory diseases and as COVID-19’s main affectation is on the respiratory system; our products were used as part of the recovery treatment against the virus. Asthmatic and EPOC patients enhanced their preventive measures because they are aware of the impacts of COVID-19, so adherence to treatment has been stronger and medicine consumption more frequent, as well. Regarding our work with the government on specialized products, we have experienced delays with INSABI related to our neonatal products. However, we saw a recovery in 4Q20 after INSABI released its purchasing orders.
Q: Chiesi recently introduced a care model based on an ethical approach to patients, families and care providers. What is the main purpose of this approach?
A: This is a global initiative from Chiesi based on patient-centric activities that favor health. We empathetically approach patients to understand their needs, regardless if Chiesi is the provider of their solution. We want to improve patients’ quality of life and save the lives of those suffering from complex diseases. We are restructuring the management of our business and our approach to patients and their environment. This also aligns with Chiesi’s pillars: Air, Rare and Care. Air relates to the respiratory system, which is our core focus. Care stands for transplant and critical or specialized-care patients. Rare is our latest expansion area. It focuses on rare diseases and on finding a treatment for unmet patient needs.
Q: How has Chiesi approached the government’s changes regarding medicine supply?
A: There is still no improvement regarding this complex subject, which remains a significant problem for the local industry. Since 2019, the government has wanted to radically transform the healthcare system through a necessary reform. However, the rules for this reform are still not clear and there are gaps to fill. We had a tender in the second half of 2019; just one tender in 2020, which generated medicine shortages due to poor management processes; and the UNOPS tenders in 2021. UNOPS is internationally recognized for its medicine supply, transparency and clear rules, which are positive assets and raised the expectations for this year’s supply. However, we are facing the same scenario as last year, with unfulfilled contracts.
With this uncertainty, it has been difficult for Chiesi to formulate a response. However, we remain flexible and open to change to continue supplying as many patients as possible. As a provider, we want a clear schedule with defined timelines.
Q: How does this uncertainty damage Mexico’s position as an important player in the pharmaceutical industry?
A: This firstly affects patients because they could not receive their medicines on time in governmental sector. For the industry, it creates complexity and doubt. Both multinational and national companies require profits to continue working, which can be compromised if Mexico prevents transparency in this sector. This can convince multinational companies to reconsider their plans for Mexico and their investment intentions.

President and Country Manager of Pfizer
Q: Innovation is one of Pfizer’s core values and those efforts stand out with the production of a COVID-19 vaccine. What sets this vaccine apart from others?
A: From the beginning of the pandemic, we were clear this was not a race between pharmaceutical companies but a race against the virus. Although for Pfizer to create a vaccine against COVID-19 represented a great challenge, having at hand scientific innovation of this caliber was not fortuitous but the result of our over 170 years of innovative vocation.
Alongside BioNTech, Pfizer worked at unprecedented speed to develop, test and manufacture vaccines based on messenger RNA technology. These vaccines teach our cells to produce a specific protein that triggers an immune response capable of generating antibodies to prevent COVID-19 infection. From the beginning, our scientists worked in parallel, not sequentially, which was decisive in the timely development of the vaccine. The actions we implemented at the clinical, manufacturing and logistics levels are a sample of the quality of our processes and the talent of our people.
Going from the creation of a safe and effective vaccine to the first inoculation in only eight months is undoubtedly historic and an example of what can be achieved through innovation and Pfizer’s four fundamental values: Courage, Excellence, Equity and Joy.
Q: How is Pfizer ensuring vaccine production and distribution inline with the contracts that countries have signedwith the company?
A: We are committed to making the Pfizer- BioNTech COVID-19 vaccine available to all people around the world to help end the pandemic. To do so, we increased production of this vaccine in Kalamazoo, Michigan, from where we are exporting it.
We use our global supply chain to ship vaccines to governments (including Mexico’s), fulfil our commitments and ensure reliable, equitable and continuous deployment. Production capacity has grown steadily due to continued improvements in the vaccine supply chain, including the expansion of existing facilities and the addition of more suppliers, Pfizer- BioNTech sites and contract manufacturers.
We are committed to implementing sustainable solutions by supporting the creation of manufacturing networks on several continents. The goal is to leverage our patented mRNA technology to help improve the health of people around the world.
Q: Aside from your alliance with BioNTech, what other alliances is Pfizer seeking to continue successfully delivering the COVID-19 vaccine?
A: Our scientific community continuesto explore every possible avenue to protect people from COVID-19, and we are proud to be part of an unprecedented global collaborative effort. For example, we recently announced plans to provide the US government with 200 million doses in 2021 and 300 million doses in the first half of 2022 at a nonprofit price to support multilateral efforts to address the rise in infection in many parts

of the world. The US government, in turn, will donate doses of our vaccine to 92 low and lower-middleincome countries and economies.
In addition, Pfizer and BioNTech have an existing agreement to supply vaccine doses to the COVAX mechanism, established by GAVI, the Vaccine Alliance, the Coalition for the Promotion of Innovations for Epidemic Preparedness and the World Health Organization. The Pfizer- BioNTech doses allocated through COVAX have already reached many countries and territories.
Fair and equitable distribution has been our priority from day one and we are happy to do our part to help vaccinate the world. To date, Pfizer and BioNTech have shipped 700 million doses to more than 100 countries or territories around the world; we have direct supply agreements with 122 nations and, according to current projections, we expect to manufacture up to 3 billion doses by the end of 2021.
Q: How has Pfizer ensured its regular medicine production remains continuous as it manages the high demand for COVID-19 vaccines?
A: Our plant located in Toluca, State of Mexico, continues to be a benchmark for the region and is responsible for producing 53 million medicines that are exported to other Latin American countries. More than a year after the start of the pandemic, all administrative staff is teleworking. But our production facility never stopped operations because it is an essential industry. It has been operating under the strictest security measures.
Fortunately, our technological approach allowed us to be prepared to work this way and to accelerate projects in our therapeutic portfolios.
Q: What projects does Pfizer have in its R&D pipeline for non-COVID-19 diseases?
A: Following our purpose of “generating breakthroughs that change people’s lives,” our pipeline is made up of over 90 molecules related to oncology, inflammation and immunology, internal medicine, vaccines, anti-infectives and rare diseases. These treatments will mark a before and after in the life of patients. This is possible because each year, over 15 percent of the company’s revenue is dedicated to researching new drugs.
Our goal for the Mexican market is to introduce 25 new drugs by 2025, of which seven will arrive during 2021 and benefit 24 million people.
With death rates from chronic diseases climbing, the motivation for drug acquisition has moved beyond short-term economic savings to long-term sustainable finances with the goal of implementing a patient-centric model that results in a healthier population. As a result, novel payment models are emerging among healthcare payers and pharmaceutical companies to continue fomenting innovation to improve health and rein in skyrocketing treatment costs.
Financing is necessary to maintain the quality of drugs as it translates to scientific discoveries and useful therapies, which directly impact patient health and life expectancy. Regular financing schemes include direct purchasing, while some companies might also turn to debt acquisition or equity investment. The direct purchase model, however, has fallen short in propelling R&D, as shown by the rising death rates due to chronic diseases, including cardiovascular disease, diabetes and cancer. Under the direct purchasing scheme, financial savings are the drivers for treatment acquisition and there is little focus on the patient outcome. Which criteria will govern drug selection depends on national health objectives and the context in which the drugs are used.
As the healthcare sector evolves, many changes to this financial scheme are starting to emerge as health systems seek to adapt to a preventive culture that, according to the UK’s National Health Service, would have a much more visible and cost-effective result for governments and patients. Valuebased pricing is a rising financing model that is based on the assessment of the therapeutic value of medicines. According to WHO, value-based pricing can lead to a reduction in prices for medicines with no or limited added value and an increase in the price of medicines with high value, which in turn may encourage manufacturers to focus their R&D on therapeutic medicines with superior benefits for the patient.
Diego Guarin, Regional Market Access Lead for Latin America of Merck MSD, says that value-based pricing is the trend in the industry, as it is formulated around an entire integration of the health system with a patient-centric view. However, he says that for Mexico to correctly implement this model, all industry stakeholders need to be on the same page. “We think the system should be driven by aligned incentives to improve health outcomes,” says Guarin. “Those who deliver the best results can be rewarded financially or with a reputation ranking, for example.” Sandra Ramírez, General Manager of Bristol Myers Squibb Mexico and Colombia, says that these types of models also require a solid legal framework and infrastructure that allows management verifiers, actively involving the national government. Moreover, Fernando Cruz, Country President and Head of Corporate Affairs and Communication at Novartis Group Mexico, says that to begin applying this model, first a country needs to identify an area or disease to begin its implementation. Adds Cruz: “There is still a long way to go but in Mexico, discussions about applying this payment scheme for ailments such as multiple sclerosis or blindness caused by diabetic retinopathy have already started.”

Estefanía Torres
Q: How have trials for Takeda’s dengue vaccine turned out and what is the importance of this development for the company and for Mexico?
A: This vaccine has been in clinical development for over five years. The first regulatory submission was just introduced this year and we are looking forward to the results as this vaccine will bring hope and opportunities to the Mexican population. With this vaccine, Takeda is preventing the health complications that arise from hemorrhagic dengue. The company is also seeking to add to the primary care of this disease. At Takeda,we are still working to makethe vaccine fully available because we know how much it would mean to Mexico.
Mexico will participate in the vaccine’s development through clinical trials, which will allow scientists to observe how the solution affects participants and generate scientific evidence.
Q: What role does Takeda want to play in the development of the pharmaceutical industry in Mexico and in the battle against the country’s chronic-degenerative burden?
A: Takeda is committed to being one of the most innovative biopharmaceutical companies in the world to address neglected diseases. As a company, we also want to raise awareness about these unknown diseases to avoid future complications that can later lead to chronic degenerative diseases. We want to transform patients’ lives through awareness, adherence to treatment, support and follow-ups.
During the pandemic, we noticed that ambulatory treatments were an active way to keep in touch with our patients and foment the adherence to treatment. Through our ambulatory solutions, patients no longer need to visit hospitals on a weekly basis. Instead, they receive their treatment at home.
At Takeda, we work closely with doctors to offer better solutions that meet the needs of their patients. This work has been carried out through our Within3 platform, which overcomes COVID-19 limitations to offer a digital solution to the R&D areas of pharmaceutical companies. Within3 provides a virtual space to talk with doctors and other relevant stakeholders to generate a continuous, uninterrupted workflow that facilitates innovation. For players in the biopharmaceutical and pharmaceutical industry, constant contact with the medical community, patient groups and management teams is key to developing better solutions for their needs. Technology applications, such as Within3, have accelerated our processes and given us flexibility. As a result, productivity has improved and we are able to use our time more efficiently.
Q: How is Takeda enhancing access to its innovative therapies?
A: We carry out multidisciplinary efforts. For example, we provide doctors and specialists with continuous information regarding our innovations and their benefits. We also provide educational forums for primary contact doctors, who need to be properly trained to gain a wider perspective of diseases, disease trends and available solutions. This is fundamental for patients to receive a timely diagnosis through a proper first contact experience. Our medicine access teams are in charge of the regulatory requirements of each country to introduce our therapies to institutions and facilities.

Country Manager of Sandoz
Q: How has Sandoz contributed to maintaining economic stability throughout the pandemic?
A: The pandemic was rough for all companies. At Sandoz, we are honored to be working with over 3,00 employees, who all maintained their jobs, salaries and working conditions despite the economic situation. Our employees are our priority; therefore, for a year, none went into the field to promote products. Sandoz is trying to shift the company’s employee culture. We were recognized as a Top Employer due to our innovation on work modalities. We are trying to change the 8-to-5 model to something we call the “unboss” approach, in which employees can manage their time by owning their results.
Sandoz has a large supply of all its products, which allows us to support access to medicine. We have a single united supply line for the entire company that allows us to plan our production and distribution accordingly. While this could appear to be a disadvantage, for Sandoz it has meant quality and excellence, which is essential to the generics industry.
Q: How can generics manufacturing contribute to pharma’s role in reactivating the Mexican economy?
A: We continue to invest in this industry and recognize it as a pillar. Sandoz previously invested US$0.5 million a year in new launches for Mexico, but starting last year, we decided to invest five times more. In 2021, we will be investing almost US$2.5 million and developing more than eight products annually.
Q: How is Sandoz expanding its biosimilar line and promoting its benefits in terms of cost and effectiveness in Mexico?
A: Sandoz’s main objective is to become the leading biosimilar brand in Mexico, mirroring our position in the global market. We now have eight available biosimilars, of which three are available in Mexico: somatropine (Omnitrope), filgrastim (Zarzio) and rituximab (Arasamila). In the next 18 months, Sandoz is planning to introduce four more, with two of those coming in the next 12 months.
Biosimilars are complex molecules and their cost might make their acquisition harder for some institutions. For that reason, offering biosimilars at accessible prices would be a milestone.
Introducing biosimilars into Mexico has not been an easy task. Sandoz introduced the first biosimilar to the US and Japan (somatropine) but this remains an innovative area for most countries. Physicians need to understand the exact benefits of these new molecules. To introduce biosimilars into the Mexican market, we are approaching physicians to explain the safety and quality of these therapeutic options, as well as the savings they can bring to healthcare institutions.
Before they enter the market, these molecules must be approved by COFEPRIS’ Committee of New Molecules. At this point, COFEPRIS, like every other regulatory agency in the world, has its hands full with COVID-19 approvals but we are confident we will get our approvals. COFEPRIS has also optimized its processes, which are now simplified, digitalized and accepted in English.

President of Grupo Neolpharma
Q: What are the goals of the company’s new injectables plant?
A: This plant will produce injectables that have been in high demand during the current COVID-19 pandemic. It will produce norepinephrine, midazolam and other anti-inflammatory medicines. This plant will also pack COVID-19 vaccines in large quantities of about 150 million vials a year. This would be the equivalent of a vial for every Mexican.
Q: How is Grupo Neolpharma helping to fight the COVID-19 outbreak in Mexico?
A: We have made several medicines readily available to Mexicans, such as azithromycin, paracetamol and others used by the government to fight the COVID-19 pandemic. Grupo Neolpharma has also worked with researchers and universities in the development of a COVID-19 vaccine, including UNAM and a university in Queretaro. Our biotechnology plant is able to manufacture the proteins necessary to produce a COVID-19 vaccine. At this point, we have created enough doses for preclinical studies in animals to determine safety and effectiveness. We are ready to support Phase 1 and 2 clinical trials.
However, Mexico’s government offers little support for medical research into vaccines. One doctor working on the project told me that local universities have invested about US$1.5 million in the development of a COVID-19 vaccine. In comparison, the US government gave a single pharmaceutical company over US$1 billion in grants. While there is little support in the project from local authorities, we are sure to finish our Phase 1 and 2 clinical trials.
Q: How were Grupo Neolpharma’s API production capabilities affected by COVID-19?
A: Mexico is dependent on APIs from China, India and increasingly from the EU. COVID-19 had a significant impact on the global production and supply of APIs. For example, India, a large manufacturer, saw its exports affected. Due to the increased attention to medications, India’s government had to issue a new approval process for the export of APIs, which affected our manufacturing operations. These circumstances helped us recognize that there are significant opportunities to manufacture APIs in Mexico and eliminate our reliance on foreign countries. Minister of Economy Tatiana Clouthier is strongly supporting the local manufacturing of APIs as it is becoming increasingly apparent that countries should be more autonomous in their API production. This has benefited Grupo Neolpharma and we are now tripling API production at one plant.
Moreover, USMCA requires that North America increases its regional API manufacturing and supply capabilities, so we are exploring the construction of a new, larger manufacturing plant. For the construction of this plant, we are finalizing a loan agreement with the World Bank’s International Finance Corporation (IFC). To determine which APIs to manufacture at this plant, we are studying consumer habits in Latin America. We are considering medications in cardio-metabolic, obesity, central immune system, skeletal muscle and other specialties that have grown in prevalence during the pandemic. Before making a decision, we also need to consider changes to the current administrations’ healthcare policies.

Carlos López
Director General of Medix
It has been nearly 17 months since we started the confinement due to the global health crisis that, besides taking us by surprise, put us in a scenario that few envisioned. Gradually, we are seeing the light of a new era characterized by a digital transformation, including in how we communicate. In this era, it is of the utmost importance to anticipate and to adapt the traditional forms of communication to the new environment in such a way that it allows us to provide information and have it available in a timely, quick, simple, truthful and verifiable way. This will let us continue connecting with our different target audiences and, in the case of companies, with their employees, customers, and suppliers.
The role of communication is a key element in generating true teamwork when working remotely and without the usual physical contact, so that our colleagues’ commitment and responsibilities are not only unaffected but even favored. However, the migration to a digital communication scheme involves not only opportunities but also great challenges, since we cannot assume that all employees have available resources to access digital media, or that they are necessarily skilled in their handling or inclined to use them. Given that, the company must also take into account its different audiences and provide the necessary tools so that they can operate under this new scheme.
When migrating from an on-site scheme to a remote or hybrid one, communication strategies must focus on:
+ Valuing and promoting the well-being of the most important pillar of the organization: people
+ Having multidisciplinary groups made up of leaders, physicians, and specialists in health and wellness
+ Diversifying messages and media.
+ Committing to transparent and honest communication.
+ Constant and timely communication.
+ Providing training in the use of digital media.
+ Acknowledging and thanking employees for their commitment, passion, and dedication in facing the pandemic.
Companies experienced a significant challenge at the beginning of the pandemic when they had to send 100 percent of their administrative staff to work from home. The trust placed in each of the collaborators, together with clear, precise and open communication, as well as the material support provided to develop this working modality, were the key elements to maintain a reciprocal commitment with employees. If this consolidates despite the pandemic, it will, undoubtedly, make it possible to have teams that are committed to companies and eager to win achievements. As indicated earlier, we find ourselves in an environment where we must take advantage of the opportunity and acceleration offered by the digital era and new technologies to create an environment of greater closeness with audiences, which we did not previously have in mind or that was very difficult to do, taking advantage of every space or channel available to companies.
With all this, we must not forget the importance of coherence in communication within companies. We cannot talk about something that is not experienced internally. During difficult times for the world, when the health and well-being of families are essential, we must not only communicate and understand these concepts but also experience them. Communicating is useless if we do not experience these concepts personally.

Q: What makes Within3 a smart solution for virtual engagement and why do stakeholders need it to ensure better treatment development?
A: Most pharmaceutical companies meet in person to engage with key stakeholders but travel restrictions imposed during the pandemic led companies to turn to virtual alternatives to interact with their client base. The pandemic also accelerated the use of virtual platforms for internal engagement. COVID-19 made the industry adopt in 24 months what in other circumstances would have taken five to seven years. Thanks to this greater experience with virtual engagement technologies, businesses have recognized that technology adoption is no longer an innovation but a necessity for business continuity.
Pharmaceutical and medical devices companies have also embraced virtual engagement technologies when engaging physicians and patients. These actors are spread throughout the country and travel is now difficult, and even dangerous. In urban settings, virtual engagement has been welcomed because of the heavy burden of commuting. Other areas have limited access to good internet connectivity so our software also works via browser.
Q: What is the role of Within3 in generating savings in medicine or product developments?
A: Pharmaceuticals spend billions of dollars to bring drugs to the market. These costs come from a massive communication problem because there are numerous stakeholders involved at every step of the process, from scientists to economists. Within3 helps companies speed up communication so information is gathered and understood faster, which allows companies to accelerate processes down the line.
Q: How does Within3 protect its platform from cyberattacks?
A: Our clients trust us with their data so we have a responsibility to protect it. Within3’s security department is constantly analyzing and auditing our processes. We invest significantly to make sure that we are strengthening our systems as much as possible. Many clients conduct their own penetration studies at Within3 to assess our environment before they start working with us. Maintaining a safe and clean environment for our clients around the world is a priority.
Historically, Within3 centered on getting physicians’ online to share information with each other and with their pharmaceutical or medical device sponsors. We have a new product for the analysis of breast cancer communities to help clients understand what is happening with these patients and to get a better sense of how to answer larger questions, such as where their company locate clinical trial sites.
We are also implementing products that will allow clients to understand and analyze all the insights in real time using advanced AI and natural language processing, which will allow us to provide them information that often takes months to analyze.

Orlando Aguirre
Government Sales Director, Market Access & Pricing of Merck Group
Rafael Gual Director General of CANIFARMA
Enrique Liñero
Country Head of Sandoz
Benjamin Vega
Commercial Director of Allen Laboratories
Juan Luis Serrano Leets
Life Sciences Partner at Sánchez Devanny
Jesús Arenas Wiedfeldt
Corporate Communication Director of Maypo
Shortages are not a new phenomenon but they have been increasing in recent years after new policies affected the industry’s operations. Compromised supply threatens the healthcare system as a whole by creating additional costs from the search for replacements and puts patients at risks. “Mexico used to buy medicines and medical supplies through a centralized system to avoid different prices for every institution and state. The new administration changed everything, which caused considerable logistical problems,” says Juan Luis Serrano Leets, Partner of Life Sciences at Sánchez Devanny.
“Mexico is becoming unable to provide medicines to those who need them the most,” says Rafael Gual, Director General of CANIFARMA. The main challenge for the industry is to keep prices fair, says Enrique Liñero, Country Head at Sandoz. Mexicans are seeing a worrying increase in their out-of-pocket expenses related to healthcare matters, which increased from MX$2,358 (US$118) to MX$3,299 (US$165) per quarter between 2018 and 2020, according to CIEP. The industry has made a big effort to keep its lowest possible prices as many people are turning to the private sector. “We have not stopped trying to strengthen communication between the industry and government institutions, looking for transparency that allows us to keep responding to the country’s needs,” says Orlando Aguirre, Government Sales Director, Market Access and Pricing at Merck Group. But for pharmaceutical companies, it has become challenging to plan appropriately with suppliers and clients, given uncertainties, says Aguirre. “It is difficult to have direct communication with the complex system and UNOPS, making it very difficult to negotiate raw materials with our suppliers,” says Benjamín Vega, Commercial Director of Allen Laboratories.

The decision by the government to cut intermediaries ended 20 years of centralized purchases. The previous system favored the creation of “concentrators,” distribution companies that offered very specific services, such as taking medical supplies directly to surgery rooms and hospitals in general. These distributors oversaw the complex logistics of millions of units produced by different laboratories to successfully cover the great demand. “Distributors do a very complex job. The new administration did an incomplete diagnosis and now faces logistical problems. Large quantities of medicines and supplies need to be handled in different inventories by institutions, dispatched depending on consumption frequencies, with a very detailed picking and packing. We are trying to explain to decision-makers how important our job is,” says Jesús Arenas Wiedfeldt, Corporate Communication Director at Maypo.

Constanza Losada President and Country Manager of Pfizer

Juan Silanes CEO of Inosan Biopharma

Florencia Davel
General Manager of Bristol Myers Squibb, Latam
The COVID-19 pandemic showed that investment in innovation and R&D will never go to waste in the healthcare industry. Companies and countries that prioritize this investment will see the benefits in the short and long term, with profit not only reflected in health but in overall economic development. Mexico Health Review asked local and multinational pharmaceutical industry leaders about the importance of investment in innovation.
Pfizer is the world’s most diversified biopharmaceutical company and a benchmark for innovation: we created disruptive drugs that transformed the industry, we generated millions of vaccines against diseases such as meningitis and pneumococcus and we created cancer treatments that have provided a better quality of life for patients. Getting the COVID-19 vaccine in record time is an example of what we can achieve through investment in innovation and we will continue to provide new therapies that improve health and quality of life or provide hope for diseases that currently do not have a cure. Today, we know that without health there is no well-being. We must continue to invest in research to reduce the global burden of today’s diseases and protect future generations from subsequent pandemics.
The key is to find exactly what will make the company disruptive. In the health industry there is much room to innovate and be creative in the approach to the many healthcare ailments affecting the population. In other industries, such as tech or finance, disruptive solutions tend to arise quite often but in the pharmaceutical industry there are still areas of opportunity to address. By nature, this has been a conservative industry but there are ways to offer truly innovative approaches. Companies need to take advantage of new technologies to solve long-time health burdens.
It is estimated that, globally, research in the biopharmaceutical industry has represented an investment of US$188 billion in R&D in 2020 (including the COVID-19 research efforts) and that this year the barrier of US$200 billion will be reached. This creates direct and indirect qualified employment, knowledge and technology transfer and, most importantly, it leads to the development of innovative drugs for the benefit of patients. These figures reflect the commitment of the research industry on a sustained basis: the average cost to develop a drug has increased 67 percent since 2010, reaching US$2 billion in 2020, according to Deloitte. Additionally, Latin America represents 10 percent of clinical studies, which indicates that there is still an opportunity to increase activity and investment in research.

Q: How do promotional campaigns impact the company’s products?
A: Promotional campaigns like that for Espadiva, which was conducted through digital networks and television, lead to growth. In the example of Espadiva, the campaign led to growth in purchase intentions and a substantial increase in sales. For this specific solution, we are the fastest-growing product as a result of the promotional campaign surrounding it. Likewise, in the OTC category, Apotex is about to launch marketing campaigns for Mugasin, a fiber that improves the digestive system. The product targets a larger consumer segment and as such, it will require a different approach. Espadiva targeted young women who were active on social media, while the target consumer for Mugasin is across age groups and gender. We have also significantly consolidated our electrolytes line. This is a powder solution that has further growth potential.
We have been exploring new digital communication campaigns, such as Guía Tu Salud (Guide Your Health). Instead of promoting the product directly, we work with our commercial partners to share educational facts that guide the patients to the product.
Q: How did USMCA’s new IP protection rules will the recent changes of COFEPRIS impact the pharmaceutical industry?
A: The impact was mostly on biotechnology products. Patent protections have been extended and this will have a negative impact on the speed at which cheaper and more product options become available. On the other hand, COFEPRIS has also proposed eliminating the need for clinical studies in Mexico to request sanitary registration of biosimilar biotechnological drugs, which can ease the introduction of these types of products.
Another change was the validity of extensions of health records. Currently, the extension must be requested every five years. Given that medicines and medical devices must be reviewed periodically, COFEPRIS proposes to strengthen health surveillance, with extensions only necessary after the first five years of obtaining the health registry. The term of the extension would be indefinite, except in cases where COFEPRIS determines it is necessary to request an extension for surveillance reasons. COFEPRIS is now also accepting health documentation in English, which is positive for foreign companies like Apotex because it saves time and money spent on translation. Documents can be presented digitally, as well, which will make processes more efficient.
One not very positive change relates to packaging for government products. A couple of years ago, packaging became standardized but now they are asking us to go back to differentiation. An announcement on wait times for approvals is still pending. Delays are affecting returns for many companies, which also impacts the product’s possible introduction to other markets if countries require a certificate of origin for a product.
Q: How was Apotex’s product demand impacted by disruptions in 2020?
A: There has been an interesting market shift. On the one hand, the lack of medicine supply from the government has generated demand in the private sector. Moreover, as a result of the pandemic and the serious threat to people with chronic diseases, we have

seen an increase in demand for products to treat these ailments. This is a good sign regarding treatment adherence and how patients are approaching their health.
In the public sector, due to several changes in the acquisition process, we experienced disruption in our regular supply. About 44 percent of the government’s medicine purchases were concluded directly with the provider, which meant a 100 percent growth in this form of purchasing. However, our sales in this sector did experience a decrease as a result of the administration’s complex purchasing system.
In the private sector, we experienced growth tied to the shortages in medicines in the public sector. Overall, our mission was to ensure medicine supply for all our patients and I think Apotex was successful in that.
Q: How has Apotex diversified its supplier base?
A: We are the only company with API production in Canada and Mexico and we are also the only company with complete product manufacturing in those two countries. Compared to other companies, we have better vertical supplier integration. I have seen other companies diversifying their supplier base but, in that sense, Apotex has enough supplier capacity and control over the quality of its products. Still, the company is well aware of the global situation, so we anticipate our stock and plan for incoming orders. We have also diversified our supplier base and have alternative options in line with our R&D projects in Mexico, where we have secured our raw material needs through different providers.
Q: What role will the pharmaceutical industry play in Mexico’s economic recovery?
A: This industry has contributed to and sustained Mexico’s economy during the pandemic. We have not stopped our operations or economic contribution. I do think the authorities could work on attracting more investment into this area. The pharmaceutical industry has long-term investment plans and we are careful about where we put our money.
On another note, nitrosamines are threatening the supply continuityof this market. These are residual elements that if above certain levels, can be carcinogenic. This has caused the withdrawal of products such as ranitidine. Products like this, if taken regularly, can increase the risk of developing cancer. This has been disruptive for many companies, as low level of nitrosamines are commonly present in drugs. Nitrosamines are, in fact, more common in food and beverages but given the high regulation of our industry, more attention will be present in medicines.


Generic companies often race to obtain a privileged place in the market by launching the first generic product, which involves the collaboration of multidisciplinary teams that were not previously considered part of pharmaceutical development. The process has incorporated raw material suppliers, which have developed strategies to support the development of generics.
Grupo CPQ is an example of this effort, standing out thanks to its collaboration with the pharmaceutical sector in the early development of generic drugs. For over 35 years, Grupo CPQ has been a consolidated distributor of raw materials and active ingredients for different industrial sectors. Along the way, it has become an important part of the supply chain for the pharmaceutical industry. Aware of the importance of the accelerated development of generic products, Grupo CPQ recently developed an innovation area focused on supporting the areas involved in the development of new generic products to overcome the obstacles that hold back their launch to the market.
One of the main obstacles to the launch of generic drugs is the intellectual property strategy of innovative companies, which focus on protecting different characteristics of the active principle, such as salts or crystalline structures. Grupo CPQ has adopted this challenge as its own and, as part of its evolution, has committed itself to distributing active ingredients. This means its buyers do not need to worry about the issue related to the patents involved. In addition, Grupo CPQ provides advice regarding intellectual property to accelerate the development and launch of generic products.

Now Will We Have a National Pharmaceutical Policy?
Deyanira Chiñas
Commercial Director of T5DC
Securing Safe, Regulated Pharma 4.0 Practices for Mexico
Jaime Castro
Managing Director of ISPE Mexico
Philippe Fournet Fayard Board Member and Co-Founder of ISPE Mexico
Mexico Is Fertile Ground for Clinical Research
Marlene Llópiz CEO of CRO Mexicana
Disruptive Technology Solutions to Improve Health Access
Juan Silanes CEO of Inosan Biopharma
Maintaining Relevance in Digital Marketing
David Boronat President of Multiplica
Caught in the Middle
Karel Fucikovsky Director of Medical Care Mexico of Pierre Fabre Pharma
UNOPS Brings Savings, Unfulfilled Contracts, Medicine Shortages
06/01/2021
Cost Savings, Health Through Biosimilars
07/02/2021
Biomarin’s Dwarfism Drug Receives EMA Approval
08/27/2021

Since the beginning of the pandemic, medical devices manufacturers have worked against the clock to meet the unparalleled global demand for ventilators. This year, syringes, one of Mexico’s strongest manufacturing products, leads the demand curve.
Despite the strength of the local manufacturing industry, Mexico’s local consumption falls short. It is no secret that the industry’s number of exports overwhelms that of imports, which means that to boost health infrastructure in the country and strengthen the sector even more, this reality needs to shift.
Investment and collaboration to propel local consumption of medical devices are paramount and different actors are already looking into this. Healthcare providers are encouraging the use of technology and interconnecting their products to have a complete scope of a patient’s journey. This demands personalized, unique solutions for patients that can also empower healthcare professionals with improved capabilities. At the same time, medical devices manufacturers are also moving toward value-based healthcare models to provide access to larger, more expensive medical devices that have proven to support patients and doctors.
This chapter will explore the innovations of the sector to meet the present health demands of the country, keeping efforts to move toward a sustainable, inclusive health system in mind.

Shifting the focus of healthcare from a reactive to a preventive model has been an ongoing conversation in the industry. This considers a transition from prioritizing healthcare production to focusing on patient value by moving to a value-based healthcare (VBHC) model. This, however, is not only limited to medicines or treatments. Medical devices must also become part of a resultsdriven model for VBHC to be successful. The importance of VBHC is in the potential it has to improve the overall health of the population, “opening the possibility to reduce the burden on hospitals and bring relief to saturated health systems,” says Michael Barriga, General Manager and COO of Omron Healthcare.
In a VBHC model, providers, including hospitals and physicians, are paid based on patient outcomes. Among its benefits, VBHC allows patients to spend less money to achieve better health. Patients with chronic diseases, such as cancer, diabetes, high blood pressure, COPD and obesity, report a quicker recovery or better management of the disease. As a result, patients require fewer doctor’s visits, medical tests and procedures, spending less on prescription medication.
Ana Riquelme, Executive Director of AMID, says that for sectors that are sometimes not accessible to all segments of the population, like medical devices, “VBHC models are a way to break the access barrier and provide patients with access to innovative solutions.” This model is especially valuable in Mexico because companies and governments have worked for a long time to advance quality healthcare access, according to Alejandro Paolini, President of AMID. This is tied to the government’s budget, while having a willing industry actively looking to innovate in business and payment models can be the first step toward a transformation in the healthcare sector. “VBHC is an are alternative to large initial investment usually coming from the government to provide patients with a wider chance for a positive outcome,” says Paolini.
A successful medical devices sector within this transition begins with patients using medical devices as a diagnostics tool to detect an ailment at an early stage. Thus, “consumption of devices would continue to be high but they would be used as a preventive rather than a corrective tool. This model creates cost savings for health systems and for patients,” says Barriga. The clear benefit of diagnostic devices is that they can detect a disease or dismiss an erroneous condition in a symptomatic patient but their capabilities can go much further. Proper diagnosis enables the tracking of patients’ progress, stabilizing them and predicting or improving their outcome. Furthermore, diagnostic tools open the door to personalized medicine that will allow the generation of specific treatments for an individual patient. David Kershenobich, Director General of the National Institute of Health Sciences and Nutrition Salvador Zubirán (INCMNSZ), says that “in the management of a patient with diabetes mellitus, being able to perform in a single visit all interventions, such as that of the nutritionist, endocrinologist, dentist, ophthalmologist and physical therapist, reduces costs for both patients and the institution and promotes better attachment to treatment.”
+ Medical devices manufacturing has become one of Mexico’s fastestgrowing manufacturing industries
+ Mexico exported around US$15 billion in medical equipment and supplies by the end of 2020
+ The Mexican market for medical instruments and devices has an annual value of US$5.3 billion , which represents 7.6 billion devices and units , in a market that until 2019 was stable. After the COVID-19 pandemic, there was a reduction in market value of 30% and a reduction in units of 15%
US$4.5 billion Medical, surgical and deontological instruments
US$544 million Orthopedic devices and apparatus
US$322 million Mechanotherapy devices
US$414 million Others
REASONS
1. Mexico’s robust chain of manufacturing training, industrial communities and skilled workforce for highly complex manufacturing activities at competitive rates
2. Handmade device production of small devices that require various stages of construction
3. Close proximity to the US, one of the largest medical markets for groundbreaking medical research companies
Source: International Trade Administration

Ana Riquelme
Executive Director at AMID
Alejandro Paolini
President AMID & Managing Director Mexico, Central America & the Caribbean at Siemens Healthineers
Juan Gabriel Gay
Managing Director at TI Salud
Héctor Orellana
VP North Latam at Medtronic
On the road to a value-based healthcare model (VBHC), medical devices play a unique and vital role by creating track records and making patient treatments more cost-effective. However, challenges such as lack of data and slow regulatory processes lead to an incohesive healthcare ecosystem. Healthcare providers’ focus is on the quality of services provided rather than quantity, says Alejandro Paolini, Managing Director for Mexico, Central America and the Caribbean at Siemens Healthineers. “When we talk about medical devices, we have to consider everything from a simple face mask or a digital thermometer to the most sophisticated equipment, such as an MRI or a Da Vinci surgical system,” he says. “I cannot imagine a value-based healthcare system that does not consider medical devices at the heart of its value proposition.”
The amount of information that medical devices are capable of generating, storing and analyzing is just a glimpse of the potential that these tools have in a value-based model, says Juan Gabriel Gay, Managing Director of IT Healthcare. In addition, the cost-effectiveness of medical devices allows the ecosystem to move more rapidly toward “quality rather than quantity.” Wanting to move toward a value-based model with a noticeable lag in data collection is, for Gay, “like driving a Volkswagen in a Formula 1 race.” In his view, the amount of data that healthcare providers are collecting today could already have laid the groundwork for a value-based model.

For Paolini,the shift toward a value-based model has to go hand in hand with digitalization. Given the outlook for medical devices in the healthcare sector, innovation priorities for medical device companies like Medtronic have shifted to meet the demands of value-based models. “Medical device outcomes need to be demonstrable to both the healthcare provider and the patient,” says Hector Orellana, Vice President for North Latin America of Medtronic. Including medical devices in the country’s medical ecosystem is also a weapon to address current challenges in the sector, including the increasing saturation of healthcare systems. “Collaboration between technology providers, public and private health systems is necessary to tackle this issue,” says Orellana.
“Medical devices have always provided solutions that make life easier for healthcare professionals,” says Ana Riquelme, Executive Director of AMID. “They improve quality of service by lowering per capita costs, enhancing the patient experience and improving coverage.”

Pablo Bufano
Q: The pandemic drove up global demand for ventilators and disposables. How has Dräger balanced this excess demand with regular demand?
A: We experienced high demand for ventilators and N95 masks for respiratory protection. In the case of ventilators, we tripled production compared to previous years. The main problem was to coordinate the demand from countries around the world. The availability of ventilators was very low because everything was compromised but sales have been considerably higher since last year. Thus, the company opened two new factories to address demand for respiratory protection equipment. We have a factory in Sweden and another in South Africa. We started collaborating with China and we built a factory in North America to respond to US consumption and another in France to address demand from the EU. The latter factory is also addressing demand from Mexico. In the case of equipment accessories and consumables, we worked with the factory’s suppliers to make sure there was enough raw material to increase production. Globally, the company distributed everything that was produced among all countries according to their usual consumption but we fell short because there was excessive demand.
Q: Last year, Dräger posted record earnings as a result of global product demand. How will Dräger reinvest this profit?
A: We opened two factories for the respiratory protection division and we are also investing in consumables to increase capacity. In addition, we have invested heavily in research and development. We will launch new products once they go through the certification process.
In the Mexican market, we are expanding into new business areas to support small hospitals that do not have the capacity to purchase our latest technologies even through financing. We have direct rental programs with hospitals in which they pay us a monthly fee and we provide the equipment and consumables for their surgeries and services. We have other programs to provide integral services, in which we set up the entire operating room and charge customers for its use. This is a riskier investment for us because we can only charge a fee if a client uses the operating room. We are using our profits to be able to offer better financing to our clients and to reach those small hospitals and clinics that do not have the budget to buy our equipment outright.
Our services team did a very important job during the pandemic in getting most of the equipment up and running for any patient who needed it. We are now looking at how we can reach out to the government so that the engineers who are still working at COVID-19 hotspots can be vaccinated as soon as possible.
Q: The means to supply medical devices to Mexico’s public sector changed after the government began acquiring products from UNOPS. How did Dräger manage this change?
A: The main change we are addressing is working with INSABI because it has not established a way to expedite purchases. During the past year, we struggled to collect payments related to the purchases it made during the pandemic. We are still collecting to this day but because of the constant changes in administration we have to restart everything from scratch.

Q: How does Medtronic ensure access to its innovations in Mexico?
A: Medtronic invests over US$2 million in R&D and innovation. We have around 19 research centers globally with 10,000 scientists, 4,300 patents and over 300 clinical trials in various stages. This investment is reflected in every device we produce.
Medtronic is one of the strongest manufacturers of medical devices in Mexico and the country provides a relevant contribution to Medtronic globally, which supports our focus in encouraging local consumption. We try to find an entry point through the public and private sectors to ensure we are reaching all patients who need a solution. We firmly believe in developing high-end, state-ofthe-art health environments in Mexico, equal to those in the US or the EU. Medtronic is a leader in the development of medical technology but we know that its value is only recognized when it benefits the patient. Medtronic is well aware of the key role medical professionals play in health systems. Therefore, we have also prioritized their training and education regarding our technologies, especially in this new digital era.
Medtronic also approaches the country’s health authorities to share the benefits of our devices in addressing Mexico’s disease profile. The company has also created a virtuous economic circle by consolidating its manufacturing in Mexico, which generates jobs, attracts investment and spurs development. By sharing how we are impacting individuals’ health, Medtronic hopes to make the authorities aware of the benefits of having a more productive population that is less dependent on the public health system, while at the same time being a source of employment and investment.
As the country begins to reopen post-COVID-19, Medtronic’s strategy is to make its entire portfolio available in Mexico and in the northern region of Latin America.
Q: What is the potential of Medtronic’s Extended Infusion Set in Mexico given the heavy diabetes burden in the country?
A: The Extended Infusion Set uses different indicators to ensure blood glucose levels remain stable for up to seven days. I personally had the chance to interact with some of the patients using it and observed how this technology significantly improved their lifestyle. The quality of life it provides patients changes their entire daily routine. They find themselves freer and in further control of their health throughout the day because they have information available through this device. Mexico’s high prevalence of diabetes makes it one of our most attractive markets for this watershed solution. The device is targeted to patients with type 1 diabetes so we are looking for as many patients as we can in Mexico and the world to provide them with a solution that can potentially increase their quality of life.
Q: Medtronic recently acquired Medicrea for 3D printed spinal implants. How will this acquisition strengthen Medtronic’s portfolio?
A: This is an example of Medtronic’s constant drive for improvements and to strengthen its portfolio. By acquiring expert companies in certain niches, Medtronic can then escalate related developments. Our goal is to remain a leader in relevant technologies and increase healthcare access.

Q: How does CHG-Meridian (CHG) support its clients amid their digital transformation?
A: There are two main advantages from working with CHG. The first is our technology renewal service, which gives our client the opportunity to access new technology and upgrade their performance with innovative equipment. The second is our leasing model, which allows clients to lease any kind of new technology, from software to complete solutions of hardware and software. Moreover, our web-based TESMA platform allows real-time information access around our clients’ assets. Normally, we update it every two years so clients can have this convenient digital access.
Q: How does CHG interact with the growing trend of interconnected hospitals?
A: TESMA is aligned with hospital connection services for when our clients are ready to implement these. Also, we offer our consultancy service to determine which system would suit our clients best, depending on their hospital needs. After that, we can offer a leasing service to finance their digital conversion. Depending on what the client is looking for, we assign the solution that fits best rather than overshare information, which can be overwhelming.
Hospital interconnection is a growing trend in Mexico, especially in hospital chains. TESMA provides many benefits for its ecosystems. The implementation and financing of such systems is a long-term commitment in terms of money and time but, in my experience, it is completely worth it.
Q: As technology advances, what is CHG’s growth strategy to boost its client portfolio?
A: Our priority is to access state-of-the-art technology and to remain up to date with all technological trends. That ensures we can respond to our clients’ requests and offer them an appropriate solution to improve their performance. Likewise, we innovate our leasing services according to the client’s plans. For instance, medical devices renewals tend to take up to five years. However, if a client decides to change their equipment earlier, CHG is ready to work with that.
As a consultant, we would also make recommendations and guide the client’s decision. For example, we may detect the coming launch of a new product that may be better suited to the client and advise them to wait. The decisions are always up to client but we lean on our global market expertise to provide advice.
Q: What are your growth expectations for 2021 and what are your main priorities?
A: We have two priorities. We want to continue supporting our clients with our consultancy services, which have been consistent during the pandemic. Moreover, we want to close the large projects we put on hold as a result of the lockdowns. We have projects related to nuclear medicine that require infrastructure and large medical devices and equipment. These projects normally take 12-24 months to complete but the pandemic prolonged them.

Nicole von Mohr
General Manager Breathing Circuits of Atramat
Q: How did you adapt to the reduction in surgeries brought by COVID-19 in both the public and private sector?
A: COVID-19 caused a decrease of around 80 percent in all scheduled surgeries for the public sector in Mexico and a significant decrease as well in the private sector. Of course, there were some emergency surgeries performed and that is why we still had sales in the public and private sectors throughout the peak of the pandemic.
The government’s new tender policy has been a challenge but everyday we are learning and adapting to its new ways of working. Atramat was able to compensate for this loss by focusing its efforts on opening new markets in other countries and increasing its sales in those countries where we were already present but that did not limit their operations due to COVID-19.
Our focus throughout these uncertain times was also placed on our new facility in Mexico that manufactures ventilation and anaesthesia circuits under the Altech brand. We had this project since before the pandemic but after the crisis, all our efforts were on completing the technological transfer and obtaining the GMP certificate to deliver high-quality ventilation machine consumables to care for COVID-19 patients.
Q: How did you adapt to the logistics challenges brought by the blockage in the Suez Canal?
A: Atramat has a big advantage because most of the raw materials it purchases are of small volume, so they can be shipped by air. With our seaborne imports, we increased our purchase volumes to guarantee full containers and mitigate the cost of the products placed in Mexico.
Q: How did you leverage your international presence to prevent disruption?
A: Our main focus throughout the pandemic has been to keep our people safe by making sure all preventive measures were in place. We also conducted constant testing with all our personnel. The other thing we did was to always be up to date on borders closing and all local and international regulations. That way, we created strategies to make sure all our products could be delivered. All our distributors did the same thing to prevent disruption.
Q: How is the acquisition of Santec and its cardiovascular line helping Atramat move forward in cardiovascular care?
A: Santec is a German manufacturer specialized in cardiovascular surgery, particularly in loops for mitral valve repair or replacement. Physicians in Germany design Santec’s products so it is similar to providing customized products focused in the specific surgeon’s needs.
This acquisition has strengthened our portfolio of cardiovascular products, allowing us to offer a complete solution for cardiovascular surgeries of all kind and is one of the stepping-stones to position our company as leader in the area of specialized heart surgeries.

Cesar Augusto Marron
Director General of Cardinal Health
Company leaders are starting to recognize that culture and strategy go hand in hand. Only when customercentric strategies are supported and advanced by culture will a company realize its customercentric vision.
A customer-centric strategy puts customer’s needs, wants and communication preferences at the center of the buying process. The customer journey should be designed so that all sales activities, marketing, customer service and operations are aimed at helping the customer achieve short- and long-term success. Fostering a customer-centric environment can increase customer satisfaction and loyalty, which result in stronger relationships, higher retention rates and an increase in referrals. Providing a positive and one-of-a-kind customer experience allows your company to stand out from others, leading you to acquire and retain more customers. There may be other organizations that sell similar products. Implementing a customer-centric environment can convince customers to choose your company over others, as many customers value a positive experience as much as the product’s performance.
The pharmaceutical sector is a prime example of the change in mindset to true customer-centricity — putting patients who need treatment at the center of the healthcare ecosystem. The concept may look simple when you start to think about providing a bestin-class integral service. To be fully effective, customer-centric actions should go beyond the sales department and include your customer service, marketing and operations as well. Companies with a customer-centric culture are driven by the desire to create the best possible customer experience.
Focusing more on customer experience and customer satisfaction is a smart goal for any organization. Transformation is not going to be easy and will take some time and resources in areas where customer centricity must be part of the strategic map and truly be integrated into daily operations. Here’s what you need to know to develop true customer centricity.
+ Prioritize your relationships with customers: As you work with customers, whether marketing, selling or designing products for them, remember to build a strong relationship and work hard to build a valuable and trustworthy relationship with them to ensure you keep them longer.
+ Adopt a consultative and integral selling approach: This is a key step to ensure each of your employees (especially your front-line employees) approach every interaction with your customers’ best interest in mind. That is the way to build a real customer-centric culture. Sales teams must live and breathe customer centricity, from start to finish.
A customer-centric sales strategy focuses first on understanding the issue, then on helping to solve it with the most appropriate solution based on what is truly in the customer’s best interest. This improves customer satisfaction and builds your brand reputation.
+ Investing in new technologies to centralize customer data: Use new technological methods to track customer data and understand insights and behaviors to reach and connect with them more effectively. Step forward to implement a customer-centric marketing strategy. Build and design tools to accomplish customer goals, and the business’s success will flow from that. Long-term value is your premise.
+ Strengthen customer service experience: True customer centricity is a business strategy that does not stop with the commercial team. Your customer service team is an integral part of the customer experience. Include customer service training programs designed to give your customer service team the skills needed to delight customers, grow customer loyalty, and differentiate your company from the competition.

On the operational side, the supply chain area should also be included in this transformation. Change the supply chain from the only goal of reducing costs to the customer experience improvement initiatives embedded in the process of moving finished products from suppliers to customers. A customer-centric supply chain is not just “demand-driven” anymore. You need to study your audience, their preferences, such as order channels, lead times and delivery methods and align them with your operations. Understand what your customers want, the market gap and your organizational resources to be more customer centric. Moreover, set realistic standards for your customers and be accountable to them.
To create a customer-centric supply chain, aim to make your supply chain visible. What orders are coming in and how to prioritize them? What products do you have on hand versus how much is in transit? Thus, collaborate with your key stakeholders to gain real-time visibility. Leverage that to be more reliable for your customers. If they trust you to deliver on your promises, you will enjoy repeated purchases and more revenue.
A big part of making your supply chain more customer-centric is being able to forecast what they need and when they need it. Data is key here. This includes POS data from customers, warehouse shipment data, returned merchandize and even shipping and delivery times. Every node along your supply chain creates useful data and it is important to capture it. Use it to forecast demand and supply fluctuations, which can help you become more agile and flexible to meet customers’ demand.
Transforming your organization by using a customercentric model not only improves the experience your customers have with you, but it also results in increased revenue, making it a win-win relationship. Be sure your customer service is translating into sales by giving your customer service professionals the skills and confidence to identify opportunities and present valuable solutions with every customer interaction they have. According to research from Deloitte, companies that use a customercentric strategy are 60 percent more profitable.
In conclusion, the business landscape today demands that organizations have the ability to transform themselves and be more agile. However, it is important to realize that this transformation is not a quick one. In fact, it will be a process that needs every stakeholder to be on board and committed to it. Evaluate everything through the eyes of the customer and with the customer’s needs, wants, and behaviors in mind. Only when customer centricity is embraced in this way, can it be implemented effectively throughout the organization.
Read the complete article
More about this person
More about this company
As vaccination campaigns move forward, Mexico is starting to build on recovery strategies to get its economy back on track. Many industries will contribute to these efforts but MBN interviewees say medical devices production, in particular, will play a significant role in pushing the country toward the new normal.
According to AMID, medical devices production in the country exceeds US$15.22 billion in value and generates more than 130,000 jobs. It also represents 0.3 percent of total GDP and 1.5 percent of manufacturing GDP. According to North American Production Sharing, the country’s position as the third-largest medical devices exporter, its leadership in FDA, CE & ISO 13485-certified manufacturing processes and the high percentage (70 percent) of plants operating in controlled environments – most having class 10,000 or class 100,000 clean rooms – are among the country’s main advantages in terms of production.
Even before the pandemic, KPMG had forecast continuous growth for the medical devices industry on “The Mexican Pharmaceutical Industry” report of 2017. The firm forecasted global annual sales growth of over 5 percent year-on-year, reaching nearly US$800 billion by 2030. “These projections reflect increasing demand for innovative new devices (like wearables) and services (like health data), as lifestyle-related diseases become more prevalent and economic development unlocks the huge potential in emerging markets,” states KPMG. Since the beginning of the COVID-19 pandemic, company members of AMID have experienced a sixfold increase in demand. Ana Riquelme, Executive Director of AMID, told MBN that this demand had been mainly driven by ventilators and personal protection supplies, which experienced a 1,000 percent increase in demand. As vaccination campaigns move forward, Mexico’s public demand for syringes is expected to grow by at least 35 percent, says Riquelme.
The medical devices sector has two clear growth axes: increasing local consumption and strengthening the country’s already established relationship with the US. “AMID wants to attract more investment to Mexico to continue manufacturing for foreign companies. We want to pour that investment into local medical devices companies,” says Riquelme. She points out that Mexico’s manufacturing capacities and good practices are among the most valuable assets in this sector.
Propelling local consumption of medical devices has been deemed essential to boost medical devices manufacturing in Mexico. Riquelme highlights that AMID has requested a meeting with the minister of economy to attract more final assembly processes to Mexico. “To achieve this, Mexico would need to increase its medical devices consumption, as the final assembly is commonly done at the product’s point of sale to avoid damaging the device.” One example is ventilators, which are 80 percent manufactured in Mexico. However, the final assembly takes place where the device is sold. “The solution to this is simple,” Riquelme says. “The government needs to understand the benefits of medical devices and allocate more budget to these solutions.”

Q: What is the difference between COVID-19 monitoring tests and the diagnostic COVID-19 tests that bioMérieux has developed?
A: The main difference relates to the moment when they are necessary. Monitoring tests offer a perspective on the development of a confirmed COVID-19 case, where as our diagnostic tests, whether PCR or antigen, determine the presence of the virus. Monitoring tests are useful to mandate hospitalization according to factors such as high D-Dimer protein presence. These tests allow doctors to prescribe anticoagulants or autoinflammatory drugs to prevent severe progression.
Q: What are bioMérieux’s reinvestment plans following the success of its COVID-19 tests?
A: North and South America played an important part in our rapid success. Our global plan targets the antimicrobial resistance awareness fight. Therefore, we will focus our efforts on educating doctors on the necessary use of antibiotics. We are still working to identify areas of opportunity or areas of reinforcement within our bimolecular and immunology portfolio.
One strategy to recover sales in our regular market is antimicrobial stewardship programs. Through this, we support governments on the use of antibiotics prescribed by doctors. This will drive our microbiology portfolio to regain a strong position in the market, which we lost due to the limitations of the pandemic. Microbiology tests are routinary and as lockdowns and restrictions lift, these tests are likely to bounce back in terms of sales.
Moreover, our antimicrobial stewardship initiative integrates health systems. We mostly work with hospitals. However, we are also close with pharma companies because they can provide enough medical information on their drugs to support doctors’ decisions regarding antibiotic prescriptions. This collaborative effort brings the industry closer to value-based healthcare models. bioMérieux’s goal is to improve the patient’s life though useful solutions, which involves having a timely and precise diagnosis. The outcome can only be seen by monitoring treatment adherence.
Q: How has bioMérieux ensured the continuity of antimicrobial initiatives with governmental institutions during the pandemic?
A: Adding hospitals to our educational strategies was difficult to achieve during the first months of the pandemic. We conducted a study on COVID-19’s impact on antimicrobial resistance in Latin America and the results, unfortunately, were negative. It is understandable that hospitals abandoned certain areas during the pandemic because the workloads were immense and hard to balance.
Q: How did bioMérieux overcome global supply chain disruptions during the pandemic?
A: This specifically impacted our R&D, especially when we were working on COVID-19 diagnostic tests. We were lucky to have contracts that prevented a crisis or significant disruption. Also, our US stock and supply allowed us to continue operating regularly. The main challenge was to ready our supply and stock, but we did not face major disruptions.

Mariana Tolovi
Q: What advances has Edwards Lifesciences made in the treatment of cardiovascular diseases?
A: The company’s commitment to innovation is backed-up with significant investment in R&D, currently running at 17 percent of the company’s annual revenues, twice the industry average.
Our SAPIEN valves are the most widely studied transcatheter valves, with more than 30,000 patients treated in clinical trials and registries in over 65 countries. Since the first commercial approval of the SAPIEN transcatheter valve in 2007, the SAPIEN family of valves have treated hundreds of thousands of patients worldwide.
Q: In Mexico, 70 percent of the valves used in patients are mechanical. What is Edwards Lifesciences strategy to change this market?
A: Edwards Lifesciences continues allying with medical societies, clinicians and academia to generate evidence and increase awareness on the benefits of tissue valves to patients and society.
Edwards Lifesciences generates evidence that supports the benefits of our technologies to patients and healthcare systems. In Mexico, we published a paper alongside specialists from public institutions addressing the positive impact tissue valves can have on health. We partnered with medical societies, decision makers and payers to propose solutions. As a global company, we value the partnership with our stakeholders worldwide. We have over 15,000 employees dedicated to helping clinicians, patients and their families.
Q: What are the main innovations Edwards Lifesciences is introducing to improve the quality of life of patients with heart disease?
A: We introduced RESILIA, which is a bovine pericardial tissue treated with a special integrity preservation technology that effectively eliminates free aldehydes, a key factor in tissue calcification, while protecting and preserving tissue.
RESILIA has helped to improve the durability of valves. Younger and more active patients may benefit from this technology as it reduces the need for long-term use of blood-thinning medication. Mexico will be the first country in America Latina to use RESILIA in segment-specific procedures, in which physicians must replace the aortic tract and the valve. It will allow surgeons to do these two procedures in a single surgery.
Q: How has Edwards Lifesciences secured product provision after Mexico’s public sector changed its medical supplies and medicines acquisition schemes?
A: Edwards Lifesciences was able attend the Mexican healthcare system needs. We made all the efforts to adapt to the changes requested by the authorities. Our Critical Care Business Unit and Supply Chain & Logistics teams had to order from UNOPS using a very different process than that which we use globally. We had to change our factories’ supply chain and quality to meet the requirements of this new process, and we were successful. The project was also carried out in record time and we supplied the first delivery in early August 2021.

Q: How was your sepsis indicator received in the Mexican market?
A: We presented it last year at many industry forums and it attracted a great deal of attention and interest, since sepsis cases have increased due to COVID-19 complications. However, further trials are needed for this solution to impact COVID-19 treatments. While sepsis has been recognized as a health priority, the high demand for resources to treat COVID-19 patients has diminished the impact of our indicator. We introduced the product last year. This year, we will make a concerted effort to position it in the recovering market. Our indicator can have a great impact in the ER but COVID-19 has taken over this area at the moment.
Q: Beckman Coulter was close to launching a COVID-19 serology test. How has this effort advanced?
A: We have released the test globally, along with additional versions. In Mexico, regulations have inhibited its introduction but we are hopeful that the regulatory authorities will soon look at their pending approvals for this and many other important developments for the industry.
Q: What is the impact of your Access Interleukin-6 (IL-6) development on COVID-19 patients?
A: IL-6 is a fully automated immunoassay designed to detect IL-6 levels in serum and plasma, which can aid physicians in identifying a severe inflammatory response to determine the risk from intubation in COVID-19 patients. This product is already available in Mexico as we submitted it for approval before the pandemic. This product is being used for COVID-19 cases even through it was not initially intended for this. Beckman Coulter commercializes this product together with our D-Dimer solution. Both of these developments offer useful parameters for monitoring COVID-19 patients. This product has also been introduced in the Puerto Rican market, where it is used by leading laboratories.
Q: How is Beckman Coulter adopting technological tools like AI in its practices?
A: Most of our focus is on the development of smart tools that improve diagnostic efficiency or that reduce the time required for a diagnosis. We offer digital options like our DxH ONE platform, which features digital components that allow big data analysis. All the data we generate stays in our laboratory information systems, meaning that we have huge unexplored and unexploited databases with large potential. DxH ONE allows data analysis, which facilitates decision-making and helps in identifying health trends among patients. The solution does not deliver automatic results because a medical professional needs to determine what is useful and what is not. Once the pandemic is over, we will continue exploiting these rich databases to deliver better results for clients and patients.
Q: How are you positing your solutions in the market amid COVID-19 limitations?
A: Beckman Coulter reformulated its approach and focused on what the market was looking for. This year, we are seeing quite a recovery in the use of diagnostic tests that were set aside during the critical months of the pandemic. We are focusing on encouraging this use among clients. We have had to find more clients, although our priority is to maintain our client base

Maria Johnson
Management Latin America Vice President of Boston Scientific
Q: How is Boston Scientific introducing innovation in care through its robust offering of medical devices?
A: Medical devices are less available to patients in Latin America than in more advanced economies. We prioritize access in the region but we go further because our goal is to provide true health coverage. Access can be limited by a patient’s coverage, their ability to make copayments and even the hospital they are in. By focusing on true health access, we increase access to care. During the pandemic, entire nations experienced limited access to basic healthcare services. We worked to map the customer’s journey and put in place innovation using virtual technologies so the necessary therapies and physicians were available in surgery rooms.
Q: What are the highlights of Boston Scientific’s valuebased model and why is it important to Latin America?
A: Hospital managers often operate in silo, where their priorities are based on the needs of the specific section they work in. A value-based proposition must recognize the importance of introducing a holistic, inclusive approach that addresses the need of patients. Our value-based approach is necessary for Latin America because the region has volatile economies and politics.
Our holistic approach allowed us to develop alliances with key stakeholders, patient groups, government and private payers. For example, we did an education program alongside the Mexican Diabetes Association. Latin America has a large number of lower limb amputations as a result of diabetes. Some of the largest issues that affect access to healthcare are lack of awareness, lack of early treatment or detection and information on the available therapies at all stages of the disease. By the time diabetes patients visit a hospital they often require an amputation. Alongside this association, we educate patients before it is too late.
Q: How has the pandemic impacted technology adoption in the healthcare sector?
A: COVID-19 has disrupted the medical devices ecosystem. Prior to the pandemic, the healthcare sector was one of the slowest in adopting new technology. Now, new technologies are commonplace. Some countries are using drones or blockchain technology to fill orders. New companies are also entering the market after exploring the limitations that COVID-19 put on traditional processes and combined them with digital solutions. The sector has new go-to market models and service models. The pandemic forced healthcare providers to undergo in a few months the digital transformation that under normal circumstances would have taken them 10 years.
Q: As a woman in a leadership position in the healthcare industry, what advances have you noticed in gender equality in the sector?
A: After taking a more active role in women’s groups like The Catalyst Group in the US, I noticed that the most significant factor in female empowerment was leadership and a commitment to drive change. At Boston Scientific, we have women on the executive team reporting to the CEO. We have been recognized in the industry as a company that really promotes gender equality, diversity and inclusion.

Q: How do your products related to cardiovascular disease support patients dealing with these issues?
A: The priority for Omron’s cardiovascular line is the construction of better communication channels between patients and doctors. Our monitors have evolved from traditional high-blood pressure monitors with no memory card to equipment that is able to record the patient’s at-home behavior and measure the impact of their treatment. We offer interconnectivity among devices through Bluetooth, transmitting the monitor’s data to the patient’s phone. The information allows the patient to have an understanding of their health. Patients can also share this information with their doctor or a family member. During the pandemic, this feature was especially useful as it allowed both doctors and family to follow-up on chronic or in-treatment processes.
Mexico’s high prevalence of chronic disease and diabetes make it a good target for our monitors. We also understand that Mexico’s socio-economic status may make our solutions unavailable to some patients, so Omron has developed a wide range of blood-pressure monitors that ensure inclusive access to our solutions. We offer a range of monitors from a compact high-tech monitor to a simple, high-quality monitor for at-home care.
We want to make blood-pressure care a routine step for diagnosed and non-diagnosed patients. Omron promotes a preventive healthcare culture where patients create healthier lifestyles for themselves through the use of innovative, technological trends that improve their healthcare and allow them to control their habits.
Q: Omron has a globally important respiratory division. How did this business behave during the COVID-19 pandemic?
A: Omron’s nebulizers were originally targeted to treat chronic respiratory diseases but their use expanded as people began paying more attention to their respiratory system. During the pandemic, the penetration of these products grew significantly due to the concerns people had but also as a result of our steady communication with doctors and commercial partners.
Q: Omron has been awarded the Top 100 Global Innovators Award for the fifth consecutive year in the healthcare category. What led to this distinction?
A: This award reflects Omron’s efforts to improve its technologies. We won it because of the improvements we made to one of our nebulizers, involving technical and in-depth innovations that began with our providers, who comply with Omron’s special quality requirements. The device has a better particle scattering, saves energy, is quieter and comes with interchangeable masks, among other components that provide patients a better experience and a more precise delivery of medication. Our goal is to ensure this innovation is available to both doctors and patients.
Q: How much potential is there in Mexico for Omron’s pain management line?
A: So far, the penetration of these solutions has been slow because knowledge about pain management in Mexico is limited. Our main task is to share the benefits of using these devices, which can provide an immediate improvement in the patient’s discomfort state. Aside from providing relief, our solutions can also help

relieve stress, reduce menstrual cramping and support athletes, among others. Through focus groups, we have identified that the main barrier for our product is poor understanding of the clinical support it provides. Among those who have used it, the majority have experienced its benefits immediately and we are the highest recommended brand by doctors.
Q: Remote patient care is a growing trend in the industry. How is Omron leading the way in this area?
A: With our remote care products, our goal is to transform the common care approach that only holds the doctor responsible for an outcome. Our products help divide the responsibility between doctors and patients by providing the latter with the right monitoring tools. This empowers the patient and creates a virtuous chain that encourages equal healthcare from both sides.
Q: Omron offers its personal devices for everyday checkups through Amazon. Why are these retail options important for the company?
A: This is an example of how Omron is reaching all e-commerce platforms to provide the patient with easier access to our technologies. This also allows the company to understand our user’s behavior. We focus on traditional sales methods but we also want to be present on e-commerce platforms due to our market studies of different patient profiles in Mexico. Moreover, e-commerce boomed during the pandemic so it made sense. Omron is as user friendly as possible during the purchasing process to support the patient’s decision. The products we have on e-commerce platforms are for diagnosed high-blood pressure patients or users who wish to track their health indicators.
Q: How does Omron include doctors in its solutions development process?
A: We have an area called Omron Academy that is focused on approaching doctors to ensure we are up to date with the latest trends in the field and that our products respond to their needs. We also share the knowledge we have gathered from our work in different countries. We educate doctors on our products and solutions so they can recommend the right tools to their patients.
Omron has alliances with internationally recognized groups of health professionals, including the British and Irish Hypertension Society, which have certified our products and data. The primary goal of these types of alliances is to be able to share the information we have and expand or create educational groups that deliver better results based on scientific data.

Alejandro Paolini President of AMID

Héctor Orellana Vice President North of Latam at Medtronic

Luis Fernández Co-Founder and CEO of TINC CMMS
Local production of medical devices is subject to consumption levels. A stronger local industry demands greater consumption as these products are normally manufactured directly at their destination. Industry representatives, large manufacturers and local entrepreneurs see further production and consumption as positive and achievable economic and health policies. Mexico Health Review asked industry leaders about their actions to boost the local medical devices sector.
Even now, with the UNOPS tender, we try to see all companies as equals. However, if we were to divide them, I do see a strong capacity among local manufacturers to escalate their production. There is a large market to be exploited that could be covered by the infrastructure and qualified workforce Mexico offers.
Medtronic is one of the strongest manufacturers of medical devices in Mexico and the country provides a relevant contribution to Medtronic globally, which supports our focus on local consumption. We try to find an entry point through the public and private sectors to ensure we are reaching all patients who need a solution. We firmly believe in developing high-end, state-of-the-art health environments in Mexico, equal to those in the US or the EU. Medtronic is a leader in the development of medical technology but we know that its value is only recognized when it benefits the patient. Medtronic is well aware of the key role medical professionals play in health systems. Therefore, we have also prioritized their training and education regarding our technologies, especially in this new digital era.
COFEPRIS’ quality is intentionally recognized but there are many improvements that could be done to foment innovation and develop technology locally. The lack of regulation is the main reason we have been unable to scale up our manufacturing abilities locally. Mexico has enough talent at universities for technology development, but escalating their products to the market is a titanic task. Moreover, Mexico lacks incentives to finance technology development in health. As an entrepreneur, I have experienced that raising capital for healthcare is almost guaranteed to fail as the return is much slower than investing on apps for other industries, which do not go through the same intensive approval process. Trials for medical devices are also difficult to perform because hospitals are not always open to volunteering for these trials because a single issue could damage their reputation.

Efficient Regulatory, Ethics Frameworks for Better Health
Alejandro Paolini
President of AMID
Cost-Effective Diagnostic Solutions for Smart Health Systems
Cristina Campero CEO of PROSPERiA
Alejandro Noriega CTO of PROSPERiA
Abelardo Vidaurreta
COO of PROSPERiA
Sterilization Requires Better Processes, Not Just Equipment
Jon Olabarrieta
Regional Director Latin America and Spain of Belimed
Leveraging AI to Improve Cancer Diagnosis
Teo Tijerina
CEO and Founder of Hera Diagnostics
The Future of Medicine: Robotics
07/06/2021
Digital Twins Disrupting Healthcare
06/25/2021
Interconnected Hospital Trend Drives Technology Adoption
Raúl Jacobo
Health Manager of CHG-Meridian Mexico
Initial Investment Is Crucial for Products to Reach the Market
Benjamín Morales and Antonio Ruiz
Co-Founders of Machina Innovation Lab
Remote Patient Monitoring Revolutionizing Care
06/24/2021
Home Care as a Long-Term Practice
04/20/2021

Supply chain actors have worked intensively to support their clients despite the crisis. Their product excellence and their planning outstripped the difficulties as companies were even able to introduce products and solutions to improve the course of drug-making and product tracing. Some of these innovations include microtaggant technologies that aim to end global health and organized crime threats.
Meanwhile, the logistics sector is enhancing its timely and cost-effective capabilities through technology integration. Providers in this sector explain why in Mexico, this digital integration is especially valuable to meet logistics needs.
Through the joint work of these sectors, there is an opportunity to exploit the country’s capabilities for nearshoring materials used by Mexico’s already strong pharmaceutical and medical devices industries. This chapter will unveil the innovative solutions of these providers and how they not only overcame the crisis but came out stronger and better qualified to support health provision.

72 Analysis
Nearshoring Opportunities for the Mexican Health Industry
73 Expert Contributor
Philippe Fournet-Fayard | CEO of Eolis America Latina
74 View From the Top
Gary Pond | Global Product Authentication Lead at Colorcon
75 Expert Contributor
Deyanira Chiñas | Commercial Director of T5DC
76 View From the Top
Leticia Zermeño | Commercial Director of Grupo CPQ
77 View From the Top
Erick Sabido | Commercial Director of Sartorius Mexico
79 Analysis
Technology Transforming Health Logistics, Supply
80 Conference Highlights
Counterfeit Drugs Threaten Health, Pharmaceutical Industry
81 View From the Top
Alesio Bereciartu | Commercial Director of the Healthcare Business Unit Latin America of OCASA
82 View From the Top
Rodolfo Camargo | Director General of El Crisol
83 View From the Top
Patrick Troop | Managing Director of Pharma Tycsa
84 View From the Top
Jesús Arenas | Corporate Communication Director at Maypo
86 Spotlight
DIBICO: FAMILY-LED SME INITIATES INTERNATIONAL EXPANSION
87 Content Links
Nearshoring has gained global relevance after the COVID-19 pandemic disrupted supply chain activity. Supply chains continue to work under several limitations compared to pre-pandemic dynamics. Within this context, finding new commercial partners and supply sources has become a necessity for essential industries that could not stop their activities despite the global logistic hurdles. Not all countries are attractive candidates for nearshoring activities. However, several elements make Mexico a reliable partner for these operations. First of all, the country has a specialized, skilled and cost-effective workforce. Its proximity to the US is boosted by close trade relations and the creation of USMCA, which according to Oscar Silva, Partner Leader of KPMG’s Strategy Group, will make Mexico a “trustworthy partner in the coming years,” especially after the trade fallout between China and the US during the administration of US President Donald Trump.
Ana Riquelme, Executive Director of AMID says that Mexico’s manufacturing capacities and good practices are also valuable assets for the medical devices sector, while the country works toward sustainable practices, gender equality and competitive salaries. “Companies are taking care of their talent and of their environment to remain a top choice.”
Mexico’s industrial and manufacturing sectors are strong on many fronts, from automotive to medical devices. However, even such strong industries could be strengthened by nearshoring suppliers. Prior to the COVID-19 pandemic, product and supply mobility did not seem to be a concern. But after a heavy and continuous supply chain disruption, several essential manufacturers had to source their raw materials from local companies. These disruptions resulted in price increases, longer delivery times for customers and a loss of competitiveness against other companies. According to many experts, Mexico is an attractive destination for nearshoring activities for companies that have facilities in established, nearby countries. In the healthcare sector, the medical devices industry is among those seeking these new alternatives.
APIs and medical devices assembly are Mexico’s largest nearshoring opportunities but API production costs remain a challenge. “Mexico has a strong pharmaceutical legacy and history,” says M.S. Nagendra, Director General of Zydus Pharmaceuticals. “But there are still opportunities and gaps in terms of technology and innovation. API production is one of those gaps as there are just a few local companies dedicated to their API production.” According to Nagendra, if the Mexican government encourages investment in API manufacturing, it would further strengthen the local pharma industry.
On the medical devices side, Riquelme says that to complement manufacturing efforts and boost the sector’s capacities, AMID is asking Clouthier to attract more final assembly processes to Mexico. To achieve this, however, Mexico would need to increase its medical devices consumption, as the final assembly is commonly done at the product’s point of sale to avoid damaging the device.

Philippe Fournet-Fayard
CEO of Eolis America Latina
The National Metrology Center (CENAM) is the national reference laboratory for measurements, which promotes uniformity of measurements in Mexico by way of comparison with traceability to a common reference. CENAM has a close relationship with national laboratories and international organizations related to metrology. This ensures the international recognition of national standards, as well as promoting Mexico’s products and services.
CENAM’s research and development activities are aimed at responding effectively to the growing measurement needs in all sectors. These include the advances in the traceability of temperature measurements for industrial and healthcare applications, the construction of one of the most accurate frequency standards in the world to support telecommunications and computing, as well as the development of a variety of certified reference materials to provide certainty to chemical measurements in the health, environmental and industrial processes sectors.
To enter the very select club of worldwide reference labs, the ambient conditions of the measurements become critical as their precision and stability are part of the global accuracy formula. The participation of Eolis America Latina in the project was to provide an integral solution for metrology laboratories, including high quality and accurate air conditioning systems in modules A, B and C of the Special Laboratories building, as well as the Acoustics Laboratories and the Laboratories of 3D reference machines. Eolis engineers worked closely with the users of these labs to create a custom design of each area. The scope of work was extremely wide, from design to commissioning, and included a cleanroom partitioning system, HVAC, energies, controls and BMS.
Eolis’ objective was the construction of 23 special laboratories for mechanical and electrical physics, including the national mass standard, density laboratory, gravimetry laboratory, nanometrology laboratory, Volt and Ohm laboratories, laboratory cryogenic, dimensional laboratory, national acoustic pressure standard, laboratory of tissue and cells and DNA technology laboratory. In addition, several of these laboratories had ISO 5, ISO 7 and ISO 8 cleanroom classifications.
The biggest challenge of the project was the integration of thermal inertia strategies in the HVAC systems to achieve a stability in the temperature and humidity of +/- 0.1 °C and +/- 5 %HR maximum in the national mass standard, density laboratory, dimensional laboratory and laboratories of the volt and ohm. Special strategies were implemented to cancel the noise and vibrations transmission from the MEP equipment to the laboratories and special air distribution elements designed with limited residual velocities of 0.2 m/s to improve the homogeneity of the temperature and avoid disturbances in the development of the experiments. Elements were integrated into the construction to prevent the penetration of electromagnetic waves from the outside to the inside of the electrical laboratories, such as Faraday cages. Every function of the HVAC system was been specially designed for the purpose, all equipment was specially manufactured and the fine-tuning of the control system took several months.
This project has been a complete success. It allows CENAM to enter the very exclusive club of Certified Metrology National Institutes, along with the LNE in France or the NIST in the US. It is now in the Top 5.

Global Product Authentication Lead at Colorcon
Q: What makes Colorcon’s specialty excipients superior to those of the competition?
A: Colorcon is the global leader in film coating for the pharmaceutical and nutritional sectors. Our best-in-class products and technologies are complemented by our extensive application data and value-added services to support all phases of solid oral dose design and development. We deliver superior product quality, unparalleled technical support, extensive regulatory assistance, and reliable supply from multiple locations. Our focus on market issues and technology development has earned Colorcon an international reputation as a pharmaceutical supplier of choice. That reputation is based on superior product quality, unparalleled technical support, extensive regulatory assistance, and reliable supply from multiple locations. Colorcon has a global supplier capacity through its 22 technical service centers and 11 global manufacturing facilities around the world.
We were the first company to develop a fully formulated tablet coating system, Opadry®, for the pharmaceutical and nutritional industries and we provide companies with a range of specialty ingredients (excipients), for oral solid drug products and nutritional supplements.
Q: What is the impact of counterfeiting drugs for the pharmaceutical industry?
A: Counterfeit drugs are a growing, relentless problem. Even though some clients have serialized their production in some countries, they are still seeing a significant increase in counterfeit and diverted drugs. Recent data show that due to the growth of illegal online pharmacies, the problem has worsened as the COVID-19 crisis makes more people buy online. Counterfeit drugs are not just a problem in developing markets; there is a lot of counterfeiting and diversion of products now through illegal internet pharmacies in major markets like Mexico, the US and the EU. Counterfeiters are also becoming much more sophisticated and are moving from high-value, and lifestyle products (like Viagra), which were previously their primary target. They are now going after some life-saving medications as in many cases, they are more expensive, and patients can buy them online at a lower cost. Patients are increasingly buying online medicines for cancer, heart disease, or diabetes.
Q: How can Colorcon protect companies from the dangers of counterfeit drugs?
A: While companies in some countries are required to implement serialization on their packaging, a product can easily be separated from its original packaging or the packaging can be copied. We developed covert microtaggant technologies, a molecular DNA taggant and a silica taggant, which are included directly onto the tablet itself via the film coating, undetectable by the naked eye. This covert marker is then verified for the authenticity of the tablet. Companies can include on-dose authentication with little change to their typical film coating manufacturing process, as microtaggants are added directly into the coating system. Companies are now able to uniquely tag their tablets and authenticate them using a desktop reader. A smartphone application is under development which will broaden access and bring smarter medicine capabilities forward, leading the way for wider digitalization of medicines.

Commercial Director of T5DC
On May 27, we received an invitation from the General Health Council of Mexico, extended by its secretary, Dr. José Ignacio Santos Preciado, to assemble all the government, academic and industry agencies involved in the Mexican pharmaceutical industry. The main reason for the gathering was to establish in definite form the National Pharmaceutical Policy (PNF). Efforts have been made to establish such a policy since 1988 and today, 33 years later, it is not yet a reality.
The difference with previous attempts is that today we need to integrate the epidemiological reality in the country that has affected us severely, so regulators, service providers, and industry have been summoned alongside its associations, foundations and academia; all the institutions that are committed to training the next generations that will study and address the needs of the country.
The importance of the PNF today is critical; for this reason, it is indispensable to open this national forum and identify the main problems that trouble our population. Through this forum, we will be able to define a national strategy with all sectors involved so that at last, we can express and establish mid- and long-term goals. In the national development plan 2019-2024, it was established that the entire Mexican population should receive free healthcare, including medication supplies, healing products and clinical analysis.
All of us know that the last two years have been a difficult period defined by shortages of medications and materials throughout the entire health sector in Mexico. We have witnessed public demonstrations due to the absence of critically necessary medications, like cancer medications for children. Also, there has been a scarcity of equipment and materials in ICUs because of the COVID-19 pandemic, which has surpassed by a great deal the installed capacity in the health sector. For these reasons, there has been an incremental and significant loss of human lives in a very short period of time, and also why we were not able to react appropriately.
The pharmacists integrated into the national organizations that were summoned have a crucial commitment to the elaboration of this policy; the experts who will be integrated into the different work tables actually work in all the institutions of the government that were summoned as well as in the pharma industry and in research centers. It is also noteworthy to mention that a communication issued by the Netherlands at the Hague on March 25, identified pharmacists as professionals who are systematically named as the most trustworthy in the world, along with educators and finally, scientists. For this reason, it is important to emphasize the following sentence: “Pharmacists, educators, and scientists: That is our pharmaceutical profession,” said the president of the FIP, Dominique Jordan.
We will have the opportunity to demonstrate the pharmaceutical profession’s commitment to the trust placed in it and increase the awareness of the vital role of pharmacists in the betterment of health. In Mexico, we accept this challenge with our involvement in the elaboration of the National Pharmaceutical Policy in benefit of the health of our population.

Q: How did Grupo CPQ deal with global supply chain disruptions during the pandemic, given it has a portfolio of 900 products?
A: The unprecedent challenge demanded an extraordinary response from our team. The expertise of our people together with close communication with our commercial partners including suppliers and customers helped to minimize the impact of the disruptions. One cornerstone was the stock storage in our distribution center located in Jalisco, which helped us kept an acceptable filing rate to our customer’s demands.
Q: How did the pandemic affect demand the company’s pharma, R&D and care areas?
A: Demand depended on the therapeutic area. Some of our products saw a 200 percent increase in demand while others were on standby. Pediatric drugs or treatments for common ailments, for example, faced weak demand because children were staying home most of the time. On the other hand, our antibiotics, corticoids, vitamins and antidepressants ingredients were our bestsellers. Other items indirectly related to COVID-19 also increased in demand, such as those to treat metabolic issues because the lockdowns generated sedentary habits
Q: Grupo CPQ works closely with generics manufacturers. How have the changes to the centralized purchasing scheme impacted supply?
A: Facing a new acquisition system forced us to improve and innovate. The industry is open to embrace the challenge and prove that Mexico can compete against other pharma clusters in the world. A fair ground for all players will be fundamental to guarantee quality medicines to the population and clear timelines and rules will help us focus our efforts on remaining competitive in cost, deliveries and quality of our products.
Q: How is Grupo CPQ integrating technology into its internal performance?
A: Grupo CPQ integrates technology into our warehouse processes and inventory to deliver the best distribution results and avoid disruptions. The continuity of our business would not have been possible without a technological shift. In terms of the pandemic, we have implemented virtual office and communications with our clients. Our communication with clients is essential to anticipate and prepare orders and we have achieved that just as well in the digital era. Webinars have been an effective communication source for our clients. They have also been of great use for the development of our staff. We also participate in virtual forums and we have noted their impressive reach in terms of audience.
Q: What are your views about the functionality of nearshoring for the pharma and chemical sectors in Mexico?
A: Health is a priority for all countries. I think the government should create a program to encourage and support a strong national pharma industry to face health challenges. Mexico should be prepared and not rely completely on foreign suppliers. It should encourage the local production of active pharmaceutical ingredients aside of the already well-developed manufacturing of medicines. The safety of our population should not be compromised.

Q: What has been Sartorius’ role during the COVID-19 pandemic and how have you helped during the research and production of the vaccines?
A: The role of Sartorius has been that of an essential supplier for the development and production of the COVID-19 vaccine. As collaborators to the industry, we have strengthened our supply chain by increasing the manufacturing capacities of the company’s sites around the world and positioning ourselves as the first option for the biopharmaceutical sector and the vaccine industry.
Our solutions target the needs that range from laboratory to production. For the COVID-19 vaccine, we are providing expedited solutions, mainly in the manufacturing and quality control processes with laboratory and production equipment and single-use consumables. Currently, we are collaborating with several companies in Mexico on the final step of fill and finish of the vaccine and some of these companies are working already on the process development and production of the vaccine.
Q: What does your innovation process look like and how do you ensure this innovation reaches researchers and stakeholders?
A: Sartorius has very robust technologies for the production of vaccines and biotherapeutics. We have technologies for upstream and downstream processing, providing solutions with end-to-end platforms. Our focus ranges from R&D up to commercial manufacturing, including products for quality control and validation services among the most comprehensive portfolio in the market.
Q: How do you ensure all your practices are carried out in a sustainable manner?
A: One aspect of our sustainability value offer is to provide cost-effective solutions. Our goal is to provide quality products that represent cost savings in operating expenses. This has been particularly relevant throughout the course of the pandemic for the biotechnology and pharmaceutical sectors.
Regarding environmental sustainability, pharmaceutical production with single-use products frequently consumes fewer resources than traditional production using stainless steel equipment. Single-use products can thus significantly reduce the environmental impact of biopharmaceutical manufacturing processes.
Sartorius rigorously considers the environmental footprint of its single-use products in all their life cycle phases as early as the product development stage: The materials used are carefully selected to keep their impact on humans and the environment as low as possible.
The plastics consist of recyclable standard polymers and contain few additives. Whenever technically possible, the materials meet Pharmacopeia requirements. All materials can be safely burnt and used as energy. We also have several initiatives inside our plants to reduce CO2 emissions.

Q: Most of your research solutions focus on basic research. How do you bridge this basic research to a translational or clinical level?
A: Part of our mission is to empower scientists to simplify and accelerate progress in life sciences and bioprocessing. We want to provide better solutions for the development of therapeutic agents and to make these therapies more accessible for the general population. We develop equipment for lab solutions and innovative systems for bioanalytics used in drug discovery of monoclonal antibodies, as well as for cell and gene therapy.
Our solutions help expedite the development process and bring more molecules to the market. We have also established several alliances with research centers around the globe to ensure these goals.
Q: What opportunities do you see for Mexico to grow its position in pharmaceutical research and production? How can Sartorius support these efforts?
A: Mexico faces significant challenges and needs to direct more resources to R&D in the biopharmaceutical industry and the research centers. Many universities and research centers need to accelerate their tech transfers to the industry and start production for clinical phases and ensure medicine supply.
The tripartite arrangement between the government, private industry and research centers needs to establish agreements for common goals that help optimize this entire process. Sartorius collaborates closely with several research centers in Mexico in order to make these progress possible. All this collaborative effort resonates with our mission statement.
Q: How has Sartorius improved the medical supply chain in Mexico for both the private and the public sectors?
A: We have almost 21 years of experience in Mexico and we have grown together with the relevant industries in the supply chain. We have strengthened the output capacity in our plants, having doubled or even tripled our output in recent times.
We have substantial stock for our customers and we provide agile deliveries and cold chain services. This has been possible in part because of our storage capabilities in our facility in Tepotzotlán, State of Mexico and also because of the strong collaboration with our logistic partners in Mexico and around the world.
Read the complete article More about this person
Technology adoption has been a key trend across the healthcare industry. As the sector moves toward a value-based system, logistics and supply chain management technology becomes essential for companies to streamline processes and thrive in a demanding environment. “Thanks to technology, we can generate the necessary solutions, redesign of routes, calculate the demand levels of our customers and generate the services they require,” says Ingo Babrikowski, CEO of Estafeta. “Today, logistics companies are information companies as well.”
The logistics industry has already demonstrated its leadership in tech disruption. Amazon’s fast-paced delivery service is testimony to how fast and efficient deliveries can be through the use of integrated shipment-tracking systems, IoT sensors linked to monitoring and information transmission systems, autonomous trucks and drones, enhanced GPS systems and even social media to connect with customers. These tools can be easily adapted to different sectors. However, their use in healthcare involves additional complexities to fully respond to care provision while reducing cost without compromising care.
A study by Deloitte points out the primary goals of health providers in optimizing logistics and supply chain operations: optimizing costs; reducing unnecesary variation; enhancing patient care, delivery and engagement and addressing new value-creation priorities. For their part, logistics and supply chain actors have adapted diverse digitalized solutions to their already existing services. According to the carrier and freight-forwarder Logistics Titans, these include: Artificial Intelligence (AI); IoT applications to collect, analyze and visualize data and traceability through product tracing. “Traditional logistics have become a commodity but accurate, real-time information is what differentiates a company from others,” says Alesio Bereciartu, Commercial Director of OCASA’s Healthcare Business Unit Latin America.
One concrete example of how these tech applications are working out for the healthcare industry is GNK Logística’s medicine distribution process. The company developed a software system called Administration and Logistics System for the Health Sector (SIALSS), which is installed at hospital warehouses, regardless of whether they are in large cities or rural communities. This system allows GNK Logística to measure the real consumption of the facility. “This has given authorities real-time information that allows them to create accurate consumption plans for future purchases,” says Javier Calero, Vice President Commercial of GNK Logística.
Mario Alberto Aguilar, President of Mexico’s Association of Logistics Operators, adds that the COVID-19 pandemic will undoubtedly cause traditional supply chains to change. He says there is a great need, while maintaining economies of scale, for a more distributed, coordinated and traceable supply of components across multiple geographies and suppliers. “This would require the creation of global platforms that use sophisticated technologies such as 5G, robotics, IoT and blockchain to help to reliably link multiple buyers through a ‘mesh’ of supply chains with multiple suppliers.”

Gary Pond
Global Product Authentication Lead at Colorcon
The globalization of medicine trade has led to the growth of pharmaceutical counterfeiting, a significant threat that puts millions of patients at risk but has been largely unaddressed. Analytical authentication technologies are some of the most effective methods to identify APIs and impurities but most of these techniques are expensive and require highly-skilled staff.
“Whenever a person does an online search for medicines, around 50 percent of them are led to a fake website,” says Gary Pond, Global Product Authentication Lead at Colorcon. Drug counterfeiting costs about 1 million lives per year, he says. For the global pharmaceutical industry, the problem results in losses totaling US$200 billion per year. Moreover, the COVID-19 pandemic led to an exponential increase in the false postings of medicines on website. The pandemic also made criminals bolder. Eight months prior to its development, a supposed COVID-19 vaccine was already being offered online. “In Mexico, a fake Pfizer vaccine was identified in the market recently. The problem is that these fake drugs do reach the market.”
Despite of the numbers and the known dangers of counterfeit medicines, the problem grew by over 70 percent from 2015 to 2019. “This is a low-risk, high-reward activity, with very low penalties and with free access to high-technology to carry it out.” According to Pond, there are over 600 illegal pharmacies entering the market each month. Mexico ranks sixth in the Top 10 illegal medication markets and about 60 percent of the medicines sold in the country are stolen, expired or falsified, according to AMIIF. “The measures agencies take to prevent counterfeiting are already being evaluated, as everything is focused on packages,” says Pond.
“Current tracking protections are always on the secondary package, rarely on the primary package and almost never on the tablet itself.” Pond explains that this secondary-package protection can be easily falsified. To address this problem, Colorcon has developed an On-Dose Authentication Compliments Serialization called Soteria RX, which is a covert microtaggant, a molecular DNA taggant and a silica taggant incorporated directly onto the tablet via the film coating. SoteriaRX is a tagged film coating with invisible taggants, containing coded information, placed into Opadry film coating or primary packaging inks. Its detection method is decoded and read by custom software using a desktop reader or standard smartphone. “These solutions are easy to adopt in existing Opadry Fil Coating, as it already has the taggant mixed in it, so the coating process does not have to change and there is no major investment required in the manufacturing process of the tablets,” explains Pond.

The taggants can be detected through a PCR machine or a Portable PCR that can be connected to a phone. Pond says that a smartphone application is under development and will broaden access, clearing the way for the wider digitalization of medicines. The app will take a picture of the tablet and determine if it is real or not in seconds by reading a customizable message by the manufacturer of the drug. The app can also include patient support reminders to ensure they follow their treatment and give them information about the product. “The microtaggant we are utilizing is described by the FDA as a physical-chemical identifier (PCID) and the agency recommends using these technologies in addition to serialization,” says Pond about the regulatory status of the development.

Q: How has technology been a differentiator for OCASA’s specialized services?
A: Last year was marked by many changes and technology allowed us to move at a faster pace than usual, from a management standpoint to the way we operate. OCASA integrated technology solutions that provided the client with the opportunity to have real-time tracking of their logistics process. The company was already adopting digital trends prior to COVID-19. When the pandemic arrived, we were one step ahead and ready to live up to our clients’ high expectations.
Our real-time tracking in direct-to-patient and direct-frompatient services for the health division made a significant difference to our clients and their patients in Latin America. For the direct-to-patient service in particular, we collected COVID-19 test samples to reduce the risk of contagion and overcrowded hospitals that would have arisen if patients had delivered their own samples. Using the same logistics service, we are benefiting the client, patients and the health system.
Through direct-from-patient services, OCASA supported companies involved in vaccine development by collecting the samples from the patient and delivering them to the company’s central labs, which could be in a different city, state of even country, requiring that we have the right capacity to comply with their process.
None of these services would be possible without a good performance system propelled by technology, including perfectly functional communication, order reception and process and timely supply delivery. OCASA is managing specialized delivery services to the different geographic areas of Latin America despite the logistical challenges.
Q: OCASA doubled the volume of its general deliveries during the COVID-19 pandemic. How much did the company’s health division contribute to this growth?
A: OCASA’s health division contributed to this growth from several fronts, including the large number of clinical studies we supported, vaccine supply distribution during their development process and vaccine distribution once approved. OCASA received and transported vaccines from several pharmaceutical companies in various countries. We received the vaccines at international airports and delivered them to the countries’ designated warehouse. We also transported them to different states or provinces according to the government’s provisions for each location.
For a vaccine, the entire logistics process begins once it leaves the production plant. In the EU, for example, it is shipped with real-time tracking to the airport, where our monitored transportation service will receive, register, load and secure it with the support of the national government (depending on each country) to deliver it to the final point. This involves an extensive documentation process. One of the most outstanding aspects of these deliveries is the level of national security involved in the transportation to the final delivery point and this is where OCASA’s real-time tracking plays an essential part.

Q: How has your e-commerce platform boosted sales results?
A: We have experienced continuous growth since launching our e-commerce platform, which was almost at the same time as the COVID-19 outbreak. We were able to collect market information to create better approach strategies for our clients. We also have been more efficient in our product offering and logistics, adapting these to the needs of our clients. We continue to invest in the platform, primarily in software, to improve it and achieve better sales outcomes.
The e-commerce platform began with 3,000 products available for purchase. Now, we have 9,000 but the final goal is to reach 13,000 SKUs. This growth is reflected in a higher number of client visits. The platform has also helped us to close more sales. Having the ability to view the product online gives clients a better perspective of what we offer. We have also approached clients through webinars and digital conferences, which have turned out to be very effective.
Q: What is the status of your expansion plans scheduled for 4Q20?
A: 2020 was an atypical year. For the company, it meant a higher amount of work due to the nature of the crisis. Demand for cooling products and PCR components reached a record high, which drove us to increase our investment in those areas.
We are in the litigation process for the construction of our CEDIS in Queretaro. This 2ha project is being developed handin-hand with new subsidiary openings, one in Tijuana and the other in Culiacan that will open in 2Q21 and 3Q21, respectively. These facilities will mainly focus on the food and beverages and chemical industries, which are very strong in the north.
Last year, we also decided to acquire Científica Senna, which will boost our life sciences division. The acquisition of Científica Senna expands, strengthens and specializes the presence of El Crisol in the research market adding synergies and experience between the extensive inventory, geographic coverage and the diversity of brands with the specialized commercial team required by the market life sciences, thus contributing to the more than 60 years of experience of El Crisol. This company focuses on cellular biology, molecular biology, biotechnology and biochemistry. Through this action, El Crisol is reinvesting its profits from last year and expanding its offer. The COVID-19 virus is likely to remain a threat for the next two years at least and the mutations it presents will drive our sales. This will couple with growing concerns regarding healthcare, which is finally being prioritized.
Q: What is El Crisol’s approach to attract more clients?
A: Social media has been one of our main channels, which is also complemented by our sales agents, who visit clients when they are able to do so. Additionally, we are very active on LinkedIn. El Crisol is also mindful of SEO to be a top choice on Google’s search engine without having to pay for preferential positioning. Through our recent company acquisition, we are adding a client base of around 300 niche clients, which is also beneficial and different to what we are used to, as this will be a more specialized approach.
Patrick Troop

Managing Director of Pharma Tycsa
Q: How has Pharma Tycsa expanded its compounding centers throughout the country?
A: Pharma Tycsa is present in nine states where we have been working on mixing components for oncological and nutritional treatments. Pharma Tycsa works with both the public and private sectors and we see a great deal of opportunity to explore and expand in this segment to benefit patients with safe therapies. Moreover, we are constantly seeking to add value to infusion processes to guarantee safe and accessible treatments.
Pharma Tycsa has been working on a home-care infusion center. As a result of the COVID-19 pandemic, we have seen that patients in need of these treatments have stopped visiting their hospital or clinic out of fear of contagion. Our commercial partners, such as laboratories, have also stopped following up on these kinds of treatments so we are working together to find ways to bring infusion to the patient’s home. This is common in other countries and now Mexico can explore its benefits too.
Q: How has Pharma Tycsa consolidated its traditional treatment distribution channels for the public sector?
A: There had been a quick and significant change in the sector even before COVID-19. The government has introduced many reforms to the sector, from creating INSABI to distribution alternatives. This has increased sales and requisitions from local health institutes and it has been very complex to personally attend to each client. Unlike the former centralized purchasing scheme where the provider scheduled a delivery time and methodology, now there are few centralized contracts, meaning that every local dependency has to find ways to purchase its supplies. This has affected the requirements they would normally ask suppliers to comply with and has left us with an increased number of institutions to answer to, which involves high administrative, operational, commercial and logistics costs. As long as the government does not centralize its purchases, this scenario will continue.
Q: What changes did COVID-19 bring to Pharma Tycsa’s services?
A: Pharma Tycsa supplies specialized prescription medicines. We have noticed that patients have stopped their regular medicine purchases for treating their chronic conditions. This is a very serious matter as chronic diseases severely progress over time and pausing treatments can cause irreversible consequences to their health, leading to much higher costs. We have been working on ways to provide these treatments without having the patient visit a medical facility. Building a logistics response to this has a cost but we are presenting economic models to a variety of institutions that provide such treatments to encourage them to continue to do so. Working with different institutions has been challenging because they are focused on saving money and supplies. Nevertheless, in the future this will mean greater costs due to the progression of the disease.
The current government is very focused on savings, meaning that investment in the short term is not so well-received. We have worked on presenting how much the costs will increase in the future if chronic diseases progress based on our results working with a medium-size state. These results show that six out 10 people who consumed medicine for a chronic disease stopped doing so because of COVID-19.

Q: How can the pharmaceutical value chain help increase access to healthcare while running a successful business model?
A: To succeed in the current healthcare environment, all companies must reinvent themselves. Article 4 of the Mexican Constitution ensures the right to healthcare. For that to be possible, all public healthcare entities must receive the proper medicines. INSABI was created to achieve this constitutional mandate but the medicine distribution process implemented to meet its needs has faced significant challenges that has led to shortages.
To deliver the extraordinary medical supplies required by the government, which is around 2 billion units per year, suppliers must be able to distribute to the four public health institutes in the 32 states of the country. This is highly complex and technology plays a large supporting role for providers, distributors and public institutions.
Q: How is Maypo using technology to support its logistics and distribution processes?
A: Distribution companies need to plan their logistics after analyzing the yearly consumption of every type of medicine or healing material they manage. To do so, they need constant communication with clients to determine the average monthly consumption, while considering the ongoing situations that each state or institution is facing. For example, the State of Mexico has at least 500 delivery destinations and all these sites have the same consumption trends. This average allows suppliers to determine if a weekly, biweekly or monthly delivery suits their needs. When companies manage large numbers of orders, with around 20,000 delivery points and 50,000-60,000 invoices and document processes, technology becomes essential and allows us to optimize the cost-benefit ratio. Not giving this process the necessary attention can compromise the supply to the population. We have to keep in mind that we are dealing with medicines and healing materials, which are some of the most complex products to distribute.
Maypo has carried out these processes for years, which means we understand their complexity and why we adopted technology to meet demand. Technology has allowed us to keep track of inventories, consumption trends and placed orders, among other critical aspects of a successful medicine distribution. Maypo’s communication and data analysis facilitates our processes by providing us an even more precise panorama of our distribution network. We are also able to link with our clients’ data through an RP (Revolutionary Preservation) system that allows warehouse and inventory control. Real-time stop-by-stop tracking of medical shipments; monitoring, tracking, and documentation of environmental conditions during transport.
Maypo has five major warehouses fully equipped with a picking and packing system with temperature-sensitive medication. We also have a collection system for our operators that allows us to minimize errors. Another warehouse has a picking system to pack the orders. These automated solutions have reduced errors and packaging times.
Q: How has the switch to UNOPS changed the medicine supply around Mexico?

A: The inclusion of UNOPS was meant to increase access but its implementation presented considerable delays. The new scheme excluded logistics companies from the distribution process of medicines, so manufacturing companies had to fulfil the distribution themselves. To close the gaps that appeared during the implementation of this process, it is necessary to take logistics companies into consideration because we have the experience, infrastructure and capacity to supply medicines. UNOPS and INSABI can audit the companies willing to participate in the new distribution process and they should be open to a collaborative effort.
Maypo’s experience in Mexico’s pharmaceutical supply chains shows that the country has companies with the capacity to be an active partner in the distribution process, from planning to execution. We have only been consulted; there has not been a true approach to the private sector. We stress the importance of collaboration between companies and the government because we know we can meet their expectations for capacity and transparency, which is what they are seeking.
Q: How has Maypo’s commercialization service supported pharmaceutical companies entering the market and to enhance access to therapies?
A: The medicine purchase process changed when UNOPS entered the equation. The process has one single buyer, which is INSABI in representation of all health institutions in Mexico, so suppliers have to fulfil larger orders than when sales were divided by institution. This is more costly for companies because the cost of direct distribution to a remote state might be more expensive than what they are getting paid for the units.
Maypo is now helping companies commercialize their products by providing collection and storage to then prepare and distribute them. We also support their administrative processes so they are able to join the tender, sell, deliver and collect their payment. Maypo has become an end-to-end company for Mexican and multinational pharmaceutical laboratories, as the change in the acquisition process included an open participation of multinational companies that previously could not access the market.
Our experience has placed us at the top of mind of both local and international laboratories. For example, we have represented Gilead Sciences and other multinational companies, which puts us in a privileged position when other companies want to enter this market. Maypo has a strong compliance area and a respectful working environment. We went from 900 associates in March 2020 to over 2,000. We now have 40,000m2 of pharmaceutical warehouse capacity.

DIBICO has more than 40 years of experience in the market of microbiological culture media. The company was born from the initiative of three young entrepreneurs from Instituto Politécnico Nacional specialized in bacteriology and industrial chemistry. It now serves the clinical diagnostics, research and academic institutions, as well as pharmaceutical, food and beverages, cosmetics and water treatment industries, among others. As a Mexican, familyled SME, DIBICO’s growth is a result of product consistency, quality services and strict regulatory compliance. Good practices and flexibility have also allowed DIBICO to grow its infrastructure, and the company is constantly developing new products to deliver a tailored response to its customer needs.
DIBICO supplies leading players like Genomma Lab, Kimberly-Clark and P&G. DIBICO can support its customers in their efforts to reach local and international markets. DIBICO has also become a supplier for Mexico’s top pubic healthcare providers IMSS and ISSSTE. Its multisectoral approach and supply capabilities have allowed the company to target companies like TEVA Pharmaceuticals. “Complying with the regulatory and technical requirements of local authorities, as well as those of large multinationals, has been a challenge. However, this never-ending journey has been very rewarding,” said Luis Gabriel García, General Manager of DIBICO.
Amid the impact of the COVID-19 pandemic, the culture media market grew 6.9 percent, according to recent studies. Within this evolving ecosystem, quick and quality responses are required from suppliers. García says that this is where DIBICO’s capabilities as an SME were tested.

PAMO Doctors Trained to Approach COVID-19 Cases
Santiago González
Operations Director México of Farmacias YZA
Precise Cleaning Engineering for Production Lines
Henry Ederle and Massimo Desol Borer Chemie
Unique Market Provider with Ambitious Regulatory Compliance
Antonio Martínez Sales Manager of Sefar
Maintaining Quality Through Innovation
Ouali Madjid
Head of Latin America and Caribbean Industrial Measurements Division of Vaisala
Powder Handling Complexity Resolved
Frederic Dietrich CEO of Dec
Accessible Medicine Distribution Through Pharmacy as a Service
Emiliano Hernandez Laos CEO and Founder of PAAS
Sales Channels Transform During the Pandemic
Alejandro Jaime and Gloria Higuera GoFarma
Patient Support Programs Foment Positive Treatment Outcomes
Juan Carlos Carranco Director of Business Operations of Grupo Consulmed
Import Processes Get in the Way of Fighting COVID-19
07/27/2021
Key Steps for the Efficient Delivery of COVID-19 Vaccines
07/14/2021

The endgame in healthcare is to establish a preventive health culture. This goal became even more prevalent when the pandemic exposed the vulnerabilities of poor health conditions and how different systems responded to the crisis. COVID-19 arrived in an already sick country, with obesity, diabetes and cardiovascular disease rife among the population. This, among other factors, led to worse outcomes, higher mortality rates and will likely have a profound impact on Mexico’s economy.
The Mexican healthcare system is highly fragmented and segmented, which leads to difficulties in ensuring universal coverage and adequate access to health services. Moreover, care practices have been characterized by being primarily reactive in their approach. To date, not only do health providers allocate very few resources to prevention practices but every education and training opportunity focuses on healing, curative or corrective care.
In this chapter, care providers will highlight the importance of prevention and its focus on people’s physical, mental and social well-being. Companies share their efforts to establish primary prevention among their patients, while trying to shift their “business-as-usual approach” to a more sustainable model that requires not only different practices and products, but a contextualized vision that considers the impact of socioeconomic realities and how these shape health outcomes.

Javier Potes | Director General of Consorcio Mexicano de Hospitales (CMH)
Miguel
Gustavo
Horacio
Zoonoses, Pandemic Preparedness and One Health
View From the Top
Alejandro Gil | Director General of Centro Médico Puerta de Hierro 102 View From the Top
José Solís-Padilla | Senior Manager for International Business Development at Mayo Clinic 103 View From the Top
Fernando Santiago | Director General of MAG Medical Group
How Are You Promoting Preventive Practices and Integral Care Approaches?
View From the Top
Juan Zamora | Director of Laboratorio Médico Polanco 107 Expert Contributor
Juana Ramirez | CEO and Founder of Grupo Sohin
Content Links
The main preventable causes of death, which cost 53 percent of years of life lost in Mexico, were:
• Diabetes
• Perinatal deaths
• Ischemic heart disease
THE ROLE OF PREVENTION
+ Heart disease: A reduction in deaths from cardiovascular diseases has been achieved through greater prevention (reduction in incidence), earlier detection and more effective treatments (higher survival rates).
+ Diabetes mellitus: Type 1 diabetes is not preventable but appropriate treatments can reduce mortality. Type 2 diabetes is largely preventable and appropriate treatments can also reduce mortality.
+ Influenza and pneumonia: Influenza can be prevented through vaccination. Pneumonia fatality rates can be reduced through early detection and appropriate antibiotic treatment.
+ Liver disease: Can be prevented by improving habits, reducing alcohol consumption, early diagnosis and treatment.
+ Cerebrovascular diseases: Reduction in deaths has been evenly achieved through greater prevention (reduction in incidence), earlier detection and more effective treatment (higher survival rates).
+ Chronic obstructive pulmonary diseases: Case-fatality rates can be reduced through appropriate treatment.
LEADING CAUSES OF DEATH IN MEXICO IN 2020
Sources: INEGI, OECD
When COVID-19 arrived, Mexico was already a sick country, with obesity, diabetes and cardiovascular disease rife among the population. This, among other factors, led to worse outcomes and higher mortality. It could also have a profound impact on Mexico’s economy. What could have been done differently to face COVID-19 and what can be done to ensure that subsequent health crises do not hit the country as hard?
The Mexican healthcare system is highly fragmented and segmented, which leads to difficulties in ensuring universal coverage and adequate access to health services, according to the Inter-American Development Bank. Moreover, its care practices have been characterized as being primarily reactive in their approach. Mexico’s health reality is also different depending on the region. For example, there is a substantial difference between what ails the southeast and what ails the north of the country. This polarization is also fueled by geographical, societal and individual differences, such as purchasing power, gender and ethnicity. These conditions are social determinants of health (SDH), as defined by WHO, which play a paramount role in the health-disease processes that people go through.
Healthcare systems, in general, have historically aimed to identify diseases and subsequently treat them. Mexico is no exception and the domestic health system has mainly dedicated its efforts to providing diagnosis, treatment and rehabilitation in some instances. Only recently has Mexico started doing preventive work. “It is time to reevaluate the role of private health ‘investors’ beyond each country’s ‘Healing Systems’ (incorrectly named ‘Health Systems),” writes Javier Picó, partner at LifeSciences Consultants, in an MBN contribution.
When analyzing the evolution of health problems through time, a trend appears: improvements in infrastructure and sanitation bring about a decrease in infectious diseases, which leads to an increase in life expectancy. This, however, results in negative consequences in other aspects, like cardiovascular and metabolic disorders.
Mexico is going through its shift toward a higher prevalence of chronic diseases as cardiovascular and metabolic diseases become the main culprits of rising disease burden, which is the impact of a health problem in a population measured by financial cost, mortality, morbidity and quality of life (QoL).
Prevention remains a handy tool not only in the mitigation of current problems but in ensuring a reduction in future ailments. Taking the case of a person with a significant genetic predisposition for insulin resistance, it is possible to determine different scenarios in terms of treatment:
1. Nothing is done and the natural course of the disease runs unaltered.
2. No measures are taken to ensure that the person does not develop diabetes but complications are treated and rehabilitation is offered.
3. No measures are taken to ensure the person does not develop diabetes but some measures are taken to modify the course of the disease. This is the current approach of the Mexican health system.
4. The person takes specific individual actions to reduce the likelihood of developing insulin resistance.
5. Environmental, societal and individual actions are taken to reduce external factors that may lead to developing diabetes, facilitating personal changes to reduce the likelihood of the disease.
These different approaches reflect different levels of action regarding prevention. The current academic literature identifies four types of prevention. The first scenario corresponds to complete inaction, which equates to not having any access to health services throughout life. The second scenario corresponds to what is known as tertiary prevention, which aims to soften the impact of an ongoing illness or injury that has lasting effects. The third scenario corresponds to secondary prevention, which involves actions directed at detecting diseases earlier and trying to halt their progression to reduce the impact that would have otherwise occurred. The fourth scenario reflects primary prevention, involving all actions aimed at reducing the likelihood of disease arising in the first place and, as INNSZ’s Director Dr. Kershenobich says, “Considering that we have different levels of prevention, we require an approach that includes actors beyond medical professionals.” This is one of the most compelling scenarios for improving outcomes and optimizing healthcare spending. Savings come from fewer people needing treatment and fewer still developing complications.
The fifth scenario does not correspond to a level of prevention; it instead reflects health promotion efforts. These try to address the root causes of ill health by bringing forth healthier environments and social dynamics that would make primary prevention easier, if not the norm. While this approach is the costliest, it is also the one that saves the most direct spending on health. Its costs come through investing in intersectoral policies to improve SDHs and would be helpful towards other policy aspects not directly related to health.

Guillaume Corpart
Managing Director at Global Health Intelligence
Jaime Fragoso
Director of Processing Centers
of LMP
Fernando Cruz
Country President and Head of Corporate Affairs and Communication at Novartis Group Mexico
Gabriela Allard
Apreventive approach to healthcare can benefit patients’ life quality and the overall economy, experts say. A few years ago, Novartis took part in a study on the impact of preventive medicine in Guanajuato’s automotive sector. The results were astounding: health absences and ill people going to work cost the sector 7.31 percent of its contribution to GDP. “This is just one sector in one state. At the national level, the benefits of preventive medicine can add up to many GDP points,” says Fernando Cruz, Country President and Head of Corporate Affairs and Communication in Novartis Group Mexico.
President
of Mexican Diabetes Association
In Mexico, preventive medicine is not a priority and it requires a considerable number of resources from private and public healthcare entities. “Traditionally Mexican patients only seek healthcare services when the disease is already presenting complications. To address this, primary care should change to focus on population groups that are most likely to get ill but are not aware,” says Jaime Fragoso, Director of Processing Centers of Laboratorio Medico Polanco. According to public records, diabetes is the leading cause of death in the country. If prevented, it could bring significant savings that could be invested in more preventive strategies. “If we invest US$185 million, which is around 5 percent of the total expenditure on diabetes now, on preventing the disease among the population between 20 and 30 years old, we can save up to between 50-70 percent of the total expenditure,” says Fragoso.
Chronical illnesses, such as diabetes, require more than just addressing the disease, says Gabriela Allard, President of the Mexican Diabetes Association. Preventive health is also about empowering the patient to become a health promoter within their community. “Health promotion and education are not directed equally to all sectors. Patients should become health promoters to identify all those risk factors and prevent the illness in other members of their immediate environment,” says Allard.

To create a solid preventive healthcare system in Mexico, the sector should agree on a long-term vision. “We need to understand the healthcare system we want for the future. First, we need a vision that includes financial sustainability to materialize a healthcare system where prevention is fundamental and where we can guarantee universal healthcare. A long-term vision will require us to leave behind the shortterm vision present in the system, which is mostly based on a transactional model,” says Cruz.

David Kershenobich
Director General of National Institute of Health Sciences and Nutrition
In Mexico and globally, one of the most significant features of non-communicable diseases (NCDs) is the lack of long-term patient adherence to therapeutic indications and the monitoring of these conditions. Much of the natural history of these conditions has been built around this circumstance.
A fundamental aspect has to do with models of care. In the consultation system that prevails today, the lack of a comprehensive management plan for these patients that sets clear goals is notorious; it is commonly reactive care. This translates, for example, into the repeated recording of the medical history by different specialists, fragmented management of the patients and multipharmacy involvement.
One of the main paradigms in the care of these diseases is that obtaining good results requires specialized care. It is clear that this involves more consideration of complications than their prevention and, more importantly, than the prevention of the disease itself. It is difficult to change this paradigm and yet it may have become impractical or unacceptable. A change in care provision at earlier stages of the disease by general practitioners is imperative in most communities in Mexico. Good results require lifestyle changes, but many times it seems rather a rhetorical affirmation, not without solemnity, which implies a rupture in the most immediate cultural context; there is no doubt that it is a notion that is difficult to change. Over time, these diseases may have durable and traumatic consequences. At the heart of this statement is the complicated topic of aging. Deep down, there is often neglect and confusion regarding all these dilemmas, which eventually manifests itself in marginalization, ignoring treatment and possibly depression.
Among the different characteristics that differentiate NCDs from other pathologies is the fact that they frequently affect more than one organ and, therefore, require an interdisciplinary approach. An important part of healthcare focuses on the logic of consultation by specialized physicians, which has been considered the best strategy for more than 20 years, yet the incidence and prevalence of these diseases are increasing.
It is necessary to return to basic concepts, including information and education for the prevention of these diseases, to move attention away from the rhetoric and make it digestible. But far more challenging is to make the care of these patients accessible to most doctors and here I mean non-specialists. It is essential to build a comprehensive model of care that considers the knowledge of those affected and their uncertainties. Patients should be offered the possibility of taking the floor, knowing their truth and not having adherence imposed on them. Efforts should be made to promote the importance of this issue, which is relevant in the short, medium and long-term management of a chronic disease.
This type of guardianship is difficult to achieve in a strategy that fragments the care of the affected individuals by different specialists. At the center of the medical care of patients with NCDs is the need to incorporate general physicians, particularly for early and timely detection. To do this, several actions are necessary, such as offering them quality continuous medical training and education on these conditions, beyond the clinical guidelines that are often complex and inaccessible in their compliance. It is necessary to promote physician’s insight and interest, facilitate their activity and give them both economic and scientific recognition.

Q: What are CMH and its members doing to contribute data and information to feed Mexico’s epidemiological profile?
A: We use statistical data to improve our services. All the data we use is anonymized and collected with the patient’s authorization. To achieve better data collection and analysis in Mexico, hospital systems must be able to readily share information and become interoperable. This will allow for better planning and responses. We want to collect more data to better understand the needs and behavior of the population and develop ways to address them. Data is the foundation of a better health system.
Q: Depression is among the top mental ailments in Mexico. How are CMH members supporting mental health?
A: Hospitals are redefining their approach to mental health and numerous other areas. Traditionally, hospitals would define their capacity and specialties, which normally did not include mental diseases because these are still poorly diagnosed among the population. Many Mexicans have not had a proper mental disease diagnosis and treating mental diseases falls beyond our scope in terms of professionals, infrastructure or insurance coverage. Mental health remains, unfortunately, a forgotten area.
As hospitals redefine their approach, we have to recognize that we are part of a broader health system. The other pieces are physicians, laboratories, pharmacies and insurers, among others.
Q: How is CMH strengthening primary care and what are the main obstacles in this regard?
A: CMH is strengthening primary care by making it more accessible to the general population. While many hospitals are not designed to provide primary care, we can initiate alliances to strengthen the facilities that already offer this service, such as pharmacies that have a pharmacy-adjacent medical office (PAMO).
Hospitals can also provide medical professionals with training and integrate their clinical records. CMH is developing an alliance to train doctors and working with them to offer quality, affordable primary care.
We want to drive collaboration, digitalization, mental healthcare and primary care because we have realized that there is an opportunity for us to benefit Mexico’s population.
Q: How are CMH and its members advancing the sector’s digital transformation?
A: We have two priorities regarding digitalization. The first is a “digital hospital” model to modernize our facilities and integrate digital tools that can benefit our internal processes, from the admission of a patient to the complete generation and use of their electronic clinical record (ECR). The second is the systematization of the entire health system to interconnect different facilities, including pharmacies, laboratories, clinics and financing services. Having access to this complete information will allow all actors in the health chain to provide better care.

Q: Hospitales MAC has undergone a rapid infrastructure expansion. What allowed Hospitales MAC to achieve such progress?
A: Hospitales MAC, founded 13 years ago in Celaya, has sustainably expanded throughout the country, achieving, two years early, our “15/15” goal of opening 15 hospitals within our first 15 years two year early. We have four hospitals under construction in Los Mochis, Queretaro, Leon and Mexico City and we have acquired land in Cancun. We are analyzing expanding to other cities through hospital acquisitions to reach 25 hospitals in the country. We are also planning a new strategic expansion of our infrastructure and equipment.
Our success has been driven by our business model, which combines three core features: highly advanced medical equipment, well-trained medical staff and fair prices. While other hospital chains offer one or two of these features, we provide all three.
Q: What is Hospitales MAC’s differentiator versus other hospital chains in the country?
A: As a business, our main differentiator is our expansion capacity. While a large hospital chain might grow 5 percent annually, we grow about 30-40 percent. We recently raised MX$1.5 billion (US$75.46 million) on a five-year term with an Interbank Equilibrium Interest Rate (TIIE) of +2.1 percent. We are using that to pay down our higher-rate debt and to guarantee we reach our 15-hospital goal relatively easily.
We are operating on the Institutional Stock Exchange (BIVA) and plan to raise more capital by 1Q23. Moreover, we are a large employer in Mexico with about 3,000 people working in our hospitals and 1,000 at our construction sites.
Q: Why should doctors and medical professionals choose Hospitales MAC?
A: We offer doctors a high-tech environment, a vast supply of medicines to meet prescription needs and a safe, modern infrastructure. These features allow doctors to provide quality care to their patients. Our hospitals also provide doctors the ability to reach more people as our costs are competitive, which gives doctors the opportunity to provide an even better service that a patient might receive at a public hospital.
Q: Fully digital hospitals are the emerging trend in the sector. How is Hospitales MAC integrating technology at its facilities?
A: The pandemic accelerated telemedicine by at least 10 years but prior to this acceleration, Hospitales MAC had already implemented tools like the electronic clinical record or digital imagine interpretation centers for tomography. Moreover, during the COVID-19 pandemic, we strengthened our remote consultation services by creating “MAC at home,” a service to deliver a set of tools like oximeters to facilitate remote consultations with doctors.
We are looking forward to integrating digital tools into our work and with the support of our Strategic Planning and Innovation Department we will make the most of hospital technology.

Q: How are your hospitals and clinics addressing financial hardship among patients who need care?
A: Grupo Torre Médica has a low-cost care model that allows us to reduce costs without compromising quality. We spend our money on good equipment and medical professionals instead of luxury rooms, reducing the deductible cost for people with a major medical expense policy.
As part of our model, we divide our patients into four groups for which we have developed alliances to cater to their needs. The first group of patients we usually receive is affiliated to a social security institute but wants a better, faster option. Births are a common driver for this group. The second group is made up of patients who do not have public or private insurance and rely on INSABI to pay for part or the entire hospital bill. The third group includes patients who have social security but do not use it, while the fourth group comprises those with a major medical expense insurance policy but a limited budget to pay for deductibles or co-pays.
For instance, we have an alliance with a large national pawnshop because we realized that about 45 percent of pawnshop loans are used to pay for healthcare, including hospitalizations, treatments or medical devices. Patients often rely on pawnshops to pay for emergencies, such as an accident or sudden illnesses like appendicitis. Through our alliance, the hospital can direct patients to the pawnshop and it will directly transfer the money from their goods to the hospital bill. We also have an alliance with a credit company that provides patients the opportunity to pay their bill in 24-48 instalments, which is used mainly to finance programmed surgeries for functional procedures.
Q: What was Grupo Torre Médica’s role in the publicprivate hospital agreement during COVID-19?
A: This unprecedented public-private cooperation agreement was led by CMH and the AMHP. It allowed private hospitals to relieve the strain placed on public health institutions from their nonCOVID-19 patients so the government could focus on attending to COVID-19 patients. Under this model, private hospitals receive a modest payment from the government for providing care, which generally comprised births, hernias, appendicitis and general surgeries. As the pandemic advanced, we would also receive COVID-19 patients that the public institutions could not take. Grupo Torre Médica has two hospitals. Half of each was converted to treat COVID-19 patients and all of them received the same attention, whether they were financed by the public sector or by their own means.
This agreement will be the base for the future of public-private collaboration. Both sectors recognize that we have to expand access to healthcare. Private hospitals are never 100 percent full, while public institutions have limited capacity due to the large number of patients they receive. Working together, both sectors can expand access and promote transparency.
Q: What are your growth goals for Grupo Torre Médica?
A: Our next step is to continue expanding in Mexico City. We plan to open another two clinics and a third hospital. Additionally, we will continue introducing new medical equipment.

Q: CHRISTUS MUGUERZA has a robust hospital interconnection. How has this offer translated to a better internal performance?
A:CHRISTUS MUGUERZA has the one and only fully digital hospital in the country. This hospital, located in Saltillo, digitalized all its processes, from management to patient records, and integrated them into the same system.
In the future, we plan to standardize all our operational models, including the digital transformation of our three different facility types:ambulatory care clinics, emergency units and high-tech hospitals.
We are well aware that technology supports the irreplaceable medical and nursing staff of a hospital. For CHRISTUS MUGUERZA, technology does what humans cannot; robots will never have empathy, creativity or compassion. As a result,they will always be a complement to the medical practice, never a replacement. Algorithms, formulations and improved AI solutions can be used by medical professionals to provide better practices and continue improving care.
Q: What differentiates CHRISTUS MUGUERZA’s educational proposition for doctors and nurses?
A: One of our social commitments is to become instruments for the development of medical professionals. CHRISTUS MUGUERZA is a hospital-school network with clinical summits for specialization programs. We have around 150 doctors training in 10 different medical specialties and three subspecialties. All of them are post-graduate students from Universidad de Monterrey (UDEM) and from Universidad Popular Autonoma del Estado de Puebla (UPAEP). We provide these students with academic and maintenance scholarships, coupled with the educational offer of clinical practices within our hospitals. To complement their training, these students carry out research activities and are only able to graduate after producing a research project approved by a highlevel committee. As a result, CHRISTUS MUGUERZA trains specialized doctors able to analyze research papers and generate their own to contribute to medical practices.
On the nursing side, we have two schools in Monterrey and Chihuahua. The school in Monterrey is part of a strategic collaboration with UDEM and is likely the only nursing school accredited by the Southern Association of Colleges and Schools (SACS). This accreditation allows our students to take part in specialized training in the US and gives them the opportunity to become a certified nurse and able to work in the US. This makes our nursing school in Monterrey unique. The school also provides about 26 different programs, from basic nursing to specialized nursing programs and a nursing bachelor’s degree.
At our Chihuahua school, we are partnered with the Universidad Autonoma de Chihuahua. This school has also delivered successful results and responded to the state’s needs.
Thanks to our membership with Christus Health, we have around 25 graduates with an MA in Nursing Sciences granted by the University of the Incarnate Word in San Antonio, Texas. The membership also gives our interns the opportunity to rotate hospitals at one of the Christus Health facilities.

Q: Mexico has a very limited number of specialists and nurses. What approach could the sector take to remedy this?
A: Mexico is going through a nursing crisis. Part of this problem is caused by the lack of recognition of nursing as a professional practice on the same level as any other bachelor’s degree. This is discouraging for young students wanting to specialize in the field. This is a serious matter becauseat least 70 percent of a patient’s contact at the hospital is with a nurse. The nursing staff is in charge on ensuring that treatments are effective for patients. We need to find the source of this problem and understand the implications it has on our health services.
As for doctors, Mexico has plenty. Per year, we have around 50,000 doctors who want to begin their specializations. However, the number of spaces on offer is about 10,000, which is an enormous gap. Mexico has doctors but not enough training opportunities for them. Likewise, most specialists are concentrated in big cities, leading to the poor clinical development of medium and small cities. For example, we receive calls from people in different states who need to be transported by air to another state to get proper medical attention.The National Health Development Plan could further focus on closing this gap and propel private and public medicine in small and medium cities.
Q: As a reference institution, what are CHRISTUS MUGUERZA’s contributions to the move from corrective to preventive healthcare?
A: Corrective healthcare has led to a significant increase in Mexico’s healthcare expenditure. The established prevention programs have areas of opportunity but the problem is that the system pays more for corrective medicine than for preventive medicine. For instance, in the private sector, it is common for insurance companies to deny compensation for preventive medicine; the compensation is paid when corrective procedures are applied.
It is necessary to change this approach. Through its industrial medicine branch, CHRISTUS MUGUERZA provides preventive healthcare to 85 companies, helping them to avoid accidents. Moreover, we provide preventive medicine for weight control, general check-ups and services for early disease detection or prevention.
We also have community service clinics where the CHRISTUS MUGUERZA Foundation provides services to around 100,000 patients per day through first-contact clinics for people who lack proper healthcare access. Moreover, we have community medicine days that provide health education to children.
Humanity is at constant risk of discovering new diseases the hard way. Pandemics come in many forms, not all of them being infectious diseases (as is the case of overweight and obesity). However, the most disastrous ones often integrate diverse humananimal interactions. Understanding the economic and social causes behind these interactions can be key to preventing disasters like the COVID-19 pandemic from happening, experts say.
There is a particular category in medical jargon regarding pathologies caused by microbes native to animals that can also cause disease in humans: zoonotic diseases. Most, if not all, of the major plagues and pandemics that have ailed humanity find their origins in animals. The current pandemic, too, probably came from animal reservoirs. The exact mechanism in which a specific pathogen may come to infect humans may vary, but there are five major mechanisms at play, according to the CDC:
+ First, there is direct contact, in which a person is in close contact with an animal that carries the pathogen or its bodily fluids.
+ The second mechanism is through indirect contact, where someone comes in contact with areas, objects or surfaces where animals live and roam.
+ The third mechanism involves diseases carried by vectors, usually insects.
+ The fourth and fifth ones involve the contamination of food and water, respectively.
The discussion is further enriched by approaching it through the social dynamics at play that may affect how diseases emerge and spread. Agricultural and farming practices play a crucial role in a transmission mechanism, due to several worrisome practices. Industrialized animal farming practices often demand animals to be kept in close proximity to one another. This creates a problem as infectious diseases in animals can spread easily and swiftly. The other critical component of industrialized farming is the widespread use of antimicrobial agents, as the industry fails to consider that bacteria evolve. Having antibiotics in their environment will make bacteria that can resist them thrive, explains the OECD. This leads to an increase in the use of antimicrobials, creating a vicious cycle that is already signaled as a problem even among humans. “Prevention is just as important for animals as it is for humans. We need to be constantly proactive and work to avoid future crises. Animal and human health are closely related,” says Tiago Arantes, General Director of MSD Animal Health in Mexico.
Given the complexities entrenched in these social and economic dynamics and their permanence in society, something must be done to curb the emergence of new pandemics. One model that tries to provide a framework for this to happen is One Health. The One Health Commission defines it as “a collaborative, multisectoral and trans-disciplinary approach to achieve optimal health and wellbeing outcomes recognizing the interconnections between people, animals, plants and their shared environment.” This initiative represents an effort to not only focus on the human part of health. While it remains a model with a particular interest in human health, it broadens the horizons of what health itself entails and provides analytic frameworks that help put human activities, and their consequences, in perspective.

Q: COVID-19 has accelerated the digital transformation of the sector. What is CMPH doing to join this transformation?
A: CMPH is trying to migrate to robust hospital management systems. We already have a plan toward 2023 to implement a digital platform that will include ECR, attention monitoring, imageology and laboratory data management. We want to create a portable hospital experience for the patient, which takes a long time. However, we are already working toward a more friendly patient experience.
Q: How might the COVID-19 pandemic impact medical tourism in the long term?
A: The pandemic has significantly impacted the medical tourism industry. One concrete example is Canada, which was a large source of patients who are now home bound because of border restrictions. CMPH has alliances with many institutions that have allowed us to maintain our foreign patient levels when it comes to the US. Despite the pandemic, I think the cost-benefit that Mexico offers to foreign patients is still there. The attractiveness of the attention has not changed and I hope this will serve to reactivate the sector in the future.
Q: How will the hospital environment in Mexico change after COVID-19?
A: There are many fronts that have been impacted by the pandemic. Medically, it has transformed the regular pathologies treated at a hospital. COVID-19 has unleashed a large number of respiratory cases, putting pressure on ICU units and procedures. At CMPH, we are trying to strengthen our services by looking into lung transplants. The hospital is already recognized in the area of transplantation. We are leaders in kidney, heart and corneal transplants. We are working on our first lung transplant this year and will begin offering this service to our community. I think that, especially in the future, this will be a widely needed service due to the long-term affectations of COVID-19, as most severe cases do not respond to treatment or therapies.
Q: How will CMPH continue pushing forward research and education at its facilities?
A: We have a strategic alliance with the only health school of Tecnológico de Monterrey outside Nuevo Leon. To date, we are working with seven subspecialities and are looking forward to adding a new one next year. We want to continue working to educate high-specialty medical talent at our hospitals and despite the challenges brought by the pandemic, CMPH continues working toward this goal. Moreover, we are working with local universities like UDG, UG and UAN to pursue this goal locally and nationally.
Q: What are CMPH’s near-term goals?
A: As a hospital, the most important challenge we have right now is the large turnover of nursing staff. This is a national phenomenon that resulted from the pandemic and the need to respond to the crisis. However, this has impacted hospitals because we are losing trained and prepared staff in whom we had invested. We are trying to find more nurses for our care areas. However, a great deal of training is needed to successfully integrate new people into our specialized areas.

Q: Mayo Clinic is a global nonprofit leader in healthcare, research and education. How do these three areas complement each other to make the institution a reference in healthcare provision?
A: At Mayo Clinic, we have a three-shield approach guided by patient centered care, as stated by our primary value: the needs of the patient come first. Our integrated practice calls for collaboration among our physicians and care teams to ensure teamwork and continuous learning. We also learn through research and we excel at putting this learning and knowledge into action. Education is applied through shared learning, as our discoveries and therapies are used in patient care and also taught in the US and globally. We have been doing this for more than 150 years.
Q: How do you combine attention, quality and innovation in the treatments you offer?
A: Mayo Clinic is an integrated clinical practice. Our physicians and other health care providers, work together to offer the best approach. Physicians and their teams evaluate the needs of each patient in real time. This collaborative approach increases the quality outcomes of our organization, providing the best care options to patients. We specialize in serious and complex health cases. Mayo Clinic has been recognized as the No. 1 organization in the US by US News and World Report.
Q: How is Mayo Clinic supporting healthcare’s digital transformation?
A: We were a pioneer institution in medical records development. Due to our multi-specialist approach, physicians started to use a single record for their findings and this is how our integrated documentation began. In fact, the first medical record to exist in the US was started by the Mayo Clinic.
Mayo Clinic has three primary locations in the US —Rochester, Minnesota; Phoenix and Scottsdale, Arizona; and Jacksonville, Florida— and the Mayo Clinic Health System has facilities in Minnesota, Wisconsin and Iowa. All of them are interconnected through a single platform to allow treatment continuity regardless of the facility patients go to. Mayo Clinic is one organization, so the patient should feel as if they are visiting the same facility and receiving a consistent and high-quality approach to care. We are a physician-led organization, professionally run by an administrative team under an engineering model, which means everything has a process and a way of happening. Likewise, this model spurs innovation, which is a result of research. We know when we need better tools, visualization or therapies in our clinical practice and this has led us to develop solutions and sometimes commercialize them.
Q: What is Mayo Clinic working on regarding the pandemic?
A: The COVID-19 pandemic accelerated innovation at Mayo Clinic. To date, we are improving our telemedicine capabilities to construct a mechanism to meet the patients where they are and also, we are developing advance care at home (home hospital) to address the evolving needs of the patients. We are striving for more innovation, expanding our global collaboration to really make a difference in patients’ lives. Through collaboration with our local and international partners, will we build something strong together.

Director General of MAG Medical Group
Q: How will your new hospital wing impact MAG Medical’s services, its operations and the medical specialties it addresses?
A: We will implement new specialty areas. We will have an ER with six cubicles, a resuscitation area, more patient rooms and a much better equipped offering for diagnostic support in the imaging area. This technology is hard to find in Mexico City, which positions us as an advanced hospital in the region and increases our growth expectations. We are offering state-of-the-art equipment that will help doctors deliver a better service.
One of our more significant improvements with this wing is our operating capacity. In the past, we would carry out simple procedures but we could not perform complex surgeries that required intensive therapy and a high degree of observation.
Q: Hospital interconnectivity is becoming increasingly popular. How is MAG Medical riding this trend and how has it transformed your business?
A: As a company transitioning to a high-tech offering in terms of equipment, we are aware of the importance of interconnected systems for internal performance. Moreover, we have understood the need to integrate other digital solutions, such as telemedicine consultations, which are particularly suitable for monitoring a patient or providing simple guidance.
Even prior to the pandemic, we had digitalized our internal communication networks, which allowed business continuity amid the pandemic’s restrictions. Now, with our expansion, MAG Medical will have smart operating rooms that will allow live transmissions for medical feedback from outside the hospital, which enhances and enriches the medical conversation around the surgery. In the future, this will even allow remote surgeries in real time. This puts us one step close to achieving hospital interconnectivity. While this is an essential step, I am a firm believer that presential medical attention cannot be replaced and that empathy in the medical field is essential to ensure patients have a good experience.
Q: Medical tourism was highly impacted because of the pandemic. How is this sector primed to bounce back and what will be MAG Medical’s participation?
A: As president of Mexico City’s Medical Tourism Cluster, I can say that the pandemic has put all our efforts on standby. We are just starting to see the reactivation of regular tourism. The recovery for medical tourism will take a long time. Mexico’s poor management of the pandemic has damaged our global image, which affects foreigners’ trust in the country’s healthcare system. I think that during the second part of the country’s economic reactivation plan, medical tourism will garner more attention. For now, it is not a priority.
At MAG Medical, we fully trust the potential of Mexico City as a medical tourism hub. We recently opened an office in Florida and we hope this serves as a link for patient recruitment from North America. We expect to focus more on our medical tourism strategy in the second half of 2021.

Juan Zamora Director of Laboratorio Médico Polanco

Horacio Garza Director General of CHRISTUS MUGUERZA Health System

Miguel Khoury Director General and Chairman of the Board at Hospitales MAC
Mexico’s health system is trying to move to a preventive care model. To do so, providers need to harmonize their approach considering all different population groups. Many actors in the hospital and laboratory sector are already establishing mechanisms to begin the transition, as they often are a patient’s first contact. Mexico Health Review asked industry leaders about their efforts to advance prevention.
Preventive healthcare is something we are learning as a society. During the pandemic, the world started to become aware of the importance of prevention. A true culture of prevention, where everyone lives healthier lives, is yet to come. Health is an accumulation of decisions in our lives. Laboratories are obligated to offer solutions that accompany patients through all aspects of their health. We must act as allies to help empower patients to take proactive control of their health.
Corrective healthcare has led to a significant increase in Mexico’s healthcare expenditure. The established prevention programs have areas of opportunity but the problem is that the system pays more for corrective medicine than for preventive medicine. It is necessary to change this approach. Through its industrial medicine branch, CHRISTUS MUGUERZA provides preventive healthcare to 85 companies. Moreover, we provide preventive options for weight control, general check-ups and services for early disease detection or prevention. We also have community service clinics where the CHRISTUS MUGUERZA Foundation provides services to around 100,000 patients per day through first-contact clinics for people who lack proper healthcare access. We have community medicine days that provide health education to children.
Through Fundación MAC, we carry out cleft lip and palate, cataracts and heart surgeries for children with Down syndrome. As preventive healthcare gains relevance, we are using the foundation to provide free nutritional consultations and to help fight diseases like obesity, hypertension and diabetes. It is key for hospitals to support these types of measures and provide free nutritional guidance to teach better eating and exercising habits. In the long-term, these actions will reduce the country’s healthcare burden, allowing for the more effective use of healthcare budgets.

Director of Laboratorio Médico Polanco
Q: As the new director of Laboratorio Médico Polanco (LMP), how are you moving the company toward a preventive healthcare model?
A: Preventive healthcare is something we are learning as a society. During the pandemic, the world started to become aware of the importance of prevention. A true culture of prevention where everyone lives healthier lives is yet to come. Health is an accumulation of decisions in our lives.
Laboratories are obligated to offer solutions that accompany patients through all aspects of their health. We must act as allies to help empower patients to take proactive control of their health.
Q: Austerity is among company’s values. How have you balanced that with investment in innovation?
A: Austerity is not necessarily reflected in technology, services or the core of our business. It is reflected in us, in the type of offices we have, where they are located, the cars we drive and so on. This allows us as a company to invest in everything that adds value to be able to offer the best diagnosis to patients.
We have invested significant sums to guarantee the quality of the diagnostic service, both in the laboratory and imaging. This year, we will replace imaging equipment in around 60 percent of our business units. We also invested in the installation of a temporary laboratory to offer diagnostic services in CitiBanamex’s temporary hospital. Other important investments have been made in training our personnel and creating jobs.
Q: What are your priorities at the head of LMP?
A: Many of our plans have changed radically.Although these are temporary changes, many studies have been put on hold. Also, we stopped providing certain studies because we had to concentrate on COVID-19-related studies. There has definitely been a larger demand for the latter than there has been for the other studies we performed, especially as patients interrupted their continuity of care. We are now seeing a return to that continuity. We are not only seeing patients resume the care they paused; we are also seeing patients embrace a preventive approach to their health through check-ups.
Our promotional campaigns in May and June are completely focused on prevention. In May, we will focus on women’s health and in June, the focus will be on younger people who might not have been health conscious before. We are trying to reach young people through exercise and fitness check-ups in alliance with representatives of the team that will participate in the Japa nParalympics. With this campaign, we want to invite the population to take care of their health through prevention.
Q: What trends have you identified that could benefit from new diagnostic solutions?
A: We are developing tests for geriatric patients through a new branch. Another relevant area is women’s health because we have seen that women act as health promoters within their families. This dynamic has existed for a long time but it was strengthened during the pandemic. Another important topic

for prevention is diabetes. We are working to identify patients who are predisposed to develop insulin resistance or diabetes.
We are also focusing on the digitalization of services, a trend that had been growing before the pandemic but which has skyrocketed since it started. We are developing appropriate solutions and technologies so patients can stay home. The objective is to offer a home lab. We are performing home-based laboratory and imaging tests and, gradually, we are going to increase the services we offer. The goal is to have an app that facilitates this process from a distance and meets the needs of the patient.
Q: How is LMP upgrading the services it offers to other companies? What added value do you offer to these clients?
A: Our B2B services focus on two important business lines. The first is serving companies that are relevant in their different segments. During the pandemic, we helped them keep their operations in the best possible condition. We also process many samples from other laboratories and hospitals.
We have also realized that we can expand our range of services and accelerate diagnostic capacity through innovation, technology and process efficiency. This will allow us to reach more companies and also the medical sector. For example, we are setting up a laboratory inside the Guadalajara airport for PCR testing, avoiding the need to take samples to an external processing center. These kinds of opportunities have allowed us to offer a better, faster and more efficient service.
Q: What are your perspectives postCOVID-19, especially regarding chronic and cardiometabolic disease control?
A: One of our main priorities is vaccination. The infection curve is flatteningand in the coming months, aftermore people are vaccinated, we want to provide specific tests to quantify immunity levels. In the meantime, although we are pleased that the curve is flattening,we are still prepared for a third wave.
Regarding prevention, we are developing early diagnostic tests for insulin resistance. In June,we will start new check-ups, which will include consultations on obesity, impedanciometry and nutritional care. We have also been offering multiple webinars for patients and physicians to better educate the population. At the same line, we are organizing a congress for the medical community to present this information and our own research.

CEO and Founder of Grupo Sohin
The COVID-19 pandemic is posing considerable challenges to healthcare systems and societies. From its fi rst mention in December 2019, COVID-19 quickly progressed into a major public health concern for Mexico’s private and public healthcare system.
Complications beyond the initial period of acute infection and illness became a target for multidisciplinary clinics worldwide. The list of persistent and new symptoms reported by patients is extensive. Within the past year, a large population of survivors with prolonged post-infection symptoms have been reported. However, pandemic-related inpatient service demands, disrupted ambulatory practices, social distancing and physical space limitations require creative adaptation.
Our model combines telehealth visits, followed shortly thereafter by an in-home, comprehensive medical evaluation. Our core belief is that rehabilitation programs should be individualized and adapted to accommodate the needs of the patient.
The post-COVID-19 clinic at SOHIN was created to provide ongoing care and assessment of adult patients who are recovering from COVID-19. The clinic is designed to treat patients who are still experiencing symptoms as well as to monitor for any late effects of COVID-19 infection.
Several reports identify and address non-pulmonary sequelae, including extrapulmonary organ dysfunction, physical rehabilitation needs, cognitive impairments and psychosocial vulnerabilities. Acute cardiac, neurological, neuromuscular and hematological complications had significant implications for our post-COVID-19 clinical program design. Patients will have access to specialists in primary care, cardiology, pulmonary medicine, hematology, nutritional specialists and neurology as well as to mental health providers.
Each patient will receive a care plan customized to their specific needs and our outpatient care managers will facilitate all assessments and visits that may be needed. Because the long-term effects of COVID-19 infections are not yet known, comprehensive follow-up and evaluation of patients who are recovering is important for optimizing long-term health.
At discharge, patients with COVID-19 are given pulse oximeters and enrolled in a four- to 12-week monitoring program supervised by an internal medicine specialist care coordinator. Finally, we have optimized patient and provider use of the electronic health record with Salesforce Health Cloud. This facilitates pre-visit completion of patientreported symptom measures across multiple domains, improving the clinic’s efficiency and increasing patient engagement.
The follow-up program at the post-COVID-19 clinic at SOHIN is an outpatient benefit offered to individuals previously hospitalized with COVID-19, including those who required critical care support, and non-hospitalized individuals with persistent respiratory symptoms following COVID-19. We consider our impact crucial to minimize long-term morbidity and mortality associated with COVID-19.

Integral Care for Better Mental Health
Edilberto Peña de León Director of CISNE
Technology Boosts Care Provision, Hospital Performance
Juan Galindo Chief Medical Officer of CHRISTUS MUGUERZA
Assuring Quality in Orthopedics
Iván Encalada Vice President of the Mexican Council of Orthopedics and Traumatology (CMOT)
Healthcare Workers: Foundation of Universal Access
04/23/2021
Protocol Adherence for Quality Care Services
Francisco Hernández and Fernando Manilla Co-Founders of Lex Pro Humanitas
Lack of Physical Activity Can Hurt Productivity, Culture
Betsey Banker Wellness & Ergonomics Ambassador
How to Obtain Financing for Your Hospital or Clinic
Fernando De Obeso CEO of Salud Fácil
Telemedicine, Mental Health; How the Pandemic Changed Health
09/08/2021
The Effects of Patient Empowerment
03/01/2021
Primary Healthcare Must be Strengthened Locally
08/02/2021

Digitalization aims to make life easier for providers and patients. Nevertheless, technology adoption was a challenge in 2020 as everything moved to the digital sphere amid ongoing lockdowns. As 2021 has settled in, technology in healthcare has become a crucial element to ensure continued treatments and successful outcomes.
The exponential growth of technological solutions and the increase in the number of providers using them has inevitably raised the number of cyberthreats that both patients and providers are exposed to, leading to a renewed interest in data protection for all users.
This chapter will share the creative solutions delivered by technology providers in healthcare and how their value proposition has long-term potential to positively impact and empower patients. Furthermore, the chapter will share the novel financing models that the traditional insurance sector is proposing to drive accessibility and contribute to a preventive health culture.

Mario
Massiel
Guillaume
Ricardo
Everardo Barojas | Director General of Prescrypto
Hector Sobrino | Director of Health Services and Transformationat AXA
Eduardo Lara | Vice President, Head of Health Latin America at RGA
Fernando Lledo | Director General of Bupa
Alessio
Embracing technology development can be challenging. It can be made even worse if regulation fails to respond rapidly and ensure a fair and safe environment for innovation. In healthcare, this is particularly relevant as tech systems deal with personal information that can compromise a patient’s well-being. While digitalization has been advancing slowly but steadily across the sector, the COVID-19 pandemic spurred an unprecedented boom in digital health solutions. While this comes with many benefits, concerns are also growing because not all regulatory entities are responding with the same agility as developments unfold.
Emerging trends and solutions call for regulatory issues to be addressed, says ICLG, including data privacy and compliance with the Health Insurance Portability and Accountability Act (HIPAA), which many players use as a model in countries where regulation is lacking, such as Mexico, Jesus Diaz, CIO of CHRISTUS MUGUERZA, and Camilo Garay, Country Manager of 1DOC3, told MBN.
While this framework can be a good base to look at, Deloitte also broke down the steps to form independent regulatory ecosystems for digital health solutions: First, companies need to consider the key players of the ecosystem, then brainstorm the design principles for a new regulatory paradigm and finally determine the regulatory rigor and data required to clear that product. After these steps, Deloitte recommends building a clear regulatory process that is easier to navigate but that still foments innovation. The goal is to create risk-based processes that harness data to expedite the pre-market approval of digital health and ensure device safety, effectiveness and performance throughout the solutions’ life cycle.
The General Health Law promotes the development of health services through the integration of TIs to widen access and quality attention. It also controls tech transfers among dependencies and supports clinical practices with ECR. The law also considers the ability to use biometric data for electronic identification and grants the Ministry of Health the ability to guarantee the interoperability, processing, interpretation and security of the information contained in electronic medical records, as well as the establishment of telemedicine resources and electronic prescriptions. Related laws and regulations include the Federal Law of Personal Data Protection, NOM-004, NOM-024 and NOM-035.
Despite these laws and norms, regulation is the first hurdle when it comes to the introduction of new technologies in healthcare, according to Mario Muniz, Regional General Manager for North Latin America at IQVIA. “We are completely lagging behind in establishing regulation that is transparent but at the same time contemplates all the necessary aspects involved,” says Muniz. He explains that there is little technology promotion in the country for the health sector and even though there are already telemedicine companies operating in the country, there is a need for standardization to allow the general market to benefit during this crisis. According to Muniz, “we are losing a lot of time because we do not have the appropriate regulation.

Guillermo
Bilbao
Director of Health Care of Minsait
Fernando Gamallo
Director
of Information Technology
at
Laboratorios Sanfer
Victor Medina
Acting President of HL7 Mexico
José Arriaga Murcia
CIO at Tokio Marine Mexico
Pablo Cubela
IT Director of BUPA Mexico
Technology and digitalization continue to transform the health industry by allowing stakeholders and patients to take advantage of automated features. While this advancement helps the whole sector, data privacy, ethics and cybersecurity remain a concern due to the delicate information that the health industry manages. “Data protection in the health industry is vital. Even when banks are vulnerated they have the chance to recover the money lost to their clients. With medical information, the patients’ reputation will never be recovered,” says Pablo Cubela, IT Director of BUPA Mexico.
Information must be protected at three different levels, according to Fernando Gamallo, Director of Information Technology at Laboratorios Sanfer. These are: regulations and a legal framework; companies managing data responsibly and at a personal level, having individuals protect their own information. Data governance is the pillar of data security, according to Victor Medina, Acting President at HL7 Mexico. Mexico’s public healthcare system lacks data governance as it provides irregular reports and information. Data governance is the capability within an organization to provide and protect high-quality data throughout its entire life cycle, according to AT&T. “This includes data integrity, data security, availability and consistency, considering people, processes and technology that help enable appropriate handling of the data.”
The health sector was the industry most targeted by cyberattacks in 2020, with 44 percent of all attacks. About 61 percent of them occur via identity fraud, according to Guillermo Bilbao, Director of Health Care of Minsait. This means it is important that companies’ employees are trained in data protection matters. Prevention and defense play a big role when protecting a company’s cybersecurity. But what happens if the attack is successful? Companies must have an emergency protocol to respond to these situations, according to José Arriaga Murcia, CIO at Tokio Marine Mexico. “Nobody is 100 percent safe, even with the best awareness campaigns and prevention. Companies need an action framework, which guides those in charge and tells them what to do. It is important to have backups and be always ready,” says Arriaga.

The customer journey, usually defined as the sum of experiences that customers live when interacting with a certain brand, has clear marketing purposes. However, Gamallo explains that companies need to create a “data journey” for cybersecurity. “Nowadays, we are constantly under attack. We should create the data journey and make people aware of the value of their information. The responsibility is not only on companies and governments; data protection starts with individuals,” says Gamallo.

Mario Muniz
General Manager North Latam of IQVIA
The Mexican Healthcare System presents significant challenges for all of its players, not only due to the high fragmentation of its multiple entities , but also due to the constant evolution it presents in terms of regulation, structure and decision-making.
One of the main challenges in Mexico is the low expenditure in health. Mexico presents a lower expenditure in health as a percent of Gross Domestic Product (GDP) compared to the average of Latin America and to the average of the OECD. Additionally, Mexican expenditure in health is also below other Latam countries regarding the share of government (public) expenditure in health and the government expenditure compared to total GDP.
Relative to private expenditure in health, which represents 50 percent of the health expenditure in Mexico, only 16 percent of it is destined to “other private” expenditure, which mainly includes private insurance. This segment, in terms of affiliated population, represents approximately 10-12 million people, which accounts for less than 10 percent of the Mexican population.
The low public investment in health, as well as the economic difficulties to affiliate to a private insurance provider means that a significant part of the Mexican population has to incur in out-ofpocket expenses (OOP). This is not only identified as a percentage of GDP but also in the contribution of the retail and private hospitals segments in the purchase of drugs. This private segment has shown the highest growth rates, both at market level and in the high-specialty/high-cost segment.
The COVID-19 pandemic implied significant challenges to the healthcare system in various areas. This impact affected not only COVID-19 drugs but also therapies for high epidemiological impact diseases like chronic or degenerative conditions. In spite of drug availability challenges, 2020 represented the year with the highest drug purchasing growth in the last years, that had an important galvanization in the private channel (retail and hospitals), opening new growth opportunities for the diversification of pharmaceutical industry channels.
Even though the public sector still represents the most significant financing scheme for some therapeutic areas, we have observed in some catastrophic categories a noteworthy growth in OOP financing in the last year. This private growth sustainability, especially for high-cost therapies, will depend significantly on increasing private insurance affiliation and on new and innovative schemes implemented by health industry players that allow the continued support of patients who cannot be treated at public institutions. On the other hand, the public market with its various challenges including lack of financing, saturation and operational bottlenecks, will probably need to assure or implement various changes if it plans to remain crucial in providing health services and therapies to most of the population in Mexico.
In this evolving environment, according to Ángeles Martinez, Senior Principal and Head of Consulting for North Latam at IQVIA, the different players in the healthcare system will need to evaluate their current operation, their alignment to a “new normal” and their preparedness for the coming years to optimize their strategies both in the public and private sectors.
Massiel Nunez

Q: How does FrontierView’s market intelligence support different client profiles in the healthcare industry?
A: Our priority is to understand the objectives of the leadership teams of our clients to provide them a tailored business plan that fits their global or regional goals. Through these personalized strategies, we provide clients with a 360° action plan and become an extension of their teams. Market expansion requires reliable information and business insights developed by experts with comprehensive knowledge of macroeconomics, specific industry areas, regional politics and local markets. FrontierView gives clients a better understanding of the market to help them make better business decisions.
Q: Mexico and Latin America struggle to generate robust databases for healthcare. How is FrontierView overcoming this problem?
A: The lack of reliable information, especially in comparison to the US, is one of the biggest challenges companies face in the region. Our team of experts compiles the best and most reliable information based on their expertise. These experts are also constantly in contact with our network of executives, which allows them to have reliable, updated data related to the healthcare ecosystem.
Latin America is volatile and unpredictable but, at the same time, it is a resilient region that has significant raw potential. We identify this potential and the opportunities that exist in the region. The key is to find sustainable opportunities.
Q: Mexico and Brazil are Latin America’s most attractive markets. How can Mexico enhance its healthcare market?
A: Mexico’s health sector is undergoing many changes, which means its actors have a great many opportunities to collaborate and enhance their respective vision of patient centricity. The circumstances are ripe for collaboration between stakeholders to develop solutions for their companies and foster more opportunities for both the public and private sectors.
Q: As a woman in a leadership position in the healthcare industry, what advances have you noticed with gender equality?
A: I feel lucky because this company encourages female leadership. It built a space for us and provides support. FrontierView focuses on development and, as a woman, the company encourages us to continue growing to become leaders. As women, it is often harder to get the same recognition and promotions as men and it is harder to reach leadership positions.
Gender equality can play a larger role at every level of the healthcare industry. It requires collaboration and an effort on both sides: men and women. Healthcare companies are more open and aware of gender inequality, so they are open to providing more leadership positions to women and have encouraged programs for female development, while addressing the realties women face on their professional journey.

Q: What has changed regarding hospital capacity in Mexico since the start of the COVID-19 outbreak?
A: Mexico’s hospital capacity increased considerably regarding basic care infrastructure. In 2020, we saw a 6.4 percent increase in multiple-use beds and an 8.1 percent increase in short-stay beds. However, we only saw marginal increases in the installed base of ICU beds (1.7 percent) and ventilators.
As a whole, we can say that Mexico has increased its capacity to deal with cases of COVID-19, particularly in basic care, but it still has room for improvement in dealing with severe cases.
Q: How did the outbreak accelerate investment in specialized equipment and hospital infrastructure?
A: While 2020 saw a drop of over 50 percent in certain procedures (around a 35 percent drop across the board), the installed base for certain surgical procedures actually increased. Most significant are increases in the number of endoscopy towers ( 10.3 percent), angiography systems (8.9 percent), laparoscopic surgery equipment (6.4 percent), PET systems (6.3 percent) and fluoroscopes (6.1 percent). Some institutions were able to maintain their planned investments amid the pandemic.
Q: How has the market reacted to your HospiCheck and HospiVista services?
A: HospiCheck and HospiVista consultations slowed down during the COVID-19 outbreak. However, there was increased interest in HospiScope, ShareScope and SurgiScope. ShareScope enables clients to be able to track market size and map market share on a quarterly basis with over 95 percent accuracy. This was of critical interest to clients who wanted to understand how their market was evolving during the pandemic. Meanwhile, we partnered with NGOs to identify hospitals with the greatest need for ventilators. HospiScope enabled the quick identification of target institutions and with a high degree of precision.
Finally, SurgiScope enabled us to quantify procedure volumes prior to the pandemic and identify where these were being conducted. We are now able to see first-hand how procedure volumes have been affected by COVID-19 at an institutional level.
Q: How could Mexico improve its regulation to favor a safe data analytics environment and the digital transformation of the health sector?
A: The very first actions need to include mandatory reporting of cases at the institutional level, covering both the public and private sectors. This can cover consultations, diagnostics, treatments and procedures. Data must contain demographic information, such as gender, location and age, but cannot include any unique identifiers, such as name or RFC. Secondly, there must be direction and mandates regarding data exchange platforms and use protocols. This is particularly important when considering coding of diagnostics and procedures, which should be in line with international standards, notably ICD-10.

Manager Mexico, Colombia and Argentina of Doctoralia
The technological transformation in many health services was already underway before 2020. Nevertheless, due to the COVID-19 pandemic, this transition gained momentum. Just look at the growing numbers of online consultations, which only a couple of years ago were not even in the minds of doctors or patients but today have overcome barriers, evidencing their great potential, not only to ease the burden in hospital centers but because they also bring healthcare closer to those who need it the most.
In fact, we expect digitalization in the health sector to keep growing. According to statistics from Doctoralia, there were more than 11,000 online consultations in Mexico just in March 2021. During the first quarter of 2021, an investment was made in digital health of over US$8.5 billion, according to Startup Health, breaking every investment record in digital health in a single quarter.
This is just one example of how technology has benefited us in times of crisis by putting health within reach. But in Mexico, one area where more work is needed is the issuance of electronic prescriptions, as it allows us to digitize the processes and continue supporting remote consultations with every tool that is essential for doctors and patients.
Since 2011, the possibility of issuing electronic prescriptions has been addressed by the House of Representatives. In 2015, the Ministry of Health and COFEPRIS announced the use of electronic prescriptions. In 2018, the General Health Law was amended to validate the digital signature of physicians issuing the prescription.
And although there has already been some progress in the matter, there are still gaps regarding the online prescription of drugs, particularly controlled substances. Nevertheless, when we speak of OTC medications, the handling of electronic prescriptions has countless advantages for doctors, patients and drugstores. Firstly, the digital seals and the electronic signatures are rendered unique, fake-proof and, therefore, help cut down on self-medication.
These prescriptions can be easily and quickly filled thanks to their interoperability. For example, you could get the medication from the pharmacy of your choice (provided it is registered with COFEPRIS). Besides, having the prescription available in your electronic device allows you to closely adhere to your treatment, just as the doctor prescribed.
As for health professionals, the ability to issue electronic prescriptions helps cut back on administrative expenses and complements their expertise when providing consultations and care for patients in any location, even far from the health professional’s geographical area. Health professionals would also have access to a wide catalog of drugs and could check the approximate price, which would help in prescribing the best option for each patient.
The legal framework to regulate digital healthcare in Mexico is still under construction, and the benefits of electronic prescriptions are clear, but greater endeavors focused on this subject are of the essence in 2021 to keep driving the digitization of health and promote its use for the benefit of society.

Américo García
VP and Director General of Apotex Latam
Rafael Maciel
President of Asociación Mexicana de Genéricos (AMEGI)
Enrique Culebro
Director of Central Media
Edilberto Peña de León
Director General of CISNE México
Iván Encalada
Vice President of Consejo Mexicano de Ortopedia y Traumatología AC
Leopoldo Cavazos
Consultant at MYC Asociados en Regulación Sanitaria en México
COVID-19 exposed healthcare system failures but it also opened new avenues for providing services due to the acceleration of the digital revolution. The pandemic is still going strong and continuously changing the health industry, which will eventually provide the population with greater access to healthcare services. “Nowadays, people inform themselves through social media, look for medical solutions on the internet and turn to telemedicine. Some patients even take for granted that doctors should use digital platforms,” says Enrique Culebro, Director at Central Media.
Even when the pandemic ends, videoconferences will remain and change the way health services are provided. COVID-19 also shifted dramatically the mental health industry. “One of the positive aspects of the pandemic is that there is no return to the stigma around mental health. Psychiatrists became more important than ever after the lockdowns,” says Edilberto Peña de León, Director General at CISNE México. About 70 percent of the global population changed their sleeping patterns during the pandemic and depressive disorders increased by 20 percent, he adds.
The use of videoconferencing grew 25 times in 2020, according to Culebro, opening opportunities not only for telemedicine but for doctors’ continuous medical training and communication. That said, technology has not replaced in-person visits. While surgical operations still need to be done on-site, telemedicine could help in post-operatory monitoring and communication with patients, according to Iván Encalada, Vice President at Consejo Mexicano de Ortopedia y Traumatología AC.
Benefits almost invariably carry responsibilities and challenges, among them regulations and the creation of a clear legal framework that protects patient data and helps public institutions, according to Leopoldo Cavazos, Consultant at MYC Asociados en Regulación Sanitaria en México. “The ideal scenario is that every industry actor operates under the same, clear legal framework,” says Cavazos.

Prevention campaigns and several adjustments are needed for the Mexican healthcare system to improve, according to Rafael Maciel, President at Asociación Mexicana de Genéricos. Mexico has to be “more proactive than reactive,” invest more money in its healthcare system, strengthen COFEPRIS and boost biocompatible medicines. “A strong COFEPRIS creates a strong industry and guarantees people’s access to quality, affordable medicines. That is what we need in Mexico: to produce quality generics to fight against the most common illnesses,” says Maciel.

Q: How is Dell Technologies making the concept of a digital city a reality for Latin American countries?
A: In Latin America, we work according to the digital agenda laid out by public policies. A digital city rests on different pillars, among them health, education and security. The goal is to make these available to every citizen. In health, this would mean universal access. For citizens, apps are the easiest way to access digital services and we need to start mapping cities’ needs to develop key verticals for digitalization. In healthcare, for instance, telemedicine is one of the verticals. This has involved the integration of an additional app to manage patients’ Electronic Clinical Records (ECR) and access digitized studies. With these actions, we are empowering citizens with their own data and also, interconnecting healthcare services from diverse provider entities.
Q: How has Dell Technologies worked to implement a digital agenda in Mexico?
A: We have worked on the development of hospital interconnection for a Public Health Institutions in Mexico and patient registration. Moreover, we have developed Efficient Consumer Response and worked with state governments to develop diverse projects for public health institutions for projects on telediagnostics, teleradiology and telemedicine. To build this solutions, Dell Technologies works with different segments of the sector to fit all the puzzle pieces and create the best solutions for the health system in Mexico. In addition, I would highlight that rural zones are also a concern and priority for us. We have worked on projects that drive telemedicine access in different Mexican states.
Q: In Mexico, how has Dell Technologies worked to connect the fragmented Mexican health system?
A: Dell Technologies has mainly worked with Government Resource Planning (GRP) on projects for a government management system that allows for interoperability among many segments. In Mexico, there has not yet been a project to interconnect the health system. However, we have worked on the management and interconnectivity of different public health institutions. One example of a complete interconnected health system can be seen in our project with the government of the Dominican Republic. We are developing a GRP platform to interconnect the country’s entire health system. We are working with the governments of Brazil and Colombia on similar platforms.
Q: How could smart cities be a tool to foresee and prevent threatening events?
A: One example is what Dell Technologies is doing with the government of Brazil. When a positive PCR COVID-19 test is registered, we send alerts and recommendations to the user. We can even send out a kit for the person with essential tools to measure vital signs, such as an oximeter and a thermometer. The user can register vital signs on the platform if their mobile device is not able to do it by itself. If the user registers low oxygenation levels, an ambulance is sent to the location. This initiative has been of great help in reducing the burden on hospitals by keeping patients at home when possible.

Q: Considering the large inequality gaps in Mexico, how is digitalization a response to the lack of health access?
A: Our work with remote communities began years ago. One of the first programs we carried out was with Casa de la Amistad, a foundation focused on children with cancer. We introduced rural telemedicine using pictures of the children’s ailments to ensure early cancer detection. We were able to implement telemedicine centers where an oncologist could treat children by using a computer. The consultation was supported by a general doctor and the child’s parents. As this was implemented in rural areas with no internet, we used satellite connection.
Michael Dell, the founder of our company, is passionate about healthcare. Therefore, Dell supports these projects regardless of the technological barriers we face. We are convinced that technology is the solution for equity and equality in healthcare in Mexico and we are looking forward to continue empowering each patient. For this reason, Dell Technologies is a complete digital provider, from the devices to the development of a complete digital city or system.
Q: What do you consider the main obstacles toward digital transformation?
A: I think resistance to change has been the main obstacle. For Dell Technologies to transform a general hospital in Mexico, it has to approach actors at different levels of the hospital. We need to transmit that the solutions are created to simplify their process, while also listening to their feedback to create products that really support their practice. As we begin working together and materializing their comments, the work gets easier as employees see the results. Digitalization has been extremely helpful in pharmacy prescription, for instance, as medicine approvals and quantities can be calculated based on the patient ECR. Doctors are able to approve prescriptions by phone without the need for either the patient or the doctor to go to the hospital.
Promoting our success stories is a priority for Dell Technologies. This allows governments or companies to see the impact that their investment in technology can have after a period of time. Especially during COVID-19, we have had positive results with our technological solutions by reducing the burden on hospitals. It is important to present these results to decision-makers. At this moment, they are being challenged to make the smartest investment to improve health systems, so it is up to us to take our solutions and impact to them. Investment, effectiveness and impact will determine the decision and Dell Technologies can offer the costeffective options they need.
Healthcare evolves in every society through new care trends, therapies and devices. Habits also transform and adapt to these innovative approaches that, more recently, have been propelled by technology. Evolution in care also demands changes in financing options to truly address the personal situation of each patient.
Mexico spends 3.1% of its GDP on private health spending
MAIN REASONS WHY THE POPULATION SEEKS PRIVATE HEALTH SERVICES
+ Social security is conditioned to employment status. If workers lose their formal job, they will have to pay for health services until they join another system
+ Perception of good treatment and medical attention received at private hospitals
+ Long waiting times to receive a consultation
+
According to AMIS, the average out-of-pocket expenditure in Mexico is MX$4,388 (US$183) a year to treat diseases and maintain personal health. The lack of an insurance culture is widely known, as these products are considered a premium service. In fact, the penetration of insurance companies stands at just 8 percent. Despite Mexico’s need for health financing, insurance rates fall short. During an interview with MBN, Eduardo Lara, Vice President, Head of Health Latin America at RGA, said that the success of private health insurers depends on the public health system. Lara explained that the US, for instance, has the largest private health insurance market in the world as public healthcare is non-existent. However, in countries like Mexico, private health insurance is 100 percent voluntary. Private insurers do not participate in Mexico’s public health system, which is why their penetration is low.
Companies are taking a variety of approaches to create change. MASZ, for example, runs an evaluation with cancer patients around their case and the status of their disease to offer a certain level of coverage. When the patient starts recovering, the insured sum increases. RGA, meanwhile, is adapting its products to what younger generations are looking for, while addressing the population’s true health hurdles, like chronic diseases. RGA combined these two ideas and introduced a new digital product for patients living with a chronic disease. “This is an integral solution for patients with Type 2 diabetes to offer advice, nutritional plans, media guidance, medical appointments and support from different actors on the same platform,” says Lara.
“Since March, the challenge for the insurance industry, and for the health insurance sector in particular, has been to make plans available to customers that offer broader, more inclusive and accessible coverage,” says Salvador Arceo, Director General of Plan Seguro. “The goal is to offer plans that allow access to timely healthcare and maintenance and, where appropriate, recovery, as well as disease prevention and detection services.”
At Mexico Health Summit, Javier Potes, Director General of Consorcio Mexicano de Hospitales (CMH), said the pandemic had increased public consciousness regarding the need for health insurance. He said that plans need to be redesigned to include minor medical expenses. CMH and AXA Keralty recently announced a collaboration to address some serious diseases, such as diabetes or cancer, which can be stopped if detected early. The collaboration will contribute to amplifying the scope of the health services covered by the AXA Keralty alliance through an infrastructure of 45 hospitals located in 43 cities of the country. “Our efforts are focused on prevention and seek to reduce out-ofpocket spending on health,” said Alejandro Pérez Galindo, CEO of AXA Keralty, in an official release.

Romeo Sánchez
Vice President of Engineering at Ecaresoft
Despite how novel they may seem, cyber vulnerabilities and threats in healthcare are not recent. There have been warnings for several years. For example, vulnerabilities have been discovered in devices that deliver medication to sick patients, or in Bluetooth-connected pacemakers, where an uncontrolled change in settings could be fatal to the patient. However, the most common and probably most profitable threat to cybercrime is ransomware.
Ransomware is a type of malicious software that, after compromising a computer, hijacks its information to extort money from the victims, demanding the payment of a ransom, typically in cryptocurrencies, to recover that data. This type of attack has shown the lack of foresight on the part of the health services, since many hospitals do not have data backups, nor do they have business continuity plans that would allow them to face this adverse situation. There are criminal groups that have promised not to attack hospitals but the truth is that, faced with the possibility of obtaining a large profit, attackers have no qualms.
Nevertheless, the good news is that these problems can be avoided by following a prescription that has been proven effective when applied correctly. It all starts with building a continuity plan that first protects patient data in remote facilities, away from any local infrastructure. In addition, considering that email is the main means of distribution of ransomware, either by direct delivery of malware or by phishing traps that trick users into sites where their access data is stolen and then take advantage of them. That is why cybersecurity awareness campaigns for users, as well as the monitoring and control of remote access to systems, are extremely important to prevent them from falling into this type of deception that could be disastrous. Some hospitals have begun to move their critical data and patient records to cloud infrastructures, that is, managed and secured outside of their facilities. Although this measure represents a great advance in the reliability of operations, it is not entirely infallible, so it is essential to strengthen the security of the infrastructure in the cloud, adequately control access, and keep confidential data protected. Last but not least, frequent backups of files and data are paramount so that in the event of a ransomware attack that renders them unusable, a ransom does not have to be paid because data can be restored from the latest reliable backup.
In the particular case of medical devices, such as insulin pumps, ventilators, and other devices connected to the network, they become especially vulnerable when they are not kept up to date with the latest versions of their software. Traditionally, these types of devices are not included in upgrade plans, making them potential entry points for attackers discovering how to exploit vulnerabilities. It is necessary to constantly install security patches on such devices, just as you would with any other computer.
It would be naive to think that our organizations will not be attacked. Cybercrime has become a lucrative industry, and cybercriminals continue to modernize their techniques and attack at any opportunity that comes their way. Just as we seek health on a personal level and seek to immunize ourselves against diseases, our healthcare systems should not be the exception, and they should have the necessary protections to be able to fulfill their mission: to keep patients safe.

Q: What are the main drivers or your market growth in the last year?
A: Mexico’s healthcare sector lagged in the adoption of digitalization while other industries embraced it. The isolation brought by the pandemic changed this situation, leading care providers to integrate digitalization to communicate and provide remote consultations using common communication platforms. These were not professional services and required further modifications to provide appropriate medical consultations. As a result, doctors began using electronic clinical records, specialized telemedicine services and digital prescriptions.
Living the digital experience made both the doctor and the patient recognized the need for an electronic remote prescription service, which also requires deliveries to complete the experience. These services are a basic need, not a commodity.
Q: How did Prescrypto adapt to the challenges caused by the COVID-19 pandemic?
A: COVID-19 allowed Prescrypto to improve its distribution capabilities. After the isolation measures implemented during the COVID-19 pandemic, many e-commerce pharmacies saw us as a strategic growth channel, which helped us expand our services as we began to partner with e-commerce pharmacies.
Retail pharmacies were different. They hesitated to adopt these technologies because the pharmacopoeia had no reference for digital prescriptions. But in December 2020, the pharmacopeia changed to include the use of an e-signature on digital prescriptions, which led retail pharmacies to start using Prescrypto.
Q: What regulatory processes and requirements is Prescrypto following to guarantee prescription safety?
A: Digital prescriptions follow The Model Law on Electronic Signatures published by the UN Commission on International Trade Law. This law, which explains how a document and a set of electronic signatures should look, is the basis for Mexico’s electronic signature law.
Prescrypto does not use advanced electronic signatures because we think that limiting the doctor’s practice by using only a signature issued by SAT is not ethically correct. Also, the pharmacopeia changes of 2020 only mentioned that companies must comply with the data retention standards of NOM-151. We follow the same cryptographic and electronic firm standards and we are the first digital prescription company to comply with NOM-151.
Electronic signatures are used for many services, including credit cards, documents and contracts. Thus, NOM-151 is a response to fintech needs that required electronic signatures to protect and validate data and documents.
Healthtech regulation should respond to innovation and fair competition to provide a fair ecosystem that allows entrepreneurs to thrive using their own technologies.

Salvador Arceo Director General of Plan Seguro

Eduardo Lara Vice President, Head of Health Latin America at RGA

Hector Sobrino Director of Health Services and Transformation at AXA
Chronic diseases represent a global health burden. In Mexico, diabetes, cardio vascular disease and chronic kidney failure are among the most common ailments, representing not only a significant impact on patient health but also one of the common causes of poverty. With such a large population suffering from a chronic disease and limited access to appropriate follow up, it makes sense for the industry to react with innovative products.
Companies should focus on supporting patients with chronic diseases in a way that allows them to have a better lifestyle, beyond just paying for their treatments. This means creating products that work as bridges for the user to have a healthier lifestyle and a better quality of life. These patients obviously need their health recovery treatments but these have to be complemented with psychological support and nutritional attention. Such integral avenues of attention would have a true impact on the user.
RGA introduced in Latin America a new digital product for patients with a chronic disease which has been performing extraordinarily. This model, created by RGA, builds an ecosystem for the user through ally companies. Strategic partners include insurance and tech companies, laboratories, doctors and medical associations, such as the Mexican Society of Nutrition and Endocrinology. Beyond being an insurance product, this is an integral solution for patients with Type 2 diabetes to offer advice, nutritional plans, medical guidance, medical appointments and support from different actors interacting on the same platform. If the patient were to present a severe complication, the product also offers insurance coverage. However, the target of this product is to nurture better habits and a culture of prevention.
The insurance sector does not cover people with a pre-existing condition or with a chronic disease but we try to look for feasible options to cover them in the same way a major medical expenses insurance policy would. People with diabetes who are aware of their condition and keep their disease under control take better care of their health than most healthy people. However, Mexico has a large group of diabetics who are unaware of their condition and only seek medical care when faced with something serious. This is a challenge for insurers because we have a harder time looking for healthy individuals and that has stopped us from efficiently reaching this market niche.

Director
Q: AXA Keralty offers two products for healthcare. How do these complement each other?
A: Our insurance solution for major medical expenses is highly important to AXA, especially in Mexico. However, this insurance segment is challenging due to its low penetration in the country, which leads to large out-of-pocket expenses for those requiring such care. We want to avoid this by promoting a preventive health culture. That drove us to create AXA Keralty, which operates under a model of care prevention rather than correction through a series of clinics.
With both of these services, our major medical expense products and our primary care memberships, we offer complete healthcare coverage and address any possible situation a person might face. We promote these services in the same way as other AXA products: through agents, brokers and promoters.
Q: What motivated your collaboration with CMH to address serious diseases such as diabetes or cancer?
A: We have developed a solid relationship with CMH, which has allowed us to develop a product that brings healthcare to more people through a model that provides them access to the best hospitals in Mexico. After receiving treatment, we hope these patients are satisfied with the care they received and will want to acquire a minor or major medical expenses insurance product.
Q: How are insurtech companies and tech giants coexisting within the traditional insurance environment?
A: Insurtech is still not very strong in Mexico. While many of us in the industry embrace technology and would like to partner with these companies, we still do not see a solid proposal that would fit Mexico. However, AXA is open to the integration of more technological proposals. We are in the process of using AI and cognitive language to support our practices and we are open to more solutions.
Mexico’s health system is unique and we face a problem integrating novel health services. The Mexican market is largely ruled by out-of-pocket patients, who have little knowledge of insurance services for prevention. This lack of awareness of the costs of healthcare is also hard to change.
While COVID-19 led more people to acquire insurance, we only saw growth in individual products as collective policies declined. Later, the economic stress caused by COVID-19 led those with a personal insurance policy to rethink their expenditure priorities and many did not prioritize insurance.
Q: How is AXA Keralty improving its services?
A: AXA Keralty, through our product Planmed and AXA’s Major Medical Expense line of products, is offering a joint package to create a complete primary care solution called Cuidado Integral. This product was initially only offered as part of corporate policies but given its significant growth, it will also be available as individual packages under the name Planmed by mid-September.

Eduardo Lara
Vice President, Head of Health Latin America at RGA
Q: RGA carried out a global study to measure the potential financial impact of the COVID-19 pandemic. What did you find?
A: Thanks to our global support and our local experience we can say that regarding life insurance, we have noticed that, just as with the Spanish flu, COVID-19 will most likely have an impact on the life expectancy of an entire generation. This will couple with the number of deaths and the side effects of the virus among people who overcame the infection. The latter does impact individual life expectancy so we need to consider it.
Regarding health insurance, we have recorded mixed findings depending on the region and the type of coverage available to the user, as healthcare always changes depending on the region. Hospital expenditure has a different impact on insurers depending on several factors, such as hospital or deductible levels. What we have found more frequently are expenditures under the deductible level, which means expenses that are covered by the user.
We have seen that in Mexico average costs for a COVID-19 case is around MX$480,000 (US$23,600), whereas the most expensive COVID-19 hospitalization case paid by the insurance industry was around MX$30 million (US$1.5 million). However, the impact of the overall costs of COVID-19, are more impacted by frequency rather by severity. In fact, the overall result in 2020 for the majority of health insurance companies in Mexico was positive.
For 2021, we expect a similar positive scenario but this will depend on how the vaccination campaigns unfold. On the other hand, last year’s postponed surgeries are expected to occur this year, which will level out insurance claims.
Q: What has been RGA’s financial strategy to establish an adequate COVID-19 response?
A: As a life and health specialized reinsurer creativity and digitalization have been the core of our strategy. Technology has allowed business continuity and quick responses. Almost all health insurance companies are offering telemedicine consultations and digital interaction with users.
RGA has been interested in improving our customers’ experience with our services through a digital offering and this has resulted in new product developments that involve digital tools. Users and insurance companies are both seeking innovative coverage plans that also involve technology to enable practical access and usability.
Q: RGA introduced in Latin America a new digital product for patients with a chronic disease. How has this product performed?
A: The product has been performing extraordinarily. While I am not the leader of this project, I can share that this recently launched model won RGA the Most Innovative Insurer Award. This is a global competition organized by an American company. The project also received a project award from RGA’s headquarters.

This model, created by RGA, builds an ecosystem for the user through ally companies. Strategic partners include insurance and tech company, laboratories, doctors and medical associations, such as the Mexican Society of Nutrition and Endocrinology. Beyond being an insurance product, this is an integral solution for patients with Type 2 diabetes to offer advice, nutritional plans, medical guidance, medical appointments and support from different actors interacting on the same platform. If the patient were to present a severe complication, the product also offers insurance coverage. However, the target of this product is to nurture better habits and a culture of prevention.
We are continuously investing in innovation to support the growth of the life and health insurance industries; the success of this product has encouraged RGA to expand it to other chronic diseases. We began with diabetes but we are also looking into other ailments where this model can be useful and to other countries where we are present to introduce its benefits.
Q: How will COVID-19 influence Mexico’s low insurance penetration rates?
A: This sine qua non event has increased the number of insured people. Even at a corporate level, employers have been resilient and continued with their insurance policies as part of their employee benefits packages. Mexico has a double pay system where people pay for public medical coverage and for their private medical attention, which is why the private insurance sector has a low penetration rate. Still, there are companies that do not provide additional medical insurance.
Insurance premiums have declined or remained stable so people can maintain their coverage without paying too much. Here is where we have identified opportunities to reinvent our coverage and offer products that people will pay for. Reduced premiums are less likely if the person uses their policy to the fullest. To date, health insurers offer comprehensive coverage and people use a small percentage of what they offer, while still paying for the complete service. It is becoming more logical to offer what the user wants and actually uses while still having enough coverage in case of an unexpected health event. An example would be having a product with a high deductible with lower premiums.
Mexico is slowly moving toward this reinvention of health insurance coverage. However, the full transition to a reinvented sector will be slow. Traditionally, the insurance industry is very conservative.

Q: What steps have you taken to increase your customer base in Mexico?
A: We have strengthened the customer service area. Customers are at the center of everything we do. At the end of the day, we are an organization whose purpose is to look out for our clients’ health. This work is not only focused on insured customers but on all our business partners.
Bupa was regionally divided and Mexico was quite reliant on Miami when it came to service. However, now everything depends exclusively on Bupa Mexico. Today, Mexico is a totally independent business unit. Mexico is a strategic country for Bupa. To take advantage of the country’s full potential, the most important factor is to be operationally independent.
We have also implemented a number of improvements to all our products and are launching new ones. In the beginning, our product was aimed only at a niche market of people who could choose to be treated medically in Mexico or in the US. The new strategy we have for Mexico is to target the entire population. Most of the Mexican population cannot or do not need to have a product with so much coverage and care outside of Mexico, so we created Bupa Nacional Plus, which is the best product for people who only want to be treated in the country and also Bupa Esencial Libre Elección, that is for people who do not require hospitalization but need consultations in Mexico.
Q: How has the pandemic impacted your coverage plans?
A: The pandemic has not impacted this part of our business. We were very well-prepared to face this crisis and we have provided full coverage. We have continued to provide the best service to our members. When one of our patients needed to be hospitalized, we looked at where there were beds available and where the best location was for them to be treated. If the medical team and Bupa concluded that it was best for the patient not to be treated at a hospital, we arranged for all the equipment and material that the patient needed, such as respirators and oxygen, to be placed in their home.
On top of all that, this year we launched Bupa at Home. One of the main issues of the pandemic is that people neglected many of their illnesses and conditions as they avoided leaving their home or going to a hospital. Bupa at Home brings the services that patients need to their homes. An unlimited service that we have offered free of charge to our clients in teleconsultations and telepsychology consultations.
Q: Will telemedicine impact health insurance prices?
A: These are business models that are here to stay. Telemedicine is a trend we already had in mind before the pandemic hit but the crisis accelerated all our plans. We must be aware, however, that telemedicine is not a substitute for face-to-face healthcare. Each model must be implemented at the right time so the patient receives the best possible care. The fact that medical service is offered through a digital platform will not change the price of insurance plans. I think price will still be dictated by what the patient is willing to cover and how they want to receive the service, whether in person or digitally.

Friendly Tech Solution Aims to Spur Blood Donations
César Esquivel Co-Founder of Blooders
Fostering Donations, Saving Lives
Sergio Medrano Latam General Manager of Be the Match Mexico
Digital Channel Fosters Closer Doctor-Patient Relationship
Oscar De la Garza CEO and Founder of MEDPACOM
Digital Transformation, Health and Mexico’s Regulatory Framework
Christian López-Silva Partner, Head of Healthcare and Life Sciences of Baker McKenzie
Happinss Leverages VR Technology to Improve Well-Being
Rodrigo Padilla and Marco Antonio Wang-tsu Li Co-Founders of Happinss
Innovation Measured Through Impact, Not Revenue
Javier Bacho and Santiago Yeomans The CHRISTUS Excellence and Innovation Center
Interconnected Health Systems Migrate to Value-Based Models
Luis Lojero CEO of Mural Med
Health Financial Support Through Better User Experiences
Salvador Arceo Director General of Plan Seguro
Marketing Health Digitally Requires Fast Adaptation
Enrique Culebro Founder and General Director of Central Media
Cyberattacks Threaten Healthcare Sector
06/08/2021
3PLs Third Party Logistics
ACROM Clinical Research Organization Alliance of Mexico
AMELAF Mexican Association of Pharmaceutical Laboratories
AMID Mexican Association of Innovative Industries of Medical Devices
AMIIF Mexican Association of Pharmaceutical Research Industries
AMIS Mexican Association of Insurance Institutes
ANADIM National Association of Drug Distributors
ANAFAM National Association of Drug Manufacturers
ANTAD National Association of Supermarket and Department Stores
AOLM Mexico’s Association of Logistics Operators
API Active Pharmaceutical Ingredient
AWS Amazon Web Services
CANACINTRA National Chamber of the Transformation Industry
CANIFARMA National Chamber of the Pharmaceutical Industry
CBD Cannabidiol
CDC US Centers for Disease Control and Prevention
CEDIS Distribution Center
CEPI Coalition for Innovation in Epidemic Preparedness
CESSA Health Centers With Extended Services
CEYE Sterilization and Equipment Centers
CFM Mexican Pharmaceutical Council
CIMA The Chinese International Machinery Association
CINVESTAV Center for Research and Advanced Studies of the National Polytechnic Institute
CNS Central Nervous System
COFECE Federal Commission of Economic Competition
COFEPRIS Federal Commission for Protection Against Sanitary Risks
CONACYT National Council for Science and Technology
CPTPP Comprehensive and Progressive Trans-Pacific Partnership Agreement
CRO Clinical Research Organization
DCGI Drugs Controller General of India
DRP Direct From Patient
DTP Direct to Patient
ECDC European Centre for Disease Prevention and Control
EMA European Medicines Agency
EMR Electronic Medical Record
ENSANUT National Survey of Health and Nutrition
EU European Union
FDA Food and Drug Administration
FIFARMA Latin American Federation of the Pharmaceutical Industry
FPGC Protection Fund Against Catastrophic Expenditures
FTA Free-Trade Agreement
GMP Good Manufacturing Practices
HIV Human Immunodeficiency Virus
ICU Intensive Care Unit
IFPMA International Federation of Pharmaceutical Manufacturers & Associations
IMMEX The Manufacturing Industry, Maquiladora and Export Services
IMPI Mexican Institute of Industrial Property
IMSS Mexican Institute of Social Security
INCIDE Innovation and Science for Business Development
INCMNSZ The National Institute of Medical Sciences and Nutrition Salvador Zubirán
INDRE Epidemiologic Diagnostics and Reference Institute
INEGI National Institute of Statistic and Geography
INSABI Health Institute for Welfare
IP Intellectual Property
ISSSTE Institute of Safety and Social Services for Federal Workers
JCI Joint Commission International
LAASSP The Public Sector Acquisitions, Leases and Services Law
LEI Laboratorios de Especialidades Inmunológicas
M&A Merger and Acquisition
MBN Mexico Business News
NAFTA North American Free Trade Agreement
NCD Non-Communicable Disease
NOM Mexican Official Norms
NSF National Safety in Food
OECD Organization for Economic Cooperation and Development
OMC The Office for Medical Cannabis
OR Operating Room
OTC Over the Counter
PAHO Pan-American Health Organization
PAMO Pharmacy-Adjacent Medical Offices
PCR Polymerase Chain Reaction
PEMEX Petróleos Mexicanos
PHEIC Public Health Emergency of International Concern
PPP Public-Private Partnership
PROSEC Sector Promotion Programs
RGA Reinsurance Group of America
Rx Prescription Drugs
5 Apotex 14
Olivares 21
Within3 25
Biomerieux 35
QbD 45
Sánchez Devanny 49
Ergotron 59
T5DC 66
Pearson 70
CPQ 78
Eolis 85
Multiplica 89
SCT Ministry of Communications and Transportation
SEDENA Ministry of National Defense
SEDESA Ministry of Health of Mexico City
SEMAR Ministry of the Navy
SINGREM National System of Medicines and Bottle Residue Management
SME Small-Medium Enterprise
SMEO Mexican Society of Oncology
SSA Ministry of Health
TD Tetanus and Diphtheria
TMS Transportation Management System
UNAM National Autonomous University of Mexico
UNEMES Medical Specialties Units
UNICEF United Nations Children’s Fund
UNOPS The United Nations Office for Project Services
USMCA United States-MexicoCanada Agreement
VAT Value Added Tax
WHO World Health Organization
WIPO World Intellectual Property Organization
WMS Warehouse Management System
Ecaresoft 99
MexicoView 106
Google Cloud 110
RM PHARMA 120
Christus CEI 127
ACROM 130
Amazon 130
Amazon Web Services 130
AMEGI 6, 12 , 118
AMELAF 130
AMHP 15, 97
AMID 6, 20-21 , 51, 53, 60, 67, 68, 72, 130
AMIIF 6, 10, 29, 80, 130
AMIS 130
ANADIM 130
ANAFAM 130
ANAFARMEX 6, 18
ANTAD 130
AOLM 130
Apotex 6, 12, 26, 44 , 45, 118
AstraZeneca 27
Atramat 50, 57
AWS 130
AXA 111, 121, 124, 125
Bausch Health Mexico 28
Becerril, Coca & Becerril 7
Beckman Coulter 50, 63
bioMérieux 50, 61
BioNTech 31, 34, 35
Boehringer Ingelheim 28
Boston Scientific 50, 64
Bristol Myers Squibb 29, 36, 43
BUPA 113, 128
CANIFARMA 6, 11 , 42, 130
Cardinal Health 50, 58
CCE 6, 13-14 , 15, 17
CDC 130
CESSA 130
CFM 130
CHG 15, 50, 56, 68
Chiesi 26, 33
CINVESTAV 130
CMH 15, 17, 90, 95 , 97, 121, 125
COFEPRIS 7, 9, 10, 14, 23, 32, 38, 44, 67, 117, 118, 130
Colorcon 71, 74 , 80
CONACYT 130
DELL Technologies 119
DIBICO 71, 86
Doctoralia 111, 117
Dräger 50, 54
Ecaresoft 111, 122
ECDC 130
Edwards Lifesciences 50, 62
El Crisol 71, 82
EMA 130
EMR 130
Eolis 71, 73
FDA 130
FIFARMA 130
FrontierView 111, 115
FunSalud 13, 15, 17
Global Health Intelligence 93, 111, 116
GPIC 7, 23
Grupo CPQ 46 , 71, 76
Grupo Torre Médica 90, 97
HL7 113
Hospitales MAC 90, 96 , 104
IFPMA 130
IMPI 130
IMSS 6, 8 , 12, 15, 16, 18, 21, 32, 86, 130
INCMNSZ 51, 94 , 130
INDRE 130
INEFAM 27
Inosan Biopharma 43, 47
INSABI 4, 7, 8, 11, 15, 16, 20, 33, 54, 83, 84, 85, 97, 130
IQVIA 23, 29, 111, 112, 114
ISSSTE 15, 16, 32, 86, 130
IT Healthcare 53
Johnson & Johnson 28, 31
LAASSP 131
Laboratorios de Especialidades Inmunológicas 131
LEI 131
Lifesciences Consulting 19
LMP 93, 105 , 106
MAG Medical 90, 103
Mayo Clinic 90, 102
Maypo 28, 42, 71, 84 , 85
Medix 26, 40
Medtronic 50, 53, 55 , 67
Merck Group 26, 32 , 42
Ministry of Health 131
Ministry of Health of Mexico City 131
Neolpharma 26, 39
Novartis 26, 28, 30, 36, 93
OCASA 71, 79, 81
Omron 50, 51, 65 , 66
PAHO 131
PEMEX 131
Pfizer 26, 27, 28, 31, 34-35 , 43, 80
Pharmaceutical Innovation 26, 29
PharmaTycsa 83
Pierre Fabre 7, 47
Plan Seguro 121, 124, 129
Prescrypto 111, 123
Reinsurance Group of America 131
RGA 111, 121, 124, 126 , 127, 131
Roche Mexico 28
Sandoz 26, 30, 38 , 42
Sanofi 26, 28, 29, 31
Sartorios 77
SCT 131
SEDENA 131
SEDESA 131
SEMAR 131
SMEO 131
SRE 9, 11
T5DC 47, 71, 75
Takeda 26, 37
TecSalud 27
TINC CMMS 67
UNAM 13, 39, 131
UNEMES 131
UNOPS 7, 11, 20, 23, 33, 42, 47, 54, 62, 67, 84, 85, 131
USMCA 131
WHO 131
Within3 26, 37, 41
World Health Organization 131
Cover Carter Dow Photography - Roche
4 Novartis
8 IMSS
9 Ministry of Foreign Affais (SRE)
10 AMIIF
11 CANIFARMA
12 Mexico Business
13 Mexico Business
17 MHR
18 Mexico Business
19 LifeSciences Consultants
20 AMID
22 Olivares
23 Novartis
24 cassis - stock.adobe.com
29 MHR
30 Novartis
31 Sanofi
32 Merck Group
33 Mexico Business
34 Pfizer
37 Takeda
38 Sandoz
39 Grupo Neolpharma
40 Medix
41 Within3
42 MHR
43 Pfizer, Inosan Biopharma, Bristol-Myers Squibb
44 Apotex
46 Shutterstock
47 IMSS
48 Medtronic
53 MHR
54 Dräger
55 David Kern - Medtronic
56 Mexico Business
57 Atramat
58 Cardinal Health
61 bioMérieux
62 Edwards Lifesciences
63 Beckman Coulter
64 Boston Scientific
65 Marco Samaniego - Omron
67 AMID, David Kern - Medtronic, TINC CMMS
68 Medtronic
69 APOTEX
73 Eolis América Latina
74 Colorcon
75 T5DC
76 Grupo CPQ
77 Sartorius
80 Colorcon
81 OCASA
82 Mexico Business
83 Mexico Business
84 Maypo
86 DIBICO - Photographee.eu - stock.adobe. com, DIBICO - cassis - stock.adobe.com, DIBICOangellodeco - stock.adobe.com
87 APOTEX
88 IMSS
93 MHR
94 INCMNSZ
95 CMH
96 Hospitales MAC
97 Grupo Torre Médica
98 Christus Muguerza
101 Mexico Business
102 Mayo Clinic
103 Mexico Business
104 Laboratorio Médico Polanco, Christus Muguerza, Hospitales MAC
105 Laboratorio Médico Polanco
107 Grupo SOHIN
108 Siemens Healthineers
109 Happins
113 MHR
114 IQVIA
115 FrontierView
116 Global Health Intelligence
117 Doctoralia
118 MHR
119 Dell Technologies
122 Ecaresoft
123 Mexico Business
124 Plan Seguro, RGA, AXA
125 AXA
126 RGA
128 Bupa Mexico
129 Medpacom
Journalist & Industry Analyst: Miriam Bello
Editor: Alicia Arizpe
Senior Editor: Mario Di Simine
Managing Editor: Alejandro Salas
Publication Coordinator:Alejandra Yick
Content Partnership Coordinator: Alexa Villarruel
Content Partnership Coordinator: Miguel García
Graphic Designer: Tania Aguiñiga
Graphic Designer: Marcela Muñoz
Senior Graphic Designer: Mónica López
Design Director: Marcos González
Web Development: Omar Sánchez
Collaborator: Antonio Gozain
Collaborator: Andrea Villar
Collaborator: Alejandro Enríquez
Director General: Jeroen Posma
ALL RIGHTS RESERVED
© Mexico Business Publications S.A. de C.V., 2021. This annual publication contains material protected under International, US and Mexican Laws, as well as international treaties. Any unauthorized reprint or use of this material is prohibited. No part of this book may be reproduced or transmitted in any form or by any means, electronic or mechanical, including photocopying, recording or by any information storage and retrieval system without express written permission from Mexico Business Publications S.A. de C.V. Mexico Health Review is a registered trademark.
The publisher has made all reasonable efforts to provide accurate information and the information contained in this publication is derived from sources believed to be true and accurate. However, the information in this publication should not be considered to be complete or definitive and may contain inaccuracies or typographical errors. The publisher accepts no responsibility regarding the accuracy of information and use of such information is at your own risk. The publisher will not be liable to any party for any direct, indirect, special or other consequential damages arising from any use of information in this publication. The publisher provides no representations or warranties, express or implied, including any implied warranties of fitness for a particular purpose, merchantability or otherwise in relation to any information provided by the publisher in this publication.